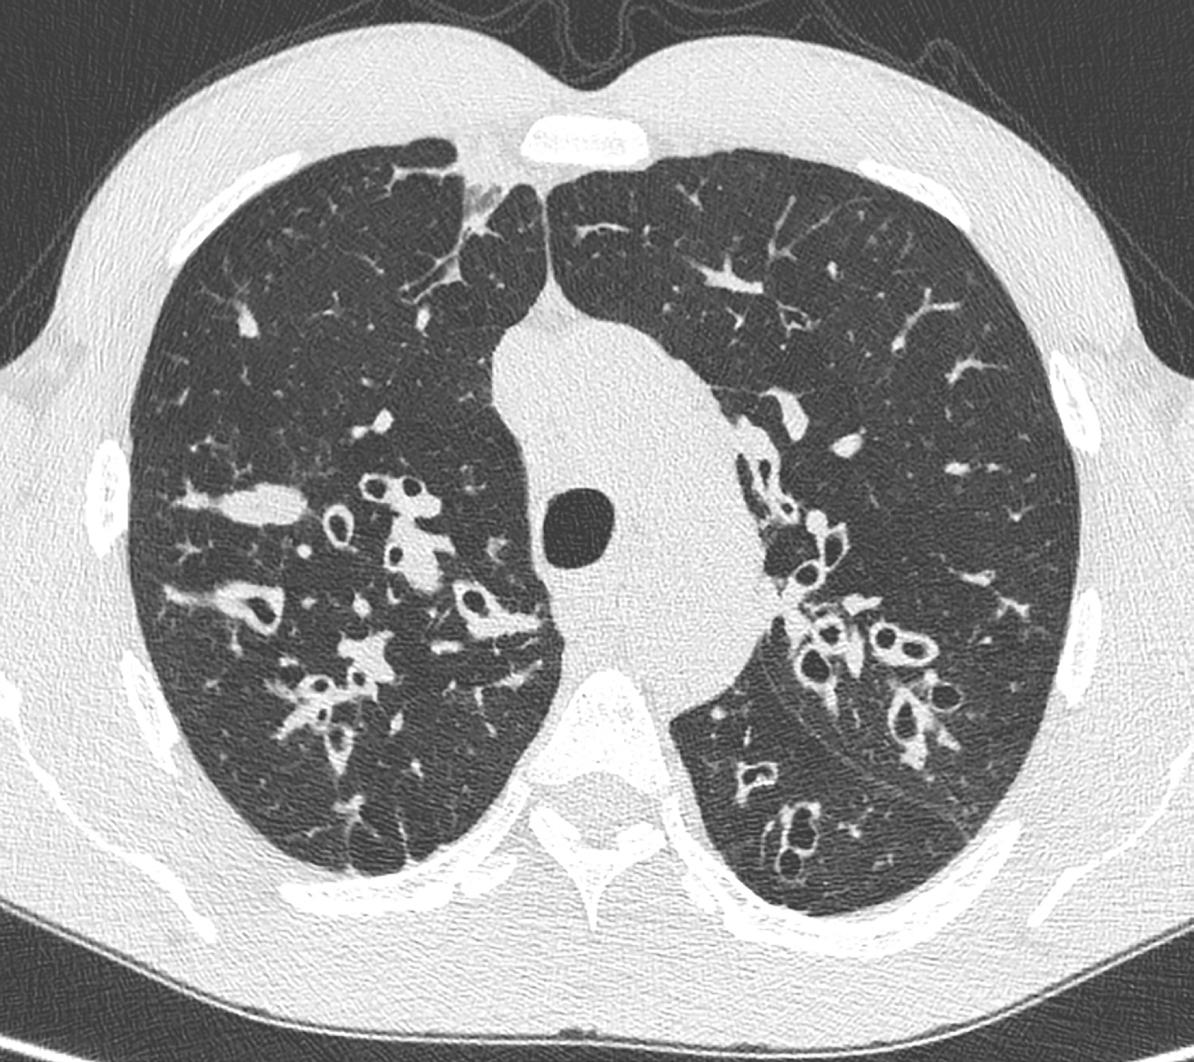

LIS Anbud fra 1/1 2023Førstevalg BTK hemmer ved KLL; i første linje for høyrisiko pasienter (del17p, mutTP53 eller del11q) eller pasienter med tilbakefall*4






LIS Anbud fra 1/1 2023Førstevalg BTK hemmer ved KLL; i første linje for høyrisiko pasienter (del17p, mutTP53 eller del11q) eller pasienter med tilbakefall*4

*For pasienter som ikke har fått signalveishemmer
** CALQUENCE er indisert for behandling av voksne med tidligere ubehandlet kronisk lymfatisk leukemi (KLL) som monoterapi eller i kombinasjon med obinutuzumab, eller som monoterapi for behandling av voksne med kronisk lymfatisk leukemi (KLL) som har fått minst én tidligere behandling.1
Alvorlige blødninger er sett. Pasienter som bruker antitrombotiske midler kan ha økt risiko for blødning og forsiktighet skal utvises ved bruk. Atrieflimmer/flutter forekom hos pasienter med hematologiske maligniteter både ved monoterapi og i kombinasjon med obinutuzumab.1
Calquence (akalabrutinib) - Viktig informasjon
Indikasjoner: Som monoterapi eller i kombinasjon med obinutuzumab, til behandling av voksne med tidligere ubehandlet kronisk lymfatisk leukemi (KLL). Som monoterapi til behandling av voksne med KLL som har fått minst 1 tidligere behandling. Dosering: Behandling skal igangsettes og følges opp av lege med erfaring i bruk av legemidler mot kreft. Voksne: Anbefalt dose er 100 mg 2 ganger daglig. Behandling bør fortsette inntil sykdomsprogresjon eller uakseptabel toksisitet. Forsiktighetsregler: Alvorlige blødninger, inkl. blødning i CNS og gastrointestinal blødning er sett. Pasienter som bruker antitrombotiske midler kan ha økt risiko for blødning og forsiktighet skal utvises ved bruk. Warfarin eller andre vitamin K-antagonister skal ikke gis samtidig med akalabrutinib. Atrieflimmer/flutter forekom hos pasienter med hematologiske maligniteter både ved monoterapi og i kombinasjon med obinutuzumab. Overvåk for symptomer på atrieflimmer og atrieflutter og foreta EKG om nødvendig. Ved høy risiko for tromboembolisk sykdom, skal nøye kontrollert behandling med antikoagulanter og andre behandlingsalternativer vurderes. Interaksjoner: Samtidig bruk av sterke CYP3A-hemmere skal unngås; kan gi til økt eksponering for akalabrutinib og dermed økt risiko for toksisitet. Dersom slike hemmere skal brukes i en kort periode (f.eks. antiinfektiva i opptil 7 dager), skal behandlingen avbrytes. Pasienten skal overvåkes nøye hvis en moderat CYP3A-hemmer brukes. Samtidig bruk av en CYP3A-induktor og sterke CYP3A4-induktorer skal unngås; vil kunne gi redusert eksponering og risiko for manglende effekt. Akalabrutinib kan øke eksponeringen for samtidig administrerte BCRP-substrater (f.eks. metotreksat) ved å hemme BCRP i tarm. Metabolitten ACP-5862 kan øke eksponeringen for samtidig administrerte MATE1-substrater (f.eks. metformin). Bivirkninger: Svært vanlige (≥1/10): Anemi, nøytropeni, trombocytopeni. Abdominalsmerter, diaré, forstoppelse, kvalme, oppkast. Fatigue. Hud: Utslett. Infeksiøse: Nasofaryngitt, pneumoni, sinusitt, urinveisinfeksjon, øvre luftveisinfeksjon. Blåmerke, blødning/hematom, kontusjon, petekkier. Artralgi, muskel-skjelettsmerter. Hodepine, svimmelhet. Ny primær malignitet. Undersøkelser: Redusert Hb, redusert absolutt nøytrofiltall, redusert trombocyttall. Vanlige (≥1/100 til <1/10): Trombocytopeni. Asteni. Atrieflimmer/-flutter. Bronkitt, herpesvirusinfeksjon. Kar: Ekkymose, epistakse, gastrointestinal blødning, intrakraniell blødning. Ikkemelanom hudkreft, sekundær primær malignitet. Pakninger og priser: 60 stk. (blister) kr 76267,60. Refusjon: H-resept: Refusjonsberettiget bruk: Der det er utarbeidet nasjonale handlingsprogrammer/nasjonal faglig retningslinje og/eller anbefalinger fra RHF/LIS spesialistgruppe skal rekvirering gjøres i tråd med disse. Vilkår: (216). Refusjon ytes kun etter resept fra sykehuslege eller avtalespesialist. Besluttet innført av Beslutningsforum: Calquence som monoterapi til behandling av voksne pasienter med kronisk lymfatisk leukemi (KLL) som har fått minst én tidligere behandling. Pasienter med manglende effekt skal ikke skifte mellom akalabrutinib og ibrutinib. Behandlingen kan tas i bruk i forbindelse med oppstart av neste onkologianbud. Beslutning fra Beslutningsforum avventes for øvrige indikasjoner Reseptgruppe: C. Se SPC (11.11.2021) for mer informasjon.
Referanser:
1. Calquence SPC. section 4.1, 4.4, 5.1 (11.11.2021)
2. Byrd JC, Harrington B, O’Brien S et al. Acalabrutinib (ACP-196) in Relapsed Chronic Lymphocytic Leukemia N Engl J Med 2016;374:323-32.
3. https://nyemetoder.no/Documents/Beslutninger/Beslutningsforum%2021112022_Protokoll.pdf
4. https://sykehusinnkjop.no/seksjon/avtaler-legemidler/Documents/Onkologi/Onkologiske-og-kolonistimulerende-legemidler.pdf
Andre generasjons BTKi mot tidligere ubehandlet eller ved residiverende/refraktær KLL**1 ,2
Styret i Norsk indremedisinsk forening:



Trond Vartdal Leder

Knut Lundin Nestleder
Maria Seferowicz Styremedlem
Rune Eilertsen Styremedlem
Anita Suntharalingam Styremedlem

OUS Aker stehewi@online.no
T: 913 72 199
Fagredaktører:
Bernt Aarli (Lungemedisin) Haukeland universitetssykehus
Eystein Husebye (Endokrinologi) Haukeland universitetssykehus
Marius Myrstad (Geriatri)
Sykehuset Viken, Bærum sykehus
Indremedisineren er et fagtidsskrift rettet mot norske leger som arbeider innen fagomådet indremedisin, med dets ulike retninger. Indremedisineren sendes ut til alle medlemmer av Norsk indremedisinsk forening (Nif), som for tiden er ca 3 400, samt til andre med interesse for faget. Indremedisineren vil presentere

Maya Bass Leder Høstmøtekomiteen
Bjørn Jørgensen



Leder Spesialitetskomiteen
Hamza Nahoui Leder NYI
Stephen Hewitt Redaktør Indremedisineren

Gunnar Einvik (Lungemedisin) Akershus universitetssykehus/NTNU



Trine Finnes (Endokrinologi) Sykehuset Innlandet/OUS







Guri Hagberg (Geriatri)






OUS Ullevål
relevant faglig og fagpolitisk stoff fra norske miljøer, samt noe internasjonalt rettet stoff av allmen interesse. Vi ønsker å legge til rette for at terskel og takhøyde gir rom for en allment engasjert indremedisiner å ytre seg.
Reproduksjon av materiale fra Indremedisineren må skje etter tillatelse fra redaksjon og forfatter.
Annonsepriser 2023
22.500,Omslagsside 19.500,Helside 18.000,1/2 side 12.500,-
Årsavtale Med fire innrykk oppnås min. 20% rabatt.
Annonseformat
Bredde x Høyde 1/1 side 210 mm x 297 mm + 5 mm
1/2 side liggende 210 mm x 148,5 mm + 5 mm
1/2 side stående 105 mm x 297 mm + 5 mm
Bakside 210 mm x 230 mm + 5 mm
Annonsemateriell
Høyoppløste PDF-filer, der fonter og høyoppløste bilder er inkludert.
Layout, produksjon og annonsesalg
Apriil Media AS E-post: marianne.madsen@apriil.no www.apriil.no
Disclaimer
• Informasjon, meninger og synspunkter som utgis i Indremedisineren tilhører forfatterne, og ikke nødvendigvis Norsk indremedisinsk forening eller redaksjonen.
• Publisering av artikler, annonser eller annen informasjon, betyr ikke nødvendigvis støtte eller aksept for disse.
• Redaksjonen og utgiver anstrenger seg for ikke å publisere unøyaktige eller misvisende data, men forfatterne må selv ta ansvar for data,
uttalelser og meninger som blir utgitt på deres vegne.
• Redaksjonenen og utgiver gjør sitt beste for å sikre at legemiddeldoser og andre kvantiteter presenteres nøyaktig, men vi anbefaler leserne å bruke legemidler i samsvar med Felleskatalogen/Norsk legemiddelhåndbok.
• Indremedisineren og/eller utgiver kan ikke holdes ansvarlig for evt. feil eller konsekvenser som oppstår som følge av bruk av informasjon i tidsskriftet.
Om du er ferdig spesialist, eller på vei til å bli det, søker vi nå flere kollegaer som kan bidra til å fremme faget vårt i årene som kommer.
Oppgavene er varierte, så her håper vi alle kan finne noe de liker.
Hvis du, eller noen du kjenner,
– vil være med å organisere høstmøtet
– kan delta i oppbyggingen av nye nettsider og/eller opprette SoMe-profil for foreningen
– ønsker å jobbe for den faglige utviklingen av spesialiteten nasjonalt og bidra til internasjonalt samarbeid
– vil bidra til tidsskriftet vårt Indremedisineren
– er nysgjerrig på et styreverv

Ta kontakt med oss via e-post; vartdaltrond@gmail.com
maria.seferowicz@hotmail.com
Da har dere fått det årets første nummer av Indremedisineren i hendene. Som vanlig inneholder det artikler som spenner over store deler av det fascinerende fagfeltet indremedisin. Jeg er sikker på at leserne vil finne noe av interesse også i dette nummeret, og som kanskje endatil vil heve kompetansen i jobben som indremedisiner. God lesing!
Helsepersonell. Helsepersonellkommisjonen, ved Gunnar Bovim, leverte sin rapport 2.februar i år. Og med rapporten «NOU 2023;4 – Tid for handling – Personellet i en bærekraftig helse- og omsorgstjeneste» er den virkelig store prioriteringsdebatten satt i gang. For oss som har arbeidet i helse og/eller omsorg i noen tiår allerede, har vel tanken om at «de gode tidene er over» streifet oss. Spriket mellom hva som er mulig å tilby av tjenester – og hva som faktisk går an å tilby, blir stadig større. Det har en stund vært snakk om kostnader og prioriteringer i samfunnet. Og Helsepersonellkommisjonen har nå satt fokus på diskusjonen rundt personellet – antall hoder og antall hender. En fortsatt økning av aktivitet i helse og omsorg må gå på bekostning av forsvar, utdanning, det grønne skiftet og flere andre viktige satsinger. Det hjelper altså ikke å bevilge mer penger, for de aktuelle menneskene finnes ikke,
eller skal arbeide i andre viktige områder. Så langt har det vært en god og saklig debatt, og det virker som prinsippene som løftes frem har blitt godt mottatt.
Høring. NOU’en er nå ute på høring, og det er viktig at vi som helsepersonell kommer med sine innspill nå. Enten kan man gjøre det gjennom arbeidsgiver, gjennom foreninger (inkludert Legeforeningen) eller som enkeltpersoner. De som har gode innspill må kjenne sin besøkelsestid nå. For å bli med på Legeforeningens felles høringssvar, er det frist for innspill 27.mars – sjekk www.legeforeningen.no. Men ta gjerne et personlig initiativ og legg inn høringssvaret direkte på www. regjeringen.no
Generalister. For å gjenta meg selv fra forrige leder: «Når mangelen på hoder og hender i helsevesenet blir stadig større, må helsevesenet i større grad ha generalister.» Generelle indremedisinere (og generelle kirurger) er en god løsning for å øke pasientsikkerheten i norske sykehus. For tiden er det er få som utdannes i de to hovedspesialitetene indremedisin og generell kirurgi. I rapportens kapittel 8.5.4., konkluderer kommisjonen slik: «Helsepersonellkommisjonen anbefaler mer satsing på generell medisinsk kompetanse
i de regionale helseforetakene og i helseforetakene. Det kan blant annet gjøres ved å: – Prioritere utdanningsstillinger og overlegestillinger i generelle spesialiteter.
– Bidra til større fleksibilitet i utdannings løpene med smidigere overganger mellom små og mellomstore sykehus.
– Legge bedre til rette for parallelle spesialiseringsløp.»
Her er det altså mye å diskutere for de som skal eie og drifte sykehusene, men også for oss som er opptatt av å bevare brede og solide fagmiljøer. Som evner å se helheten og mangfoldet i pasientene og deres sykdommer, både de indremedisinske, de kirurgiske – og mange andre.
Kjør debatt!
Hilsen Trond Vartdal

19. og 20 oktober, Hotell Bristol, Oslo







Årets tema:


«Førstehjelp for medisinske bakvakter (og andre vaktgående leger)»
Hold av dagene og meld dere på.
Programmet og praktiske detaljer vil publiseres

i neste nummer av Indremedisineren.
Hilsen høstmøtekomiteen



Vi takker alle våre bidragsytere i dette nummer. Det er fagartikler fra mange av fagområdene med mye interessant stoff.
Ragnhild Munthe-Kaas og medarbeidere gir først en grundig oversikt over dagens håndtering av subaraknoidalblødning (SAH) i Norge. Bl.a. fremheves betydningen av rask diagnostisk CT, stabilisering på lokalsykehus og henvisning til sykehus med nevrokirurgisk kompetanse. Artikkelen omtaler ulike metoder for aneurismesikring, påfølgende håndtering og tiltak for å forebygge komplikasjoner. Det tas også til orde for å inkludere aneurismal SAH i Norsk hjerneslagregister.

Binyrebarksvikt er en potensielt livstruende sykdom. Sandra Dis Steintorsdottir og Eystein Sverre Husebye redegjør for dets ulike former, med primær, sekundær samt tertiær type. Standard substitusjonsbehandling har vært kortison, men andre alternativer omtales som har kommet mer på banen i senere år, ikke minst depotpreparater. Også mineralkortikoider er relevante, særlig ved primær binyrebarksvikt.
Akuttoverlege Melita Kosjerina skriver i sin artikkel om BRASH syndrom, en ny medisinsk diagnose. Syndromet karakteriseres ved refraktær bradykardi evt med AV-knute blokade, hyperkalemi, og evt nyresvikt og/ eller sjokk. Tilstanden ses oftest hos eldre, og er ofte et resultat av synergistiske medikamenteffekter.
Artikkel gir en oversiktlig fremstilling. Å gjenkjenne dette syndromet og velge riktig behandling vil kunne bidra til raskere bedring av den kliniske tilstanden og til å øke pasientens overlevelse.
Kathrine F. Vandraas redegjør for tre akutte onkologiske tilstander som vaktgående leger bør ha kjennskap til, da prognosen avhenger av rask diagnostikk og behandling. Disse er relativt hyppig forekommende tilstander: Malign medullakompresjon, vena cava superior syndrom og immunrelatert toksisitet, men listen over mulige onkologiske komplikasjoner er mer omfattende. Steroidbehandling er en viktig fellesnevner i akuttfasen, men det anbefales å konferere med onkolog.
Bernt B. Aarli og Christian Lawley tar for seg cystisk fibrose. Sykdommen er alvorlig og medfører forventet levealder på ca 50 år. Spesielt utsatt er lunger og pankreas. Artikkelen går gjennom patogenese og behandling. Behandlingen har frem til det siste vært basert på å lindre symptomer. Nye behandlingsmuligheter kan korrigere den bakenforliggende årsa, der et kasus illustrerer en markant bedring i flere lungefunksjonsparametre.
Det har vært økende fokus på vedvarende symptomer etter gjennomgått Covid-19 infeksjon – såkalt «long Covid». Charlotte Bjørg Ingul gjennomgår i sin fagartikkel patofysiologi ved postakutt Covid-19, samt symptomer,
komplikasjoner og diagnostiske funn i lunger og hjerte. Hun presenterer en norsk multisenterstudie (PROLUN), med ekkokardiografi, 24-timers EKG og kardiopulmonal belastnings-test (CPET) etter Covid-19. Vi takker artikkelforfatter og Hjerteforum for anledning til å publisere artikkelen på ny også i Indremedisineren!
Medikamentell behandling av Crohns sykdom har endret seg mye de senere år. Vendel Kristensen og medforfattere gir i sin fagartikkel en god oversikt over moderne behandling, der flere nye legemidler har kommet til i form av tiopuriner, metotreksat, TNF-alfa- hemmere og andre legemidler som ustekinumab og vedolizumab. Artikkelen gir en oversikt over disse, samt strategier for behandling og oppfølging. Vi takker artikkelforfatterne og NGFnytt for å publisere artikkelen også for Indremedisinerens lesere.
Elisabeth Joy Rivertz og medforfattere omtaler hypertensjon i svangerskapet. Med mindre man har kjent høyt blodtrykk fra før svangerskapet, forblir det ofte diagnostisert i siste trimester da blodtrykket normalt stiger. Forfatterne går gjennom risikofaktorer og relevante kliniske karakteristika. Preeklampsi knyttes til placentadysfunksjon. Og medikamentell behandling gis god omtale.
Vi viser også til stoff av mer foreningsmessig karakter i bakre del.
Med vennlig hilsen
Bruk av Tresiba® under graviditet
Bruken av Tresiba® hos gravide kvinner med diabetes type 1 har blitt undersøkt i en intervensjonsstudie (EXPECT-studien).2 Data fra kliniske studier og etter markedsføring (>400 graviditeter) indikerer ikke potensial for misdannelser eller føto/neonataltoksisitet.3
Insulinbehovet minker vanligvis i første trimester og stiger deretter i andre og tredje trimester. Etter fødselen går insulinbehovet vanligvis raskt tilbake til det samme nivået som før graviditeten. Nøye overvåking av glukosekontroll og individuell justering av insulindosen anbefales.
Behandling med Tresiba® kan nå vurderes under graviditet2,3
Indikasjon4
Behandling av diabetes mellitus hos voksne, ungdom og barn fra 1 år.
Hypoglykemi er en svært vanlig bivirkning (≥ 1/10) og kan forekomme dersom insulindosen er for høy i forhold til insulinbehovet.
Hyperglykemi Bruk av utilstrekkelige doser eller avbrytelse av behandlingen, særlig hos pasienter med behov for insulin, kan føre til hyperglykemi og diabetisk ketoacidose.
Lipodystrofi (inkludert lipohypertrofi, lipoatrofi) og kutan amyloidose kan forekomme på injeksjonsstedet og forsinke lokal insulinabsorpsjon. Kontinuerlig rotering av injeksjonssted innen et gitt injeksjonsområde kan bidra til å redusere eller forebygge disse bivirkningene.
Reaksjoner på injeksjonsstedet kan forekomme. Disse er vanligvis milde og forbigående, og forsvinner normalt ved fortsatt behandling.
Annen samtidig sykdom, især infeksjoner og febertilstander, øker vanligvis pasientens insulinbehov.
Dosering1
Alder
Kan benyttes uten dosejustering Anbefales ikke
Voksne, ungdom og barn fra 1 år Eldre (≥65 år): Måling av glukose må intensiveres hos eldre, og insulindosen justeres individuelt
Nyrefunksjon Kan brukes
Måling av glukose må intensiveres ved nedsatt nyrefunksjon, og insulindosen justeres individuelt
Leverfunksjon Kan brukes Måling av glukose må intensiveres ved nedsatt leverfunksjon, og insulindosen justeres individuelt
Graviditet
Kan brukes Behandling med Tresiba® kan vurderes under graviditet hvis det er klinisk nødvendig
Barn under 1 år Ingen klinisk erfaring
Tresiba® administreres subkutant én gang daglig i låret, overarmen eller abdominalveggen når som helst i løpet av dagen, fortrinnsvis på samme tidspunkt hver dag. Det skal alltid være minst 8 timer mellom injeksjonene.

Tresiba® kan forskrives på blåresept ved diabetes type 1 og diabetes type 2 6-8

Insulinanalog, langtidsvirkende. ATC-nr.: A10A E06
Refusjonsberettiget bruk: Behandling av diabetes mellitus
Refusjonskode:
ICPC Vilkår nr
T89 Diabetes type 1 180, 181
T90 Diabetes type 2 244
ICD Vilkår nr
E10 Diabetes mellitus type 1 180, 181
E11 Diabetes mellitus type 2 244
Pakninger og priser:
Vilkår:
180 Refusjon ytes kun til pasienter som ikke oppnår behandlingsmålene til tross for optimal behandling med middels langtidsvirkende NPH-insulin på grunn av: - hyppige eller alvorlige nattlige følinger som skyldes insulinbruken - store blodsukkersvingninger som ikke gjør det mulig å oppnå akseptabel blodsukkerkontroll
181 Behandling skal kun startes av spesialist i indremedisin, barnesykdommer eller ved sykehusavdeling med tilsvarende spesialitet
244 Refusjon ytes kun til pasienter som til tross for optimal behandling med to daglige doser middels langtidsvirkende NPH-insulin har vedvarende utfordringer med hypoglykemier
Injeksjonsvæske, oppløsning i sylinderampulle: 100 enheter/ml: 5 × 3 ml (Penfill sylinderamp.) kr 618,00. Injeksjonsvæske, oppløsning i ferdigfylt penn: 100 enheter/ml: 5 × 3 ml (FlexTouch ferdigfylt penn) kr 750,70. 200 enheter/ml: 3 × 3 ml (FlexTouch ferdigfylt penn) kr 732,50. (Pris per mars 2022)
For ytterligere informasjon se fullstendig preparatomtale eller www.felleskatalogen.no
Referanser:
100 enheter/ml: Kan gi opptil 80 enheter per injeksjon (1-80 enheter)
200 enheter/ml: Kan gi opptil 160 enheter per injeksjon (2-160 enheter)
Aneurismal subaraknoidalblødning er en potensielt livstruende tilstand, som rammer omkring 250 mennesker i Norge årlig. Tilstanden debuterer som regel med hyperakutt hodepine, ofte med følgesymptomer som nedsatt bevissthet og nakkesmerter. Ikke sjelden er akuttmottak, med indremedisiner i front, disse pasientenes første kontakt. Slike pasienter må umiddelbart utredes med CT caput da påvisning av et aneurisme med påfølgende sikring for å hindre reblødning kan være livreddende.
Ragnhild Munthe-Kaas, PhD, spesialist indremedisin/geriatri, medisinsk avdeling, Vestre Viken, Kongsberg sykehus.

Guri Hagberg, PhD, spesialist indremedisin/geriatri, Seksjon for hjerneslag, Nevroklinikken, Oslo Universitetssykehus, Ullevål.


Pål Andrè
Bakgrunn
Subaraknoidalblødning (SAH) er en livstruende type hjerneslag forårsaket av en blødning i subaraknoidalrommet. I 80 % av tilfellene er aneurismeruptur årsak til SAH (1) (Figur 1). Et aneurisme er en ervervet utposning på arterien, typisk i ett delingspunkt, og 85 % av aneurismene sitter i fremre sirkulasjonen i hjernen. Aneurismer forekommer hos 2-3% i befolkningen (1). Årsak til SAH hos de resterende 20 % kan være blødning fra en arteriovenøs malformasjon, durale fistler, vaskulitter etc., men ofte finner man ikke sikker etiologisk årsak. Hos disse er imidlertid den videre prognosen og forløpet som regel godartet, uten utvikling av hydrocephalus eller risiko for vasospasmer.
De fleste hjerneaneurismer sprekker aldri, men hvis de gjør det, vil de forårsake blødninger i subaraknoidalrommet, altså en aneurismal SAH
(aSAH). I enkelte tilfeller kan også rupturstedet peke rett i parenkym og gi opphav til intracerebrale blødninger (ICH). aSAH er forbundet med en betydelig sykelighet og dødelighet. SAH utgjør 2-7 % av alle hjerneslag, gjennomsnittsalder er 62 år (lavere enn både spontane ICH og ischemiske hjerneslag) og av de som rammes er 2/3 kvinner (2).
Insidens av aSAH er 9/100 000 pr. år i industrielle land, og det beskrives at 400 personer rammes av dette årlig i Norge. Antallet er imidlertid redusert betydelig de siste årene og man spekulerer på om røykelov og bedret hypertensjonsbehandling er bakenforliggende årsaker (2-4). Sannsynligvis er det reelle insidens tallet rundt 250 pr. år i Norge (ekstrapolert fra forekomst ved OUS).
Dødeligheten er også redusert. Dette tilskrives blant annet raskere diagnose, tidligere sikring
av aneurismet (som forhindrer senere reblødning) og endovaskulære behandlingsstrategier. Til tross for disse fremskrittene forblir dødelighet og sykelighet høy (5, 6); 15 % dør før de når sykehus, 45 % dør innen 30 dager, og om lag 50 % kommer ikke tilbake til funksjonsnivået de hadde før blødningen (4, 6).
Risikofaktorer for aSAH kan inndeles i modifiserbare og ikke-modifiserbare risikofaktorer (7) (Tabell 1).
Kvinnelig kjønn og japansk- eller finsk nasjonalitet er sikre ikke-modifiserbare risikofaktorer. Modifiserbare risikofaktorer som hypertensjon og røyking har vist sterk assosiasjon til SAH. Alkohol og narkotiske stoffer som kokain, medfører også økt risiko for SAH.
Kliniske retningslinjer SAH Internasjonale retningslinjer for håndteringen av aSAH foreligger,
Tabell 1: modifiserbare og ikke modifiserbare risikofaktorer for aSAH Ikke modifiserbare risikofaktorer Modifiserbare risikofaktorer
Kvinne Hypertensjon
Japansk / finsk nasjonalitet.

Sannsynligvis Afroamerikansk / spansk etnisitet
Polycystisk nyresykdom (autosomal dominant)
Genetiske markører som Ehlers–Danlos syndrom type 4 og G572C polymorfisme av interleukin-6 (IL-6) genet
Minst en 1.grads slektning med intrakranielt aneurisme
Røyking
Alkoholoverforbruk
Sannsynligvis narkotiske stoffer, som Kokain
Bilde 1: Hyperdensiteter (blod) i basale cisterner og utspente temporalhorn er kjennetegn ved CT-scanning av en SAH med hydrocefalus.

Bilde 2: MCA (a. cerebri media) bifurkasjonsaneurisme (sitter i delingen av et kar). Her 3-dimensjonalt fremstilt fra CTA (CT-angiografi) som gir god oversikt over hvor inngående og avgående grener fra aneurismet (M1 = hovedstamme av a. cerebri media, M2 = første større forgreining av MCA, A1 = hovedstamme av a. cerebri anterior)


men ikke av nyere dato. American Heart Association (AHA) og American Stroke Association (ASA) sine retningslinjer for aSAH er fra 2012 (6), mens European Stroke Organization (ESO) har retningslinjer fra 2013 (8).
Hyperakuttfase tidspunktet fra aneurismet sprekker til sikring Den klassiske beskrivelsen ved debut er den hyperakutte, kraftige hodepinen. Hyperakutt hodepine er definert som en alvorlig hodepine med brå debut til maksimal intensitet på mindre enn 1 minutt. Hodepinen beskrives typisk som «mitt livs verste hodepine», og med debut som «lyn fra klar himmel». Minst halvparten av alle SAH debuterer med hyperakutt hodepine, og SAH finnes hos 25 % av pasienter med denne akutte hodepinen (1, 9). Hodepinen beskrives som annerledes fra tidligere
hodepine, ofte ledsaget av nedsatt bevissthet, svimmelhet, oppkast, nakkesmerter og lysskyhet. Hodepine med slike røde flagg fortjener ytterligere umiddelbar utredning (10).
CT caput er den raskest tilgjengelige og beste initiale diagnostiske test ved spørsmål om aSAH. Sensitiviteten til CT forblir svært høy for å avdekke blod i subaraknoidalrommet de første 3 døgn etter iktus (11) (Bilde 1).
CT angiografi av intracerebrale kar er neste trinn for å stadfeste om det foreligger et eller flere aneurismer (Bilde 2); ordinær CT-angio er tilstrekkelig i de fleste tilfeller, spesielt på et lokalsykehus. Hos pasienter med normale funn på CT undersøkelser, men med mistenkt SAH, anbefales fortsatt lumbalpunksjon. Siden det kan være vanskelig å skille mellom
SAH og traumatisk punksjonsblødning bør spinalpunksjon avventes i 12 timer. Man kan da skille mellom innstikkblødning og SAH fordi nedbrytning av hemoglobin til bilirubin tar tid og bilirubin ikke vil være tilstede ved en fersk innstikkblødning (11, 12).
Pasienter på lokalsykehus med påvist SAH trenger rask transport til et sykehus med nevrokirurgisk behandlingstilbud, siden dette er assosiert med lavere dødelighet, forbedret resultat og en høyere prosentandel av pasientene som etterhvert skrives ut til hjemmet (11, 13, 14). Imidlertid er det viktig å stabilisere pasienten respiratorisk og sirkulatorisk på lokalsykehuset før transport samt sørge for adekvat smertelindring. Ofte gis også tranexamsyre (TXA) før transport.
Hunt and Hess
HH Grad I Pasienten er våken, klar og orientert, har lett hodepine og er lett nakkestiv.
HH Grad II Pasienten er våken, klar og orientert, har kraftig hodepine, er middels til kraftig nakkestiv, kvalm, kaster opp og har evt. en enkelt hjernenervelammelse.
HH Grad III Pasienten er desorientert for tid, sted og/eller situasjon og/eller har lett redusert bevissthet evt. moderat lammelse.
HH Grad IV Pasienten har betydelig redusert bevissthet og/eller betydelig lammelse.
HH Grad V Pasienten er dypt bevisstløs.
Etter at SAH er påvist er det overordnede målet å forhindre reblødning fra aneurismet, hindre/ redusere sekundære hjerneskader, samt hindre komplikasjoner i andre organsystemer.
Hunt and Hess skalaen (Tabell 2) beskriver den kliniske alvorlighetsgraden av en SAH og brukes som en prediktor for overlevelse (11, 15), og kan være greit å kjenne til.
På gruppenivå er det økt overlevelse, jo lavere grad av HH. HH-grad, hjernestammereflekser, alder, CT bilder og funksjonsnivå er variabler som vurderes med henblikk på hvorvidt det er fornuftig å tilby sikring av aneurismet og videre nevrointensiv behandling. Såfremt ikke pasienten har bilateralt dilaterte pupiller, omfattende parenkymskade på CT eller dårlig premorbid funksjonsnivå, vil vanligvis aneurismesikring være aktuelt.
På nevrokirurgisk avdeling utføres digital subtraksjonsangiografi (DSA) dersom årsak til blødningen ikke er påvist ved CTA, eller hvis CTA gir mistanke om arteriovenøs malformasjon (AVM) eller kranial dural arteriovenøs fistel (dAVF). DSA er en invasiv teknikk som betraktes som gull-standard for å påvise patologi i cerebrale kar på grunn av billedoppløsning og mulighet til å fremstille dynamikk i blodgjennomstrømning. DSA i seg selv har noe risiko, inkludert nevrologiske utfall med forekomst opptil 1.4 % (16).
Antifibrinolytisk terapi I de siste tiårene har antifibrinolytisk terapi før klipsing eller coiling av aneurisme vært mye brukt, men sikkerheten og effekten er fortsatt kontroversiell. TXA (1 g hver 6. time) er i retningslinjer både nasjonalt og internasjonalt anbefalt frem til aneurismesikring for å forbygge reblødning. Nye studier trekker effekt på reblødning sterkt i tvil (17). Hypertensjon gir også en risiko for reblødning, og retningslinjene anbefaler tett blodtrykksovervåking før aneurismesikring, med et systolisk blodtrykk under 160. Det er ingen RCT-er tilgjengelig for å bekrefte dette (1, 11).
Sikring av aneurismet Opptil 20 % av pasientene med aSAH rammes av reblødning innen 24 timer, og en slik reblødning har en dødelighet på mellom 20-60 %. Rask overflytning til nevrokirurgisk avdeling og forebygging av reblødning ved å sikre aneurismet er derfor viktig i behandlingen av SAH (18).
På generell basis anbefaler man at aneurismer sikres så snart som mulig. Åpen kirurgi med klipsing (Figur 2) eller endovaskulære metoder, som coiling eller stenting, er de to metodene som hyppigst er i bruk. Valg av metode for aneurismesikring avhenger av mange faktorer; pasientens generelle tilstand, de geometriske egenskapene til aneurismet, tilstedeværelsen av et assosiert hematom og masseeffekt, og den generelle mikrokirurgiske versus endovaskulære ekspertisen
ved behandlingssenteret. Valg av sikringsmetode bør gjøres etter en tverrfaglig diskusjon mellom nevrointervensjonist og nevrokirurg (18). Basert blant annet på ISAT (International Subarachnoid Aneurysm Trial) (19), anbefales coiling av rupturerte aneurismer som er tilgjengelige for denne teknikken hvis klipsligatur og coiling ellers fremstår likeverdige.

Håndtering etter aneurismesikring Fokus i fasen etter aneurismesikring, er å forebygge sekundær hjerneskade, ved å optimalisere oksygennivå samt opprettholde cerebralt perfusjonstrykk over 70 mmHg. Det er indikasjoner på at betennelse bidrar til dårlig resultat for pasientene. Ulike inflammatoriske mediatorer, inkludert interleukin 6, CRP, TNF- α og komplement komponenter, er assosiert med vasospasme og forsinket cerebral hjerneskade.
Patofysiologi ved vasospasme og forsinket cerebral hjerneskade I det aneurismet brister og blodet strømmer inn i subaraknoidalrommet, øker det intrakranielle trykket, med nedsatt perfusjon til følge. Dette fører til tidlig hjerneskade, som inkluderer blant annet cerebralt ødem, betennelse og «spreading depolarization». Det spekuleres i om disse faktorene kan utløse vasospasme, og om radiologisk vasospasme utløser forsinket cerebral iskemi (18).
Vasospasme betegner den angiografiske forsnevringen av kar, eller den økte hastigheten man kan måle over forsnevringen med Doppler.
Hvis pasienten forverres, uten annen forklaring, har man antatt at det er sekundært til redusert blodtilførsel. De siste 15-20 årene har man oppdaget at mange pasienter også forverres i samme tidsrom uten slike vasospasmer. Dette fenomenet betegnes som forsinket cerebral iskemi (delayed cerebral ischemia (DCI)). Den tilgrunnleggende patofysiologien for både vasospasmer og DCI har vært gjenstand for mye forskning, men man har fortsatt kun en rudimentær forståelse.
DCI er et klinisk syndrom, som defineres som fokalt nevrologisk utfall, og/eller fall i Glasgow Coma Scale (GCS) på ≥2, med varighet i over en time og som ikke kan forklares av annen årsak. Man overvåker dette med gjentatt nevrologisk vurdering hos våkne pasienter (11, 18, 20). Hvis pasienten fremviser tegn på DCI gjøres ofte CTA og/ eller transkraniell doppler. I enkelte tilfeller går man også videre med CT perfusjon (CTP). Hvis man påviser uttalte symptomatiske spasmer og eventuelt redusert perfusjon på CTP, går man ofte videre til konvensjonell angiografi og intrarteriell administrering av nimodipin. I fravær av sikre symptomer øker man cerebralt perfusjonstrykk (CPP) og intensiverer overvåking.

En rekke medikamenter er forsøkt både i klinisk og eksperimentell setting som profylakse mot vasospasme/DCI. Kun kalsium kanal blokker, Nimodipin, har vist sikker og reproduserbar effekt på
funksjonelt utkomme (7). Imidlertid reduseres ikke vasospasmer. Man anbefaler Nimotop i 21 dager etter iktus. Interessant nok har multiple undersøkelser av en endothelin antagonist (Clazosentan – Conscious studiene) vist at Clazosentan reduserer forekomsten av radiologisk vasospasme sammenlignet med Nimodipin, men at resultatet var identisk (1, 6, 7, 21, 22).
Andre komplikasjoner
Hydrocephalus er rapportert å oppstå akutt hos 50 % av pasientene med aSAH. Drenasje er ofte nødvendig; som regel også intrakraniell trykkovervåking. Det er imidlertid usikkerhet her: Det er en viss bekymring for den teoretiske risikoen for reblødning når aneurismet ennå ikke er behandlet (på grunn av økningen i transmuralt trykk som oppstår ved drenasje) (18).
Kramper er også en tidlig komplikasjon som kan oppstå. De fleste forekommer i løpet av de første 24 timene (opptil 26 % ved iktus, 2-8 % senere i forløpet), og kan være et symptom på reblødning. Kramper er uheldig, fordi hjernemetabolismen øker med dertil hørende dilatasjon av arterioler som igjen medfører økt intrakranielt trykk. Dette kan igjen påvirke hjernens perfusjonstrykk og medføre en iskemisk situasjon hvis hjernens metabolske krav ikke understøttes adekvat (18).
Kardielle komplikasjoner ses hos 50 % av SAH pasientene. Risikoen øker med alvorlighetsgraden av
aSAH. Disse komplikasjonene inkluderer EKG forandringer, frigjøring av kardielle biomarkører som troponin og NTproBNP, samt utvikling av stressindusert hjertesvikt, Takotsubo. Komplikasjonene er assosiert med et komplekst klinisk forløp og økt risiko for nevrologiske komplikasjoner, herunder forsinket cerebral iskemi (DCI). Disse pasientene har økt risiko for funksjonssvikt både på kort og lang sikt. Hjertekomplikasjoner etter SAH er ikke forårsaket av okklusiv koronarsykdom, men er mest sannsynlig et resultat av den omfattende katekolaminfrigjøringen i forbindelse med blødningen (23, 24). Rask deteksjon og håndtering av disse komplikasjonene er essensielt for å begrense konsekvensene ved aSAH, herunder hypoksi og hypotensjon, på den allerede sårbare hjernen.
Oppsummering av behandling
De eneste behandlingene basert på høy grad av evidens er endovaskulær coiling fremfor klipsligatur som sikringsmodalitet såfremt begge modaliteter er aktuelle, og bruk av Nimodipin som reduserer forekomst av infarkter og bedrer utkomme for pasientene.
Etter utskrivelse fra sykehus; hvordan er den videre håndteringen av aSAH og vet vi noe om kvalitet på behandlingen?
Overvåking av behandlingskvalitet ved hjelp av registre og regelmessige revisjoner har blitt sterkt anbefalt i europeiske retningslinjer av Verdens helseorganisasjon og European Stroke Council (25). Det er
Referanser
ikke iverksatt slike tiltak for å vurdere behandlingen av pasienter med aSAH i Norge. Norsk hjerneslagregister er det nasjonale kvalitetsregisteret for behandling av hjerneslag i Norge. Gjennom dette registeret er det økt fokus på kvalitet, lik omsorg for alle og forbedring av behandlingen. aSAH er ikke inkludert i registeret per i dag, men planlegges implementert.
På grunn av denne manglende oversikten over håndteringen av aSAH både i Norge, og i flere andre land, er det bekymring fra de involverte disiplinene for at disse pasientene kanskje ikke får optimal og likeverdig behandling. I Danmark ble SAH inkludert i Dansk Apopleksi register i 2018.
Bemerkelsesverdig nok overlever mange aSAH-pasienter med få fokale nevrologiske utfall. Selv pasienter med god fysisk funksjon rapporterer betydelig funksjonssvikt og problemer med tretthet, så vel som kognitive og emosjonelle problemer. Studier har vist at 50 % ikke kommer tilbake til funksjonsnivået de hadde før aSAH og 1 av 4 vil være avhengig av andre i hverdagen. Samtidig vil 30-50 % ha forsinket eller begrenset evne til å gå tilbake til tidligere jobb og 40-70 % vil få en kognitiv svikt i etterkant av aSAH. Så mange som 50-70% rapporterer fatigue i
1. Tawk RG, Hasan TF, D’Souza CE, Peel JB, Freeman WD. Diagnosis and Treatment of Unruptured Intracranial Aneurysms and Aneurysmal Subarachnoid Hemorrhage. Mayo Clin Proc. 2021;96(7):1970-2000.
2. Global, regional, and national burden of stroke and its risk factors, 1990-2019: a systematic analysis for the Global Burden of Disease Study 2019. Lancet Neurol. 2021;20(10):795-820.
3. Lindekleiv HM, Njølstad I, Ingebrigtsen T, Mathiesen EB. Incidence of aneurysmal subarachnoid hemorrhage in Norway, 1999-2007. Acta Neurol Scand. 2011;123(1):34-40.
4. Korja M, Kaprio J. Controversies in epidemiology of intracranial aneurysms and SAH. Nat Rev Neurol. 2016;12(1):50-5.
5. Etminan N, Macdonald RL. Management of aneurysmal subarachnoid hemorrhage. Handb Clin Neurol. 2017;140:195-228.
6. Connolly ES, Jr., Rabinstein AA, Carhuapoma JR, Derdeyn CP, Dion J, Higashida RT, et al. Guidelines for the management of aneurysmal subarachnoid hemorrhage: a guideline for healthcare professionals from the American Heart Association/ american Stroke Association. Stroke. 2012;43(6):1711-37.
7. Neifert SN, Chapman EK, Martini ML, Shuman WH, Schupper AJ, Oermann EK, et al. Aneurysmal Subarachnoid Hemorrhage: the Last Decade. Transl Stroke Res. 2021;12(3):428-46.
8. Steiner T, Juvela S, Unterberg A, Jung C, Forsting M, Rinkel G. European Stroke Organization guidelines for the management of intracranial aneurysms and subarachnoid haemorrhage. Cerebrovascular diseases. 2013;35(2):93-112.
9. Mac Grory B, Vu L, Cutting S, Marcolini E, Gottschalk C, Greer D. Distinguishing Characteristics of Headache in Nontraumatic Subarachnoid Hemorrhage. Headache. 2018;58(3):364-70.
10. Petridis AK, Kamp MA, Cornelius JF, Beez T, Beseoglu K, Turowski B, et al. Aneurysmal Subarachnoid Hemorrhage. Dtsch Arztebl Int. 2017;114(13):226-36.
11. Rouanet C, Silva GS. Aneurysmal subarachnoid hemorrhage: current concepts and updates. Arq Neuropsiquiatr. 2019;77(11):806-14.
12. Lawton MT, Vates GE. Subarachnoid Hemorrhage. N Engl J
etterkant av aSAH og for de fleste er livskvaliteten redusert (6, 26-29).
Utfallsmål brukt i RCT ved aSAH er modified Rankin Scale (mRS) og Glasgow Outcome scale. Begge er lite sensitive for kognitive utfall. Dette gjør at vi mister mye viktig informasjon om utkomme, og fremtidige studier bør inkludere andre verktøy som også belyser andre utfall. SAH Outcomes Tool (SAHOT), er et slikt verktøy, som inkluderer både kognitive, psykologiske og fysiske utfordringer etter aSAH bedre, men verktøyet må valideres før det kan tas i bruk (1, 2, 6, 7, 28, 30).
Kognitiv kartlegging og endringer etter SAH
Nevrokognitive tester gir viktig informasjon om type og omfanget av kognitiv svikt; men tester utføres ikke rutinemessig som ledd i oppfølging av aSAH verken i Norge eller internasjonalt. Både eksekutiv funksjon, hukommelse og språk er ofte affisert etter aSAH (7, 28, 31), men man vet altså ikke nok om omfanget.
Mange aSAH pasienter er ikke i stand til å fullføre et nevrokognitivt testbatteri, både på grunn av testvansker, redusert klinisk tilstand, fatigue eller hodepine. Resultater fra studier hvor man ser på utkomme etter aSAH kan dermed undervurdere den sanne
Med. 2017;377(3):257-66.
13. Dhandapani S, Singh A, Singla N, Praneeth K, Aggarwal A, Sodhi HB, et al. Has Outcome of Subarachnoid Hemorrhage Changed With Improvements in Neurosurgical Services? Stroke. 2018;49(12):2890-5.
14. Rush B, Romano K, Ashkanani M, McDermid RC, Celi LA. Impact of hospital case-volume on subarachnoid hemorrhage outcomes: A nationwide analysis adjusting for hemorrhage severity. J Crit Care. 2017;37:240-3.
15. Liang AS, Egladyous A, Jumah F, Raju B, Nagaraj A, Belykh E, et al. Tribute to William Edward Hunt and Robert McDonald Hess Jr.: Pioneers in the Clinical Classification of Ruptured Intracranial Aneurysms. World Neurosurg. 2022;164:93-6.
16. Mohan M, Islim A, Dulhanty L, Parry-Jones A, Patel H. CT angiogram negative perimesencephalic subarachnoid hemorrhage: is a subsequent DSA necessary? A systematic review. J Neurointerv Surg. 2019;11(12):1216-21.
17. Post R, Germans MR, Tjerkstra MA, Vergouwen MDI, Jellema K, Koot RW, et al. Ultra-early tranexamic acid after subarachnoid haemorrhage (ULTRA): a randomised controlled trial. Lancet. 2021;397(10269):112-8.
18. Osgood ML. Aneurysmal Subarachnoid Hemorrhage: Review of the Pathophysiology and Management Strategies. Curr Neurol Neurosci Rep. 2021;21(9):50.
19. Molyneux AJ, Birks J, Clarke A, Sneade M, Kerr RS. The durability of endovascular coiling versus neurosurgical clipping of ruptured cerebral aneurysms: 18 year follow-up of the UK cohort of the International Subarachnoid Aneurysm Trial (ISAT). Lancet. 2015;385(9969):691-7.
20. Geraghty JR, Lara-Angulo MN, Spegar M, Reeh J, Testai FD. Severe cognitive impairment in aneurysmal subarachnoid hemorrhage: Predictors and relationship to functional outcome. J Stroke Cerebrovasc Dis. 2020;29(9):105027.
21. Dayyani M, Sadeghirad B, Grotta JC, Zabihyan S, Ahmadvand S, Wang Y, et al. Prophylactic Therapies for Morbidity and Mortality
After Aneurysmal Subarachnoid Hemorrhage: A Systematic Review and Network Meta-Analysis of Randomized Trials. Stroke. 2022;53(6):1993-2005.
prevalensen av kognitiv svikt etter aSAH. Dertil er også tidspunktet for kognitiv testing forskjellig mellom studiene (31).
Uten kognitiv kartlegging som del av en rutine for slagpasienter generelt, og herunder også for aSAH pasienter, kan kognitive utfall være vanskelig å oppdage. Kognitiv svikt kan være subtil, og erkjennes ofte ikke før utskrivelse. Dermed sendes pasienter hjem med utfordringer vi ikke har tatt høyde for, som igjen kan gi utrygg hjemmesituasjon, underernæring, isolasjon, relasjonsvansker, jobbutfordringer, og i verste fall, manglende evne til å nyttiggjøre seg eventuelle rehabiliteringstiltak. I en del tilfeller vil ikke den kognitive svikten fanges opp før pasienten reinnlegges med psykosomatiske manifestasjoner, forvirring, delirium og kanskje ADL svikt, sekundært til udiagnostisert kognitiv svikt (28).
Forhåpentligvis vil man ved inklusjon av aSAH i Norsk hjerneslagregister kunne få systematisert oppfølgning av aSAH pasientene. Dette er en pasientgruppe med relativt lav gjennomsnittsalder, der mange fortsatt er i arbeid når katastrofen inntreffer, og et systematisert opplegg med flere oppfølgningstidspunkter i helsevesenet virker fornuftig.
22. Macdonald RL, Higashida RT, Keller E, Mayer SA, Molyneux A, Raabe A, et al. Randomised trial of clazosentan, an endothelin receptor antagonist, in patients with aneurysmal subarachnoid hemorrhage undergoing surgical clipping (CONSCIOUS-2). Acta Neurochir Suppl. 2013;115:27-31.
23. Norberg E, Odenstedt-Herges H, Rydenhag B, Oras J. Impact of Acute Cardiac Complications After Subarachnoid Hemorrhage on Long-Term Mortality and Cardiovascular Events. Neurocrit Care. 2018;29(3):404-12.
24. Oras J, Grivans C, Bartley A, Rydenhag B, Ricksten SE, Seeman-Lodding H. Elevated high-sensitive troponin T on admission is an indicator of poor long-term outcome in patients with subarachnoid haemorrhage: a prospective observational study. Crit Care. 2016;20:11.
25. Wesali S, Persson HC, Cederin B, Sunnerhagen KS. Improved survival after non-traumatic subarachnoid haemorrhage with structured care pathways and modern intensive care. Clin Neurol Neurosurg. 2015;138:52-8.
26. Westerlind E, Persson HC, Sunnerhagen KS. Working capacity after a subarachnoid haemorrhage: A six-year follow-up. J Rehabil Med. 2017;49(9):738-43.
27. Western E, Sorteberg A, Brunborg C, Nordenmark TH. Prevalence and predictors of fatigue after aneurysmal subarachnoid hemorrhage. Acta Neurochir (Wien). 2020;162(12):3107-16.
28. Nussbaum ES, Mikoff N, Paranjape GS. Cognitive deficits among patients surviving aneurysmal subarachnoid hemorrhage. A contemporary systematic review. Br J Neurosurg. 2021;35(4):384401.
29. Kulkarni AV, Devi BI, Konar SK, Shukla D. Predictors of Quality of Life at 3 Months after Treatment for Aneurysmal Subarachnoid Hemorrhage. Neurol India. 2021;69(2):336-41.
30. Saver JL. Novel end point analytic techniques and interpreting shifts across the entire range of outcome scales in acute stroke trials. Stroke. 2007;38(11):3055-62.
31. Al-Khindi T, Macdonald RL, Schweizer TA. Cognitive and functional outcome after aneurysmal subarachnoid hemorrhage. Stroke. 2010;41(8):e519-36.
Faktorer som kan øke risiko for residiv er1:
• Immunsvikt
• Tidligere CDI
• Sykehusopphold siste 3 måneder
• Protonpumpehemmer
• Høy alder
Utvalgt produkt- og sikkerhetsinformasjon DIFICLIR (fidaksomicin) 200 mg tabletter og granulat til mikstur, 40 mg/ml
Indikasjoner: For behandling av Clostridioides difficile-infeksjoner (CDI), også kjent som C. difficile-assosiert diaré (CDAD).
Tabletter: Hos voksne og pediatriske pasienter med en kroppsvekt på minst 12,5 kg. Granulat: Hos voksne, ungdom og barn 0 - < 18 år. For både tabletter og granulat skal det tas hensyn til offisielle retningslinjer for korrekt bruk av antibakterielle midler.
Vanligste bivirkninger: Vanlige: Forstoppelse, kvalme, oppkast.
Vanligste alvorlige bivirkninger: Overfølsomhetsreaksjoner inkl. alvorlig angioødem.
Interaksjoner: Forsiktighet utvises ved samtidig bruk av potente P-gp-hemmere.
Kontraindikasjoner: Overfølsomhet for innholdsstoffene.
Forsiktighetsregler: Fidaksomicin bør brukes med forsiktighet ved kjent allergi mot makrolider. Hvis det oppstår en alvorlig allergisk reaksjon, skal legemidlet seponeres og egnede tiltak igangsettes. Bør brukes med forsiktighet ved pseudomembranøs kolitt eller fulminant eller livstruende CDI, ved nedsatt lever- og nyrefunksjon. Granulat bør brukes med forsiktighet hos spedbarn < 6 måneder/< 4 kg.
Graviditet, amming og fertilitet: Graviditet: Det anbefales å unngå bruk under graviditet. Amming: Det må tas en beslutning om amming skal opphøre eller behandling avstås fra, basert på nytte-/risikovurdering. Fertilitet: Dyrestudier indikerer ingen effekt på fertilitet.
Dosering: Tabletter: Voksne og barn >12,5 kg: Standard dosering: Anbefalt dose er 200 mg (1 tablett) administrert 2 ganger daglig (1 tablett hver 12. time) i 10 dager. Utvidet pulsdosering: 200 mg tabletter administreres to ganger daglig for dag 1–5 (ingen tablett på dag 6) og deretter én gang daglig annenhver dag for dag 7–25. Hvis en dose blir glemt, skal den glemte dosen tas så snart som mulig, men hvis det snart er tid for neste dose, skal tabletten hoppes helt over. Granulat: Voksne: Anbefalt dose er 200 mg (5 ml) 2 ganger daglig (5 ml hver 12. time) i 10 dager. Ungdom og barn 0 - < 18 år: Anbefalt dose baseres på kroppsvekt og tas 2 ganger daglig (1 dose hver 12. time) i 10 dager.

Administrering: Tabletter: Kan tas med eller uten mat. Svelges hele sammen med et glass vann.
Granulat: Rekonstitueres av farmasøyt eller helsepersonell. Tas peroralt, eller via sonde.
Pakninger og priser: Tabletter 20 stk. (blister) kr 18 099,90. Granulat til mikstur: 1 stk. (glassflaske) kr 18 288,90.
Reseptgruppe C.
Basert på SPC godkjent av SLV/EMA: 12.12.2022.
PM-DG-NO-00003
For utfyllende informasjon om dosering, forsiktighetsregler, interaksjoner og bivirkninger – se felleskatalogen.no
retningslinjer
at Dificlir (fidaksomicin) vurderes til behandling av Clostridioides difficile-infeksjon (CDI) hos pasienter med høy risiko for residiv1
De siste årene har flere nye glukokortikoider for substitusjonsbehandling ved binyrebarksvikt blitt tilgjengelig i Norge. Mens vi i flere år bare hadde mulighet til å skrive ut kortisonacetat på blå resept, er nå hydrokortison tilgjengelig på H-resept i flere ulike former, både som vanlige tabletter og formuleringer med forlenget virketid. Dette gir oss klinikere bedre muligheter til å tilpasse behandlingen til den enkelte pasient.
Sviktende produksjon av binyrebarkhormoner finnes i to endogene hovedformer, primær binyrebarksvikt som skyldes sykdom i selve binyren, og sekundær (hypofysær) binyrebarksvikt som skyldes mangel på adrenokortikotropt hormon (ACTH). Langt hyppigere er iatrogen binyrebarksvikt forårsaket av farmakologisk behandling med glukokortikoider som er en form for sekundær binyrebarksvikt. Typiske kliniske trekk ved binyrebarksvikt er utilsiktet vekttap, anoreksi, postural hypotensjon, trøtthet, muskel- og magesmerter og hyponatremi. I tillegg utvikler pasienter med primær binyrebarksvikt vanligvis hyperpigmentering av hud og en uttalt salthunger. Før kortison ble tilgjengelig på slutten av 1940-tallet, var primær binyrebarksvikt dødelig. Introduksjon av hydrokortison og senere fludrokortison (for å erstatte aldosteron) revolusjonerte behandlingen og konverterte primær binyrebarksvikt til en sykdom med god prognose. Dessverre rapporterer pasientene fortsatt om redusert livskvalitet og arbeidskapasitet, og studier viser økt dødelighet [1]. Nye metoder for tilførsel av glukokortikoider synes å kunne forbedre livskvaliteten hos noen pasienter med binyrebarksvikt, og ytterligere fremskritt innen oral og parenteral terapi vil trolig bli tilgjengelig i løpet av de neste årene.
Mens både primær og sekundær binyrebarksvikt er relativt sjeldne sykdommer med prevalenser på
henholdsvis 20 og 30 per 100 000, er iatrogen binyrebarksvikt relativt hyppig [2]. Om lag 2% av befolkningen bruker glukokortikoider i en eller annen form til enhver tid. Ikke bare peroral og parenteral behandling, men også lokalbehandling kan gi permanent binyrebarksvikt med behov for substitusjonsbehandling [3].
Primær binyrebarksvikt Ved ervervet primær binyrebarksvikt er sekresjonen av kortisol og aldosteron mangelfull eller helt fraværende. Den vanligste årsaken er autoimmun destruksjon av binyrebarken som i Norge utgjør om lag 90 prosent av tilfellene. Denne formen debuterer vanligst i 20-50 års alder, men kan opptre hele livet. Debut hos barn under 2 år ses svært sjelden. Autoantistoffer mot enzymet 21-hydroksylase benyttes som diagnostisk markør og er i de aller fleste tilfellene positiv [4, 5].

Den vanligste medfødte formen er kongenitt adrenal hyperplasi (CAH) som skyldes mangel på enzymet 21-hydroksylase (CYP21A2), noe som fører til kortisol- og androsteronmangel og overskudd av binyreandrogener. De alvorligste tilfellene diagnostiseres kort tid etter fødselen. Jenter med CAH kan være født med virilisering av genitalia, mens gutter ikke har en spesiell fenotype ved fødsel. CAH inngår i nyfødtscreeningprogrammet.
For riktig tilnærming til substitusjonsbehandling er det viktig å skille disse formene. Mens substitusjonsbehandlingen ved primær binyrebarksvikt har som formål å erstatte bortfall av aldosteron og kortisol, vil substitusjonsbehandlingen ved CAH i tillegg ha som mål å hemme overproduksjonen av androgener.
Sekundær, tertiær og iatrogen binyrebarksvikt Ved sekundær og iatrogen binyrebarksvikt skyldes kortisolmangelen manglende ACTH. Under mangelfull ACTH-stimulering vil det oppstå atrofi av de kortisolproduserende cellene i binyrebarkens midtre lag. Det indre laget som produserer binyreandrogener er også utsatt. Siden aldosteronproduksjonen i hovedsak reguleres av reninangiotensinsystemet vil ikke bortfall av ACTH-stimulering føre til atrofi av det ytre laget. Derfor behøver man ikke gi fludrokortison (aldosteron erstatning) ved disse formene for binyrebarksvikt. Samtidig bruk av veksthormonsubstitusjon, som kan være aktuelt ved hypofysær binyrebakrsvikt, kan øke kortisonbehovet.

Standard substitusjonsbehandling i Norge er kortison (Cortison®) gitt i 2 eller 3 daglige doser, den høyeste ved oppvåkning og de neste, enten ved lunsj og sen ettermiddag, eller ettermiddag (2-doseregime). Ut fra beregninger av egenproduksjon vil
25 mg kortison være tilstrekkelig for de aller fleste voksne (12,5+6,25+6,25 mg), men det er inter-individuelle variasjoner og mange bruker høyere doser. Kortison som er inaktivt må omdannes til kortisol ved hjelp av 11-beta-hydroksysteroid dehydrogenase. Mange andre land benytter hydrokortison (kortisol) med anbefalt gjennomsnittlig døgndose på 20 mg. Halveringstiden for begge medikamenter er kort, om lag 90 minutter, men kortison har noe lengre virketid enn hydrokortison.

Nytt i 2022 er registrering av hydrokortisontabletter i Norge under salgsnavnet Lilinorm ® i en pakning med 10 mg og 5 mg tabletter, tilpasset 3-dosebehandling (10 + 5 + 5 mg daglig). Fra 1. januar 2023 er dette de eneste hydrokortisontabletter som fås på registreringsfritak (https://legemiddelverket.no/nyheter/ hydrokortison-tabletter-settes-panegativlista).
Personer med sekundær binyrebarksvikt kan som oftest klare seg med mindre doser fordelt på en morgen og ettermiddagsdose, avhengig av om utfall av hypofyse-binyreaksen er komplett eller partiell.
Et alternativ til multiple doser med kortison eller hydrokortison er et depotpreparat av hydrokortison, Plenadren® som tas 1 gang daglig om morgenen. Tablettens skall har lettoppløselig hydrokortison som gir en rask stigning i kortisol tilsvarende den vanlige tabletten, mens kjernen inneholder en matriks som sørger for forsinket frigjøring (Figur 1). Plenadrenbehandlingen koster om lag 30 ganger mer en Cortison og foreskrives på H-resept. Plenadren® ble godkjent for erstatningsterapi i 2011 og brukes i dag av rundt 20 prosent av pasientene med binyrebarksvikt i Norge. Godkjenningen var basert på en åpen studie som dokumenterte reduksjon av vekt, blodtrykk og glukosenivåer [6]. Oppfølgingsstudier har bekreftet at langtidsbruk av Plenadren er trygt [7], men overlegenhet i forhold til konvensjonell kortisonbehandling er ikke bevist.

én
Det er derfor planlagt en nasjonal prospektiv klinisk studie med oppstart i mars 2023. Målet med studien er å undersøke om Plenadren er overlegen standardbehandling med kortison hos nydiagnostiserte pasienter med primær binyrebarksvikt (CORTAD studien). Det primære målet er å finne ut om Plenadren gir bedre livskvalitet, arbeidsevne, søvnkvalitet og kognitiv funksjon enn standard kortisonbehandling. Sekundære mål inkluderer kliniske markører for kardiometabolske risikofaktorer, beinhelse og kortisoleksponering.
Høsten 2022 ble nok et depotpreparat med hydrokortison godkjent for bruk ved CAH, Efmody ®. Denne skiller seg fra Plenadren ved at frigjøringen av medikament er forsinket («delayed release») og at den tas 2 ganger daglig. Tabletten med høyest dose tas om kvelden (typisk 15 mg) og frigjøringen starter på natten slik at høye nivåer av kortisol oppnås sent på natten og tidlig morgen. På denne etterlignes den circadiane kortisolrytmen bedre. En ny depottablett tas på morgenen (typisk 5 mg) for å forlenge kortisoltoppen og slik
Tabell
Oversikt over tilgjengelige glukokortikoider for primær binyrebarksvikt i Norge. Preparat Tilgjengelig form og styrke Legemiddel foto Halveringstid Typisk daglig dosering Merknader
Cortison® (kortison) Tablett; 25 mg

Lilinorm® (hydrokortison) Tablett; 5 og 10 mg
Plenadren® (hydrokortison) Tablett; 5 og 20 mg
Prednisolon® (prednisolon) Tablett; 2,5 og 5 mg

Ca. 90 minutter 12,5 + 6,25 + 6,25 mg, tas typisk ved oppvåkning og 4 og 8 timer senere

Ca. 90 minutter 10 + 5 + 5 mg
Pakning med 10 og 5 mg tabletter, H-resept
Terminal t1/2: Ca. 3 timer 20 - 25 mg èn gang daglig, morgen H-resept
Ca. 3 timer 3 - 5 mg èn gang daglig, morgen
Efmody® (hydrokortison) Tablett; 5 og 10 mg Terminal t1/2

15 - 25 mg hos voksne Godkjent for CAH*, H-resept
Alkindi® (hydrokortison) Kapsel; 0,5, 1, 2 og 5 mg
Solu Cortef® (hydrokortison)
Infusjonsvæske, subkutan pumpe; 50 og 125 mg/ml
*CAH: Kongenitt adrenal hyperplasi
hemme den økte androgenproduksjonen som er et behandlingsmål ved CAH. Dette såkalte tannbørste regimet (ved sengetid og om morgenen) har vist å kunne oppnå lavere nivåer av androgenforløperen 17OHprogesterone [8].

Et alternativ til depottabletter med hydrokortison er å bruke Prednisolon® som har lang halveringstid. Prednisolon kan føre til økt dyslipidemi [9] og redusert benmineraltetthet [10] sammenlignet med standardbehandling med kortison. Imidlertid har en senere studie ikke gitt holdepunkter for at prednisolonbehandlingen har en ugunstig kardiometabol profil sammenlignet med hydrokortison dersom døgndosen ikke overskrider 3-4 mg daglig [11]. Prednisolon har fem ganger sterkere antiinflammatorisk effekt enn hydrokortison og den mineralkortikoide (saltretinerende) effekten er mindre enn hydrokortisonets. Deksametason er ikke indisert for erstatningsbehandling grunnet lang halveringstid og høy risiko for Cushingoide bivirkninger.
For spedbarn, barn og ungdom finnes også et spesialpreparat med hydrokortison, Alkindi®, som er granulat i kapsler med styrker fra 0,5 til 5 mg noe som gjør dosetilpasning til barn lettere [12].
Kommer man ikke i mål med tablettbehandling kan subkutan infusjon av hydrokortison i noen tilfeller være et alternativ. Hydrokortisonløsningen gis via en insulinpumpe subkutant. Med denne behandlingen kan den circadiane variasjonen i kortisol gjenskapes. Noen få studier av pumpebehandling har vist at den gir få komplikasjoner og kan bedre livskvalitet [13-16]. Vår erfaring er at den kan være til stor hjelp for enkelte pasienter. Imidlertid har det oppstått et praktisk problem i det produsenten av Solu-Cortef ® har redusert holdbarheten av utblandet medikament fra 3 til 1 døgn, noe som fordrer daglig utskifting av hydrokortisonløsning i pumpen og gjør behandlingen svært kostbar. Større randomiserte studier som viser effekt av behandlingen over tid mangler.
Godkjent for barn, H-resept
Må søke for å få dekning etter blåreseptforskriften
Substitusjonsbehandling med mineralkortikoider
Mineralkortikoidbehandling med fludrokortison (Florinef ®) kombinert med adekvat saltinntak er indisert til alle med primær binyrebarksvikt fordi disse pasientene har mangel på aldosteron. Dette gjelder både pasienter med primær binyrebarksvikt og pasienter med salt-tapende og klassisk CAH. De fleste behøver 0,1 mg daglig (0,050,15 mg) og dosering evalueres ved å spørre om salthunger og kontrollere blodtrykk sittende og stående. Plasma reninaktivitet eller reninnivå kan også benyttes, men er en grov parameter. Svært høye reninverdier, ortostatisme og hyperkalemi indikerer underdosering, mens ødemutvikling og hypokalemi tyder på overdosering.
Oppfølging av pasienter
Vi anbefaler årlig kontroll av alle pasienter med binyrebarksvikt hos spesialist i endokrinologi eller indremedisin. Grunnprinsippet er å bruke lavest mulig effektiv dose kortikosteroider. Det finnes ingen god biomarkør
som glukokortikoidbehandlingen kan styres etter, så det blir en klinisk vurdering av Cushingssymptomer og tegn (overdosering), vektnedgang, hypotensjon og eventuelt økende pigmentering (underdosering). Vekt, blodtrykk sittende og stående, lipidprofil og HbA1c anbefales med tanke på metabole komplikasjoner. Om man mistenker manglende opptak av medikamentet kan en kortisolkurve være nyttig med måling av serum eller spyttkortisol før og 1, 2 og 3 timer etter tablettinntak. Måling av ACTH hormon har ingen verdi ved oppfølging av behandlingen.
To av tre pasienter med autoimmun primær binyrebarksvikt utvikler en annen autoimmun sykdom, vanligst autoimmun tyreoideasykdom (både Hashimotos tyreoiditt og Graves sykdom), type 1 diabetes, cøliaki, og autoimmun gastritt med vitamin B12mangel. Årskontrollen tar sikte på å screene for disse komplikasjonene. Kvinner har økt risiko for prematur menopause, noe som opptrer hos 10-15 prosent, og er viktig å informere om. Fokus på håndtering av stress, inkludert ekstrem fysisk belastning, psykisk stress, svangerskap, operasjoner og interkurrent sykdom er viktig og alle pasienter skal utstyres med akuttkort og de fleste bør også få utskrevet Solu-Cortef ® for bruk ved binyrekriser. Pasientkurs, såkalte kortisolskoler er etablert ved flere av landets sykehus der pasientene blant annet får opplæring i å sette Solu-Cortef ® intramuskulært. Etter diagnose oppstår binyrekrise hos omtrent 50 % av pasientene med binyrebarksvikt og noen dør alt for tidlig av dette, så opplæring er svært viktig.
Referanser
1. Bergthorsdottir, R., et al., Premature mortality in patients with Addison’s disease: a population-based study. J Clin Endocrinol Metab, 2006. 91(12): p. 484953.
2. Husebye, E.S., et al., Adrenal insufficiency. Lancet, 2021. 397(10274): p. 613-629.
3. Paragliola, R.M., et al., Treatment with Synthetic Glucocorticoids and the Hypothalamus-Pituitary-Adrenal Axis. Int J Mol Sci, 2017. 18(10).
4. ROAS, Norsk kvalitetsregister for organspesifikke autoimmune sykdommer årsrapport for 2021. 2021: Haukeland universitetssjukehus, Helse Bergen.
5. Wolff, A.B., et al., The natural history of 21-hydroxylase autoantibodies in autoimmune Addison’s disease. Eur J Endocrinol, 2021. 184(4): p. 607-615.
6. Johannsson, G., et al., Improved cortisol exposuretime profile and outcome in patients with adrenal insufficiency: a prospective randomized trial of a novel hydrocortisone dual-release formulation. J Clin Endocrinol Metab, 2012. 97(2): p. 473-81.
Tabell 2: Klinisk vurdering ved årskontroll for primær binyrebarksvikt (PAI).
Anamnese og klinisk undersøkelse:
• Energistatus / slapphet, salthunger, kvalme, svimmelhet, arbeidsevne, søvn, muskel- og leddsymptomer, gastrointestinale symptomer. Har pas. hatt binyrekrise? Hvordan ble den håndtert? Øvrig medikamentbruk.
• Komorbiditet, med spesiell fokus på andre autoimmune sykdommer som autoimmun hypo- og hypertyreose, diabetes type 1, autoimmun gastritt med vitamin B12-mangel, cøliaki, hjerte- og karsykdommer og osteoporose.
Klinisk undersøkelse:
Vekt, blodtrykk sittende og stående, pigmentering av hud.
Blodprøver:
Hb, Na, K, kreatinin, lipider, HbA1c, TSH, FT4, renin, ferritin, kobalamin, folat.
Informasjon og opplæring:
Stress-håndtering med økt substitusjonsdose
Utlevering av norsk kortisolmangel kort (Figur 2)
Opplæring i å sette Solu-Cortef ® ved binyrekrise
Tilby pasientkurs med vekt på håndtering av binyrekriser («Kortisolskole»)
Kvinner: Barneønske, fertilitet, risiko for prematur ovariesvikt
Kvalitetsregister bedrer pasientbehandlingen
Et av de største hindrene for forskning innen binyresykdommer har vært mangel på store pasientmaterialer. Najsonalt kvalitetsregister for organspesifikke autoimmune sykdommer (ROAS) ble grunnlagt i 1996 og har etablert seg som det største i sitt slag i verden, og dekker rundt 65 prosent av norske pasienter med PAI.
[4] Fra 2012 er det også et medisinsk kvalitetsregister der parametre som binyrekriser, utdeling av kortisolkort og Solu-Cortef® registreres. Mer informasjon om registeret finner du på (www.haukeland.no/roas)
7. Nilsson, A.G., et al., Long-term safety of once-daily, dual-release hydrocortisone in patients with adrenal insufficiency: a phase 3b, open-label, extension study. Eur J Endocrinol, 2017. 176(6): p. 715-725.
8. Whitaker, M.J., H. Huatan, and R.J. Ross, Chronotherapy based on modified-release hydrocortisone to restore the physiological cortisol diurnal rhythm. Drug Deliv Transl Res, 2023. 13(1): p. 1-8.
9. Quinkler, M., et al., Prednisolone is associated with a worse lipid profile than hydrocortisone in patients with adrenal insufficiency. Endocr Connect, 2017. 6(1): p. 1-8.
10. Frey, K.R., et al., Prednisolone is associated with a worse bone mineral density in primary adrenal insufficiency. Endocr Connect, 2018. 7(6): p. 811-818.
11. Smith, D.J.F., et al., Prednisolone has the same cardiovascular risk profile as hydrocortisone in glucocorticoid replacement. Endocr Connect, 2017. 6(8): p. 766-772.
12. Neumann, U., et al., Absorption and tolerability of taste-masked hydrocortisone granules in neonates,
og på www.kvalitetsregistre.no. Vi oppmuntrer til at alle med primær binyrebarksvikt inkluderes.
Det finnes også en aktiv pasientforening, Morbus Addisonforeningen som kan gi pasientene nyttig, informasjon og opplæring (www. addison.no).
infants and children under 6 years of age with adrenal insufficiency. Clin Endocrinol (Oxf), 2018. 88(1): p. 21-29.
13. Oksnes, M., et al., Continuous subcutaneous hydrocortisone infusion versus oral hydrocortisone replacement for treatment of addison’s disease: a randomized clinical trial. J Clin Endocrinol Metab, 2014. 99(5): p. 1665-74.
14. Løvås, K. and E.S. Husebye, Continuous subcutaneous hydrocortisone infusion in Addison’s disease. Eur J Endocrinol, 2007. 157(1): p. 109-12.
15. Björnsdottir, S., et al., Circadian hormone profiles and insulin sensitivity in patients with Addison’s disease: a comparison of continuous subcutaneous hydrocortisone infusion with conventional glucocorticoid replacement therapy. Clin Endocrinol (Oxf), 2015. 83(1): p. 28-35.
16. Gagliardi, L., et al., Continuous subcutaneous hydrocortisone infusion therapy in Addison’s disease: a randomized, placebo-controlled clinical trial. J Clin Endocrinol Metab, 2014. 99(11): p. 4149-57.
Norske indremedisinere har stor glede og nytte av Indremedisineren (IM). IM bidrar til faglig utvikling og er både et viktig bindeledd i miljøet, og mellom styret i NIF og det enkelte medlem.
I løpet av pandemien har de aller fleste møter, kurs og seminarer vært avlyst eller nettbasert, og Indremedisineren har spilt en enda viktigere rolle for norske indremedisinere. Dette vil vi fortsette med!

Redaksjonen og alle bidragsytere jobber på dugnad. Dere annonsører bidrar til at vi kan utgi et flott IM og at vi kan drifte indremedisineren.no, der trafikken er sterkt økende. Uten deres hjelp hadde det ikke vært mulig.
Vi håper det gode samarbeidet fortsetter, og at dere blir med videre i 2023!
(budesonid, formoterol, glykopyrronium) Inhalasjonsaerosol








TRIXEO AEROSPHERE® (formoterol fumaratdihydrat, glykopyrroniumbromid, budesonid). Viktig informasjon (utvalg). Indikasjon: Vedlikeholdsbehandling hos voksne med moderat til alvorlig kols som ikke er adekvat behandlet med en kombinasjon av et inhalert kortikosteroid og en langtidsvirkende β2agonist, eller med en kombinasjon av en langtidsvirkende β2agonist og en langtidsvirkende muskarinantagonist. Dosering: Anbefalt og maks. dose er 2 inhalasjoner 2 ganger daglig (2 inhalasjoner morgen og 2 inhalasjoner kveld). Vanlige bivirkninger: Oral candidainfeksjon, pneumoni, hyperglykemi, angst, insomni, hodepine, palpitasjoner, dysfoni, hoste, kvalme, muskelspasmer, urinveisinfeksjon. Forsiktighetsregler (utvalg): Ikke indisert til å behandle akutte tilfeller av bronkospasme, dvs. som akutt -behandling. Brukes med forsiktighet hos pasienter med klinisk signifikante ukontrollerte og alvorlige kardiovaskulære sykdommer. Systemiske effekter kan forekomme, særlig ved høye doser forskrevet over lange perioder, slik som Cushings, binyresuppresjon, nedsatt bentetthet, katarakt og glaukom. Ved forverring av sykdom anbefales det ikke å stoppe behandlingen brått. Utvis forsiktighet når andre betaadrenerge legemidler forskrives samtidig. For fullstendig informasjon les SPC 19.05.2022 på www.felleskatalogen.no Refusjonsberettiget bruk4: Vedlikeholdsbehandling ved kols, i henhold til preparatomtale. Refusjonskoder, ICPC: R95 kronisk obstruktiv lungesykdom, ICD: J44 annen kronisk obstruktiv lungesykdom. Reseptgruppe C. Pakninger og priser: Trixeo Aerosphere 5 µg/7,2 µg/160 µg: 120 doser (hvit inhalator, varenr. 401446) kr. 735,90. 3 x 120 doser (hvit inhalator, varenr. 047454) kr. 2051,60 Trixeo Aerosphere 5 µg/7,2 µg/160 µg: 120 doser (gul inhalator, Evocap, varenr. 446225) kr. 735,90. 3 x 120 doser (gul inhalator, Evocap, varenr. 162095) kr. 2051,60 Inhalatorer (hvite) med varenr. 401446 og 047454 vil etter hvert utgå og finnes samtidig på markedet en periode med de nye inhalatorene (gule, Evocap) som har varenr. 446225 og 162095.. Se Trixeo Aerosphere felleskatalogtekst, www.felleskatalogen.no (sjekket 27.10.2022)



















Referanser:

1. Trixeo Aerospehere SPC 19.05.2022 pkt. 5.1 2. Trixeo Aerospehere SPC 19.05.2022 pkt. 4.4 3. Trixeo Aerospehere SPC 19.05.2022 pkt. 4.1 4. Felleskatalogtekst for Trixeo Aerosphere www.felleskatalogen.no (sjekket 27.10.2022).


24% REDUKSJON (RRR)



Ikke indisert til å behandle akutte tilfeller av bronkospasme, dvs. som akuttbehandling2
Ikke indisert til å behandle akutte tilfeller av bronkospasme, dvs. som akuttbehandling2
Brukes med forsiktighet ved klinisk signifikant ukontrollert og alvorlig kardiovaskulær sykdom2
Brukes med forsiktighet ved klinisk signifikant ukontrollert og alvorlig kardiovaskulær sykdom2
REDUKSJON (RRR)
I RATEN AV MODERATE ELLER ALVORLIGE FORVERRINGER vs LAMA/LABA (formoterol/glykopyrrionium)1
(95% CI: 17, 31; p<0,0001).
I RATEN AV MODERATE ELLER ALVORLIGE FORVERRINGER vs LAMA/LABA (formoterol/glykopyrrionium)1
Frekvens: 1,08 vs 1,42 hendelser/pasientår 1
(95% CI: 17, 31; p<0,0001).
TRIXEO vs ICS/LABA (budesonid/formoterol) viste en reduksjon på 13%. RR: 0.87; (0.79–0.95), p=0,003 1
Frekvens: 1,08 vs 1,42 hendelser/pasientår 1
TRIXEO vs ICS/LABA (budesonid/formoterol) viste en reduksjon på 13%. RR: 0.87; (0.79–0.95), p=0,003 1
AV ALVORLIGE FORVERRINGER (SOM RESULTERTE I SYKEHUSINNLEGGELSE ELLER DØD) VS ICS/LABA
AV ALVORLIGE FORVERRINGER (SOM RESULTERTE I SYKEHUSINNLEGGELSE ELLER DØD) VS ICS/LABA
(95% CI: 3,34; p=0,002) sammenlignet med budesonid/formoterol MDI. Frekvens: 0,13 vs 0,16 hendelser pr. pasientår. Ingen reduksjon av sykehusinnleggelser eller død vs LAMA/LABA (formoterol/glykopyrrionium)
(95% CI: 3,34; p=0,002) sammenlignet med budesonid/formoterol MDI. Frekvens: 0,13 vs 0,16 hendelser pr. pasientår. Ingen reduksjon av sykehusinnleggelser eller død vs LAMA/LABA (formoterol/glykopyrrionium)1
RRR: relative risikoreduksjon. ICS=inhalert kortikosteroid, LAMA=langtidsvirkende muskarinreseptorantagonist, LABA=langtidsvirkende beta2-agonist
Indikasjon for Trixeo:3 Vedlikeholdsbehandling hos voksne med moderat til alvorlig kols som ikke er adekvat behandlet med en kombinasjon av et inhalert kortikosteroid og en langtidsvirkende β2-agonist, eller med en kombinasjon av en langtidsvirkende β2-agonist og en langtidsvirkende muskarinantagonist.
RRR: relative risikoreduksjon. ICS=inhalert kortikosteroid, LAMA=langtidsvirkende muskarinreseptorantagonist, LABA=langtidsvirkende beta2-agonist
Indikasjon for Trixeo:3 Vedlikeholdsbehandling hos voksne med moderat til alvorlig kols som ikke er adekvat behandlet med en kombinasjon av et inhalert kortikosteroid og en langtidsvirkende β2-agonist, eller med en kombinasjon av en langtidsvirkende β2-agonist og en langtidsvirkende muskarinantagonist.
(budesonid, formoterol, glykopyrronium) Inhalasjonsaerosol
(budesonid, formoterol, glykopyrronium) Inhalasjonsaerosol
Hovedkjennetegnet til BRASH syndrom er bradykardi, som oppstår i samspillet mellom hyperkalemi og frekvensregulerende legemidler. Syndromet er underdiagnostisert, og den aldrende befolkningen er spesielt utsatt. Disse har høyere risiko for å utvikle nyresvikt, medisinbivirkninger og uvanlige sykdommer som BRASH syndrom.
BRASH syndrom er en ny akuttmedisinsk entitet og inkluderer fem karakteristika definert ved tilstedeværelse av B - bradykardi, R -renal failure, A-AV blockade, S -shock og H -hyperkalemia. Syndromet ble først beskrevet av dr. Josh Farkas i 2016 (1), og er en lite erkjent klinisk tilstand. Hovedtegnet bradykardi er resultatet av en synergistisk effekt mellom hyperkalemi og legemidler som hemmer ledningshastigheten over AV-knuten (AV-knute-blokkerende medisiner som betablokkere eller kalsiumantagonister). Klinikken kan variere fra asymptomatisk bradykardi til multiorgansvikt. Ved rask og riktig behandling kan forstyrrelsene korrigeres innen 24-48 timer. Målet med artikkelen er å øke gjenkjennelsen av BRASH syndrom og å gi noen praktiske tips til behandling som kan
forbedre pasientens tilfriskning og overlevelse.
Epidemiologi
I litteraturen finnes flere kasuistikkpresentasjoner (2-14), men det er vanskelig å si noe sikkert om forekomsten av BRASH syndrom. Basert på de publiserte rapportene, diagnostiseres BRASH syndrom oftest hos eldre pasienter med underliggende hjerte- og nyresykdom (figur 1).
En ny systematisk oversikt angir median alder ved diagnosetidspunkt 71 år (IQR 62,0–80,5), med nesten lik prevalens for begge kjønn (15). De fleste av pasientene har hypertensjon, etterfulgt av diabetes, atrieflimmer og koronarsykdom.

Patofysiologi
Enhver årsak som fremmer nyreskade og dermed hyperkalemi kan starte denne onde sirkelen. Tilstanden blir derfor typisk trigget av for eks. hypovolemi (feber, sepsis, gastroenteritt), tumorlyse, avløpshinder, og opptraping av medikamenter (ACEhemmere/angiotensin 2-blokkere eller spironolakton).
Når hyperkalemien er etablert, virker den som angitt synergistisk med AVknute-hemmere (betablokkere eller kalsiumantagonister) og kan indusere bradykardi. Redusert minuttvolum (minuttvolum = slagvolum x hjertefrekvens) forverrer blodforsyningen til nyrer og forsterker nyreskade og hyperkalemi. Hvis bradykardien forblir ubehandlet, kan det utvikles sjokk med multiorgansvikt (figur 2).
Betablokkere, med metoprolol etterfulgt av karvedilol, synes å være de hyppigst brukte medisinene hos pasienter som utvikler BRASH syndrom (15). Kalsiumantagonister, inkludert diltiazem, verapamil og amlodipin kom på andre plass etterfulgt av angiotensin-konverterende enzym -hemmere eller angiotensinreseptorblokkere. Andre medisiner oppført som utløsende faktorer er amiodaron, oktreotid, ranolazin og trimetoprimsulfametoksazol. Medikamenter som labetalol eller karvedilol (uselektive beta-reseptorantagonister) kan sjelden gi hyperkalemi alene, men de kan forverre en allerede eksisterende hyperkalemi. Atenolol skilles ut renalt, og ved nedsatt nyrefunksjon kan dette ha toksiske effekter og føre til bradykardi.
Triggere for nyresvikt:
- Prerenale
- Renale
- Postrenale
Nyresvikt
Opphopning av betablokker som skilles via nyrer *
Renal hypoperfusjon
Hypotensjon
* Ikke-selektive betablokker kan forårsake hyperkalemi
Betablokker eller Kalsiumantagonist +
Hyperkalemi
Isolert hyperkalemi
Typisk EKG tegn: Initialt forekommer økt amplitude av T-bølge. Senere kan forlenget PR-intervall og breddeøket QRS-kompleks utvikles med økt risiko for ventrikkeltakykardi, bradykardi og asystoli
Hyperkalemi er velkjent for å kunne gi bradykardi (vanligvis ved K over 7 - 8 mmol/l).
Bradykardi
BRASH syndrom
Bradykardi med lav til moderat hyperkalemi uten typiske EKGendringer.
Pasienter tar legemidler som foreskrevet.
Effekt av AV-knute-hemmer
AV-knute-hemmere kan åpenbart forårsake bradykardi, men denne effekten er vanligvis ikke merket ved terapeutiske doser.
Klinisk presentasjon
Den initiale presentasjonen ved BRASH syndrom kan variere fra generell svakhet, endret mental status eller synkope (10), snarere enn klinikk forenlig med utløsende tilstander som dehydrering, infeksjon osv. Klinikken varierer fra asymptomatisk bradykardi til multiorgansvikt. Pasienter kan fremstå i klinisk bedre form enn vitalia og biokjemi skulle tilsi. Noen kan ha markant bradykardi
og hypotensjon med mild hyperkalemi, mens andre kan ha alvorlig hyperkalemi og moderat bradykardi med tilfredsstillende blodtrykk. Hos de fleste er kalium mellom 5,5 – 7 mmol/l. Som oftest ses bradykardi uten typiske EKG forandringer. Risikoen for alvorlig arytmi og hjertestans er forhøyet, uansett om pasienter har typiske EKG endringer relatert til hyperkalemien eller ikke.
Differensialdiagnoser
BRASH syndrom kjennetegnes av refraktær bradykardi, og er et resultat av samspillet mellom AV-knute-blokkere og hyperkalemi. Å sette klare og strikte grenser mellom BRASH syndrom og isolert hyperkalemi eller isolert overdosering med AV – knute blokkerende legemidler kan være vanskelig. Det er imidlertid nyttig å fors øke å trekke fram noen forskjeller mellom disse tre tilstandene (figur 3).
BRASH syndrom versus intoksikasjon med AV-knute-hemmere.
Betablokkere og kalsiumantagonister kan gi lav puls, men bradykardi oppstår sjeldent ved terapeutiske doser. Ved BRASH syndrom tar pasienter legemidlene som foreskrevet. Ved forgiftning med betablokkere kan hypoglykemi forekomme, mens etter inntak av toksiske doser av kalsiumantagonister kan man forvente hyperglykemi. Endring i glukosenivå er imidlertid ikke typisk for BRASH syndrom.
BRASH syndrom versus isolert hyperkalemi. Isolert hyperkalemi kan gi bradykardi, men vanligvis ved kalium-nivåer over 7-8 mmol/l (15). Ved BRASH syndrom kommer ofte bradykardien ved lavere kalium verdier, vanligvis mellom 5,5 – 7 mmol/l. EKG hos pasienter med BRASH syndrom kan vise bradykardi uten de typiske forandringer som sees ved hyperkalemi og man finner som oftest sinus bradykardi, nodal bradykardi, komplett AV blokk
eller atrieflimmer/flutter med lav ventrikkelrespons (16).
Behandling
Vi har ingen standardisert behandlingsalgoritme for BRASH syndrom. Den vanligste fallgruven ved behandlingen er å bare fokusere på en enkelt komponent i syndromet, enten bradykardi eller hyperkalemi. Behandlingen består i å bryte den onde sirkelen og samtidig behandle hyperkalemi (i.v kalsium, insulin/ glukose, beta agonister, diurese), bradykardi (epinefrin infusjon kan være nødvendig), hypovolemi, osv. I noen tilfeller er det behov for mer avansert behandling (akutt dialyse, transvenøs pacemaker, glukagon, høydose insulin-glukosebehandling, lipidemulsjonsterapi).
Hyperkalemi korreksjon. Ved hyperkalemi indusert bradykardi asossiert med BRASH syndrom gis kalsium intravenøst uansett kaliumnivå, da bradykardien er et resultat av hyperkalemiens kardiotoksiske effekt. 20
ml (4,5 mmol) kalsiumglukonat injiseres iv. ufortynnet perifert over 5- 10 minutter. Effekt forventes ila et par minutter og varer i 30-60 minutter. Hvis arytmi/EKG endringer vedvarer, kan man repetere dosen.
Neste behandlingskritt er å senke serum kalium ved å redistribuere kalium inn i cellene. Glukose-insulin infusjon, salbutamol inhalasjon, bricanyl infusjon eller bikarbonat ved pH<7,10 er aktuelle behandlingsalternativer. Man kan bruke forskjellige insulin glukose blandinger, avhengig av volumstatus og hvor rask effekt man ønsker. Hovedregel: 1000ml 50 mg/ml glukose tilsatt 15 E hurtigvirkende insulin (Novorapid) med infusjonsfart 100-200 ml/time. Grunnet fare for hypoglykemi ved blodglukose < 7 mmol/L gis 250 ml 10 % glukose (ev. 500 mL 5%) over fem timer i eget løp. Ved utilstrekkelig effekt av glukose-insulin-infusjon kan det vurderes Ventolin inhalasjon 10 mg på forstøver eller Bricanyl infusjon 0,5-1,0 mg i.v. i 100 ml glukose over ½-1 time. Effekten kan være begrenset hos personer som behandles med betablokker. Ved hyperkalemi og metabolisk acidose fullkorrigeres acidosen (0,3 × vekt (kg) × BE); f.eks. 250 ml NaHCO3 4,2 % (500 mmol/L) over 1-2 timer. Overkorreksjon (alkalinisering) brukes ikke.
I tillegg til å flytte kalium intracellulært, skal man øke kalium utskillelsen. Det er best å bruke Natriumzirkoniumsyklosilikat (Lokelma; 10 g × 3 p.o.) som øker enteral utskillelse av kalium (binder K+ i tarm), og kontinueres til s-kalium < 5 mmol/L. Slyngediuretika som øker kalium utskillelse via nyrer gis ved hypervolemi.
Bradykardi +/- sjokk. Ved BRASH syndrom er atropin vanligvis ineffektiv fordi bradykardien ikke er vagus-indusert. Kalsium i.v. gis for å motvirke hyperkalemien. Hvis denne behandlingen feiler, og ved vedvarende bradykardi med hypotensjon, gis Adrenalin infusjon etter internasjonal anbefaling (1). Den har alfa- og betastimulerende effekt, og øker blodtrykk, hjertefrekvens, samt øker influks av kalium inn i celler.
Isoprenalin infusjon gis ved okkult sjokk, dvs. bevart blodtrykk grunnet uttalt vasokonstriksjon og kliniske tegn på dårlig systemisk og perifer sirkulasjon. Den har en markert inotropisk og kronotropisk effekt (beta1-reseptor effekt) samt har effekt på beta-2-reseptorer, men påvirker ikke alfareseptorene. Dobutamin, som har en relativt kraftig beta-1-reseptorstimulerende effekt men liten effekt på beta-2- og alfareseptorer, kan også brukes. Transvenøs pacing vurderes hvis ingen effekt av ovenstående behandling.
Bradykardi
Bradykardi
Bradykardi
Hyperkalemi AV-knute hemmere
Væskeresuscitering. Vurderingen av væskestatus baseres på klinikk, biokjemi og bildediagnostikk (orienterende ekko: VCI, VV funksjon, UL pleura). Hvis pasienten er hypovolem , anbefales pH-veiledet væskeresuscitering (figur 4).
+
Sjokk
Behandling
B – Øke hjerefrekvens
Behandling
R – Øke perfusjon,væskeresuscitering
AV- knute-hemmere - pausere
B – Øke hjerefrekvens R – Øke perfusjon,væskeresuscitering
S – Øke blodtrykk, væskeresuscitering
AV- knute-hemmere
H – Redusere hyperkalemi
+
Hyperkalemi AV-knute hemmere
ACE/ARB Spironolakton
Pausering av legemidler. Legemidler som forverrer hyperkalemi, nyresvikt, og hemodynamiske parametre skal pauseres (AV knute hemmere, antihypertensiva, nefrotoksiner osv).
Sjokk
Nyresvikt
Behandling
B – Øke hjerefrekvens
R – Øke perfusjon,væskeresuscitering
S – Øke blodtrykk, H – Redusere hyperkalemi
Nyresvikt
Andre behandlingsmodaliteter kan bli aktuelle hvis man ikke oppnår effekt av overnevnte behandling. Det kan være aktuelt med akutt dialyse, reversering av AV-knute-hemmere, motgift mot digitalis osv. Det kan gis fludrokortison hvis pasient bruker ACE-hemmere. ACE-hemmere fører til at frisettingen av aldosteron reduseres, mens fludrokortison er syntetisk aldosteron med potent mineralkortikoid effekt. Den gir natrium og vannretensjon i nyrene, tap av kalium og magnesium og forhøyet blodtrykk pga. økt blodvolum og arterietonus.
AV- knute-hemmere - pausere
S – Øke blodtrykk, væskeresuscitering
H – Redusere hyperkalemi
i BRASH syndrom – oppsummering
Litteratur:
1) Farkas JD, Long B, Koyfman A, et al. BRASH syndrome: Bradycardia, Renal failure, AV-blockade, Shock, and Hyperkalemia. J Emerg Med 2020;59:216–223.
2) Aziz EF, Javed F, Korniyenko A, et al. Mild hyperkalemia and low eGFR a tedious recipe for cardiac disaster in the elderly: an unusual reversible cause of syncope and heart block. Heart Int 2011;6:e12–12.
3) Bailuni Neto JJ, de Lima Siqueira, B , Machado FC , et al. BRASH Syndrome: A Case Report. Am J Case Rep. 2022;23:e934600.
4) Diribe N., Le J.: Trimethoprim/sulfamethoxazoleinduced bradycardia, renal failure, AV-node blockers, shock and hyperkalemia syndrome. Clin Pract Cases Emergency Med 2019;3:282-285.
5) Flores S. Anaphylaxis induced bradycardia, renal failure, AV-nodal blockade, shock, and hyperkalemia: A-BRASH in the emergency department. Am J Emerg Med. 2020;38(9): 1987.e1-1987.e3.
6) Grigorov MV, Belur AD, Otero D, et al.. The BRASH
Konklusjon
BRASH syndrom kjennetegnes av refraktær bradykardi, og er et resultat av samspillet mellom AVknute-blokkere og hyperkalemi. Man må være spesielt oppmerksom hos pasienter som behadles med AVknute-blokkere og ACE-hemmere, som forskrives i økende grad til eldre pasienter. Opplæring av pasientene
syndrome, a synergistic arrhythmia phenomenon. Proc (Bayl Univ Med Cent) 2020;33(4):668–670.
7) Kazim YH, Farzin FJ, Kambal I, et al. The Role of Verapamil Toxicity in the Vicious Cycle of Bradycardia, Renal Failure, Atrioventricular Nodal Blockade, Shock, and Hyperkalemia (BRASH) Syndrome: A Case Report. Cureus. 2022;14(12):e32336.
8) Khan A, Lahmar A , Ehtesham M, et al. Bradycardia, Renal Failure, Atrioventricular-Nodal Blockade, Shock, and Hyperkalemia Syndrome: A Case Report. Cureus. 2022;14(3):e23486.
9) Pata R, Lutaya I, Mefford M, et al. . Urinary Tract Infection Causing Bradycardia, Renal Failure, Atrioventricular Nodal Blockade, Shock, and Hyperkalemia (BRASH) Syndrome: A Case Report and a Brief Review of the Literature. Cureus. 2022;14(8):e27641.
10) Prabhu V, Hsu E, Lestin S, et al. Bradycardia, renal failure, atrioventricular nodal blockade, shock, and hyperkalemia (BRASH) syndrome as a presentation of coronavirus disease 2019. Cureus. 2020;12:e7816.
om mulige medikament-bivirkninger og om at enkelte medisiner bør pauseres ved akutt sykdom, er viktig for å forebygge en potensielt alvorlig medikament-indusert tilstand som BRASH syndrom. Kjennskap til dette syndromet og til behandlingsvalg bedrer pasientens overlevelse og utfall.
11) Simmons T, Blazar E. Synergistic bradycardia from beta blockers, hyperkalemia, and renal failure. J Emerg Med 2019;57:e41–4.
12) Shah P, Silangruz K, Lee E, at al. Two Cases of BRASH Syndrome: A Diagnostic Challange. Eur J Case Rep Intern Med. 2022;9(4):003314.
13) Srivastava S, Kemnic T, Hildebrandt KR. BRASH syndrome. BMJ Case Rep 2020;13(2):e233825.
14) Takahashi K, Sakaue T, Uemura S, et al. Shock, and Hyperkalemia Syndrome as a Clinical Profile Leading to the Diagnosis of Transthyretin Amyloidosis: A Report of Two Cases. Cureus. 2022;14(5):e25444
15) Hanumanthu BKJ, Chugh Y, Grushko M, et al. Hyperkalemia presenting as sinus bradycardia, junctional rhythm and atrial bigeminy. Curreus 2019;11(12):e6439.
16) Shah P, Gozun M, Keitoku K, et al. Clinical characteristics of BRASH syndrome: Systematic scoping review. European Journal of Internal Medicine, 2022;103: 57-61.
Pasienter med utbredt kreft er sårbare for en rekke potensielt svært alvorlige komplikasjoner. Disse kan oppstå sekundært til kreftsykdommen i seg selv eller til kreftbehandlingen. Mange av tilstandene er vanlige i akuttmottaket (for eksempel infeksjoner og elektrolyttforstyrrelser) og håndteres antakelig bedre av indremedisinere enn av onkologer. Samtidig er det noen tilstander som er mer spesifikke for onkologien og sjeldnere forekommende. I disse tilfellene kan tiden være knapp og pasientene bør raskt komme til en onkologisk avdeling.
Forekomsten av kreft er økende, og om lag 100 personer får diagnosen hver dag. Tre av fire vil bli langtidsoverlevere (i live ≥ 5 år etter diagnose) og for noen kreftformer er overlevelsen tett på 100%. Blant pasienter som ikke blir kurert, lever stadig flere lengre med kreft, og mottar ulike former for systemisk kreftbehandling. Med immunterapiens inntog, ser vi nå undergrupper av pasienter med langvarige remisjoner (flere år). Indikasjoner for bruk av immunterapi og annen målrettet behandling øker stadig. Det er ikke lenger et likhetstegn mellom kreft med spredning og kort forventet levetid, og det legger føringer for «satsningsnivået» når disse pasientene får alvorlige komplikasjoner.
Både kreftsykdommen i seg selv og kreftbehandlingen gir økt risiko for komplikasjoner. Dette er pasienter som ofte har nedsatt reservekapasitet og organdysfunksjon, noe som gjør dem særlig sårbare for et alvorlig forløp. Primærsvulsten eller metastasene kan invadere kritiske strukturer (sentrale blodkar, CNS, luftveier, hjertet) og forårsake kompresjon,
trombose, økt trykk eller blødning. Kreftbehandlingen i seg selv kan gi immunsvikt, tumorlyse, autoimmunitet og benmargs- og nyresvikt, for å nevne noe. Når en pasient med utbredt kreftsykdom oppsøker akuttmottaket med nyoppståtte symptomer bør de vurderes raskt med henblikk på noen få akutte onkologiske tilstander der tiden kan være knapp og prognosen avhenger av rask diagnostikk og behandling. I denne oversikten nevnes tre slike tilstander, men listen er ikke uttømmende.
Malign medulla kompresjon (MMK) MMK er definert som malign tumorvekst fra corpus vertebrae eller omliggende strukturer med påfølgende trykk mot medulla spinalis. Vanligst lokalisasjon er thorakalcolumna, og prosessen kan medføre små blødninger, inflammasjon og ødem lokalt i området. Dette er en relativt vanlig tilstand hos pasienter med utbredt kreft; 3-5% av pasientgruppen utvikler dette i forløpet. MR er gullstandard for billeddiagnostikk og dette skal tas raskt ved nyoppstått nevrologi hos disse pasientene. Det kliniske bildet vil kunne variere fra kun radiologiske funn og asymptomatisk pasient, til fulminant paraplegi. Symptomene avhenger av affisert nivå i columna: Som regel opplever pasienten først smerter, deretter sensibilitetsutfall og til slutt motorisk affeksjon. Hvis nevrologiske symptomer vedvarer mer enn 72 timer, er det lite sannsynlig at pasienten vil gjenvinne funksjon. Første tiltak er å ringe til vakthavende onkolog ved nærmeste stråle-onkologiske senter. Ved OUS er det utarbeidet standardisert pasientforløp for MMK som ligger tilgjengelig på nett (eHåndbok Malign medullakompresjon (MMK) Standardisert pasientforløp (oushf.no)) hvor


håndtering og oppgavefordeling er detaljert beskrevet. Det understrekes at det er onkolog som har ansvar for å konferere med nevrokirurg. Ved MMK er det indikasjon for steroider (for eksempel deksametason 8 mg x 2 eller 16 mg x 1 / dag) som bør igangsettes umiddelbart etter at man ha konferert med onkolog. Det er sjelden at dette vil forkludre videre diagnostikk og det er viktigere å unngå permanente nevrologiske utfall. De fleste pasienter er ikke kandidater for kirurgi, og skal dermed ha strålebehandling mot affisert område, som regel 10 behandlinger med fotonbestråling (3 Gy x 10 til 30 Gy) som inneliggende pasienter. Unge pasienter med lite tumoraffeksjon (ett nivå), relativt god prognose (> 3 mnd forventet overlevelse) og intakt gangfunksjon kan vurderes for nevrokirurgi.
Vena cava superior syndrom (VCSS)
VCSS er definert som obstruksjon av blodstrømmen gjennom vena cava superior med påfølgende økende trykk i det venøse systemet og dannelse av kollateraler. Symptomer vil avhenge av hvor mye av lumen som er obstruert og hvor raskt tilstanden forverres. Noen pasienter er asymptomatiske, mens andre kan ha hevelse og rødme i ansikt og hals, struttende vener på hals og thorax og i verste fall tungpust, hoste og cyanose som tegn på respirasjonssvikt. Underliggende årsak er som regel malignitet (90%) og da fortrinnsvis fra primær utbredt lungekreft eller lymfom, eller metastaser til intrathorakale lymfeknuter. Tilstanden krever rask diagnostikk og skal utredes med CT thorax og man bør ha tett kommunikasjon med onkolog. Pasientene bør raskt få steroider (for eksempel deksametason 8 mg x 2 eller 16 mg x 1 / dag). Dersom det er mistanke
om nyoppstått primært lymfom bør man forsøke å sikre biopsi først, men ved livstruende symptomer skal behandling prioriteres. Noen vil ha behov for intensivbehandling grunnet respirasjonssvikt. Stentinnleggelse vil gi effektiv lindring av plagene for 90% av pasientene, og stråling og eventuelt annen systemisk kreftbehandling er aktuelt etterpå. I nasjonal faglig retningslinje for lungekreft er VCSS omtalt mer detaljert (Vena cava superior syndrom (VCSS) Stokes krage Helsedirektoratet
Immunterapi relatert toksisitet Indikasjonene for bruk av immunterapi øker stadig. Gruppen inkluderer først og fremst sjekkpunkt-hemmere og terapeutiske antistoffer, men også kreftvaksiner og CAR-T-behandling. For noen kreftformer er dette førstevalg i en metastatisk setting (blant annet lunge, malignt melanom, nyre), og prognosen har endret seg dramatisk for undergrupper av pasienter. Behandlingen, som primært er rettet mot T-celle funksjoner i kroppen, medfører også risiko for helt andre bivirkninger enn hva vi ser ved tradisjonell kreftbehandling. Disse kan oppstå når som helst i behandlingsforløpet (også etter seponering), og ramme i prinsippet alle organer i kroppen. Det er særlig kombinasjonsbehandling med monoklonale antistoffer som er forbundet med alvorlig autoimmunitet. Bivirkningene gir ofte inflammasjonsforandringer, antakelig på grunn av celledrapet i seg selv med medfølgende signalstorm i kroppen. Det er viktig for leger i akuttmottak å være oppmerksomme på disse tilstandene.
Immunterapi-relatert toksisitet graderes etter common terminology criteria for adverse events (CTCAE) fra 1-5 , der det vanligste er grad 1-2. Det er først og fremst hud, slimhinner og kjertelvev som rammes. Milde bivirkninger krever ikke seponering av behandlingen, for eksempel kløende dermatitt, akne eller mild diaré. 10% til 30% av pasientene vil oppleve grad 3-4 bivirkninger og 1-2% vil være fatale. CTCAE grad 2 og høyere vil medføre pausering eller seponering av behandlingen og det vil være indikasjon for immundempende behandling. Man bør konferere med onkolog før man igangsetter dette
fordi det vil i prinsippet redusere effekten av kreftbehandling.
Pneumonitt er den vanligste immunterapi-relaterte bivirkningen i luftveiene og karakteriseres av tungpust, irritasjonshoste og redusert allmenntilstand. Noen pasienter har feber. CT thorax vil kunne avdekke potensielt utbredte, heterogene forandringer forenelig med medikamentutløst inflammasjon. Tilstanden er sjeldnere enn forandringer i hud og slimhinner, men nevnes fordi det kan utvikle seg til lungesvikt og være dødelig. BAL bør utføres og pasienten trenger ofte høye doser steroider.

Det er steroider som er hjørnestenen i behandlingen av immunterapirelatert toksisitet når symptomene tilsier dette. Ofte må man opp i doser rundt 2-4 mg/kg kroppsvekt/per døgn. Fordi steroider også rammer T-celler involvert i eliminasjon av kreftceller, skal man raskt trappe dette ned når pasienten er bedre. Symptomer som er steroidresistente kan behandles med tillegg av andre immunsuppressiva som TNF-alfahemmere eller anti-interleukin-6, men da i tett samråd med onkolog. Norsk Legemiddelhåndbok har detaljert omtale av immunterapi relatert toksisitet (T2.1.3 Bivirkninger av immunterapi | Legemiddelhåndboka (legemiddelhandboka.no)
og European Society for Medical Oncology (ESMO) har publisert en
egen håndbok på temaet (Toxicities from Immunotherapy | ESMO
Oppsummering
Moderne kreftbehandling gjør at mange pasienter lever med utbredt kreftsykdom over lang tid. Disse pasientene er av ulike grunner sårbare for alvorlige komplikasjoner, på grunn av sykdommen i seg selv eller behandlingen. Noen av disse komplikasjonene, slik som MMK, VCSS og immunterapi-relatert toksisitet, krever rask onkologisk håndtering, for at utfallet skal bli så godt som mulig. Da er vi avhengig av et god samarbeid på tvers av spesialitet og sykehus.
Det er ikke lenger slik at utbredt kreftsykdom i seg selv er ensbetydende med kort forventet levetid, og satsningsnivå for behandling av akutte komplikasjoner må ta høyde for dette. Når det er sagt, så er særlig MMK og VCSS forbundet med alvorlig prognose, og i visse tilfeller vil det være mest riktig å gjøre minst mulig utover optimal symptomlindrende behandling.
Fordi bruken av immunterapi og annen målrettet behandling øker, vil pasienter med immunrelatert toksisitet blir vanligere å se i akuttmottaket. Det er vel verdt tiden å gjøre seg kjent med denne formen for kreftbehandling og hvordan bivirkninger kan arte seg og best håndteres.
Kilder:
Kreft i Norge (kreftregisteret.no)
eHåndbok - Malign medullakompresjon (MMK)
- Standardisert pasientforløp (oushf.no)
Vena cava superior syndrom (VCSS)
- Stokes krageHelsedirektoratet
T2.1.3 Bivirkninger av immunterapi | Legemiddelhåndboka (legemiddelhandboka.no)
De siste par år har vi opplevd et paradigmeskifte i behandling av cystisk fibrose. En ny medisin beskrives som årsakskorrigerende for en arvelig sykdom. Effekten er så stor at den også har blitt omtalt som mirakelbehandling.
Cystisk fibrose (CF) er vår vanligste arvelige sykdom. Så når under 400 mennesker i Norge har denne diagnosen, forteller det noe om alvoret og hvordan sykdommen påvirker livslengden. Vi skal ikke mer enn noen tiår tilbake før CF ble oppfattet som en barnesykdom siden så få overlevde til voksen alder.
Sykdommen er forårsaket av mutasjon i genet CF transmembran konduktansregulator (CFTR), som koder for en klorkanal i cellemembranen. I dag får de fleste diagnosen i spedbarnsalder siden de vanligste mutasjonene er inkludert i nyfødtscreeningprogrammet. For dem som ikke fanges opp med testen, brukes svettetest hvor kloridinnholdet i svetten er diagnostisk ved verdier >60 mmol/L. Man supplerer med gentest ved gjentatte verdier over denne grense.
Personer med CF produserer ikke nok CFTR klorkanaler, eller de virker ikke som de skal. Dette gir opphopning av seigt slim fra slimproduserende kjertler. I lungene gir dette utslag i slimstagnasjon, økt infeksjonstendens, inflammasjon og utvikling av de cystiske bronkiektasiene som har gitt navn til sykdommen (bilde). Etter hvert faller lungefunksjonen, og det er særlig lungesykdom som begrenser livslengden.

Slimplugging i bukspyttkjertelen kan funksjonelt i stor grad oppveies med substitusjon av pankreasenzymer, men næringsopptaket blir dårligere og alle bør få tilskudd av fettløselige vitaminer. Vevsskade i bukspyttkjertelen av fordøyelsesenzymer som fanges i utførselsgangene gjør
at mange med tiden utvikler en insulinkrevende diabetes.

God behandling har bedret overlevelse betraktelig. Omfattende slimmobilisering er hjørnestein i behandlingsstrategi - det seige slimet må opp og ut. Pasienter med CF har lange egenbehandlingsøkter hvor de inhalerer slimløsende midler som dornase alfa og hypertont saltvann etterfulgt av øvelser og lungefysioterapi. De behandles aggressivt med antibiotika for erradikering av luftveisinfeksjoner eller for suppresjon av luftveispatogene bakteriene når dette ikke lykkes. Disse tiltakene har hevet den forventede levealderen betraktelig, fra barneår til det den er i dag, rundt 50 år. Dette er fortsatt over 3 tiår kortere enn befolkningen ellers. Noen dør ung, mens den eldste i landet med CF har blitt over 80 år.
Denne store variasjonen skyldes delvis at noen mutasjoner i CFTR genet er alvorligere enn andre. Samtidig ser man også at to personer med samme genmutasjoner kan ha ulik sykdomsbyrde. Dessuten vil det alltid svære forskjeller fra person til person i hvor mye innsats de klarer legge i egenbehandling og fysisk aktivitet.
Genmutasjonen som dominerer i Norge er F508del, en alvorlig mutasjon som gir minimal funksjon av klorkanalen. 83% har en slik mutasjon og nær halvparten er homozygote [1]. I november 2019 ble det publisert en banebrytende studie i New England Journal of Medicine som viste frapperende effekt av Kaftrio og Kalydeco gitt til pasienter med F508del mutasjon [2]. Medisinkombinasjonen øker mengden CFTR
klorkanaler som når celleoverflaten istedenfor å bli prosessert i cellen som defekt protein og sørger for at klorkanalen virker bedre ved at den klarer holde seg åpen større del av tiden. Sammenlignet med placebo fikk pasientene på Kaftrio og Kalydeco bedring av lungefunksjon, estimert ved forsert ekspirasjon ved 1 sekund (FEV1) på 14 %, en reduksjon av årlige forverringer på 63% og en signifikant forbedret livskvalitet målt ved Cystic Fibrosis Questionnaire - Revised. Ved svettetest som brukes diagnostisk for sykdommen, observerte man en gjennomsnittlig reduksjon på 42 mmol/L sammenlignet med placebo til et nivå under diagnostisk grense. Dette har ført til at man omtaler behandlingen som årsakskorrigerende.
I Danmark, hvor man raskt tok i bruk behandlingen i form av legemidlene Kaftrio og Kalydeco, kunne man bekrefte resultater i klinisk virksomhet på linje med studien, og man opplevde bedring på de fleste områder. Flere av pasientene som hadde vært så dårlige at de sto i kø for lungetransplantasjon opplevde så stor bedring at de ble tatt av listen [3].
I Norge ble det initialt gitt avslag på refusjonsøknaden, hovedsakelig begrunnet i pris hvor legemiddelselskapet Vertex initialt hadde lagt seg på et prisnivå på nesten 2,9 millioner kroner for ett års behandling, og at forhandlinger ikke hadde ført til enighet.
Skuffelsen var derfor stor både for pasientforeningen og for miljøet som behandler disse pasientene. Avslaget var absolutt og uten unntak, selv ikke
for pasienter i transplantasjonskø eller for pasienter med tilsvarende alvorlig sykdom som hadde kontraindikasjoner mot lungetransplantasjon. På samme tid viste estimater fra kanadiske forskere at de nye medisinene reduserte dødelighet i CF befolkningen med hele 15% og økte overlevelsen med 9 år i snitt [4].
Pasientforeningens ansikt utad i denne saken har vært Christian Lawley som høsten 2021 startet digital pengeinnsamling under beskrivelsen: «Hjelp Christian med å få tilgang til livreddende medisiner!». På få måneder klarte han få inn den svimlende summen det kostet for 3 måneders behandling på hvit resept. Aksjonen var koordinert med mediaoppslag i TV og de større avisene. Dette ga betydelig politisk oppmerksomhet i forkant av neste metodevurdering. Hvorvidt mediapress og trykk fra opposisjonspolitikere hadde påvirkning på beslutningsprosessen, er ukjent, men april 2022 snudde beslutningsforum, og kombinasjonsbehandling med Kaftrio og Kalydeco ble godkjent fra 1. juni 2022 [5].
Resultater
Erfaring fra behandling i Norge er begrenset da det bare er ett halvt år siden det ble mulig å skrive ut disse medikamentene, men som følge av aksjonen Christan satte i gang, har han brukt årsakskorrigerende behandling i over ett år. Resultatene som presenteres her viser effekt og toleranse som en kasuistikk.
Christian ble født i 1982, lenge før CF ble inkludert i nyfødtscreeningprogrammet. Diagnosen ble stilt i 6 års alder på grunnlag av luftveisplager. Christian er betydelig mer fysisk aktiv enn de fleste. Han ble norgesmester i bodyfitness i 2005. De senere år har han fokusert på kondisjonsidrett med løping og sykling for å holde seg frisk og arbeider som personlig trener og foredragsholder. Christian startet behandling med Kaftrio og Kalydeco på eget initiativ før en organisert protokoll for innføringen av behandling hadde blitt satt opp. Det ble derfor ikke utfylt livskvalitetsspørreskjema i forkant,
men en rekke tester ble gjort både før og etter oppstart.
En rekke effekter er beskrevet av årsakskorrigerende behandling i oppfølgingsstudier, opplevde du noen umiddelbare effekter den første tiden etter du startet på Kaftrio og Kalydeco?
– Et par timer etter første dose kjente jeg igjen følelsen fra oppstart av Orkambi*. Jeg merket endringer i lungene etter bare 4 5 timer. Ved første “hoste anfall” etter oppstart kom slimet overraskende lett opp, men den største endringen kom en times tid etter kveldsdosen, da rant slimet enkelt opp fra lungene. Og neste dag når jeg bøyde meg fram for å knyte skolissene, regelrett rant slimet opp fra lungene og i munnen min. I løpet av de tre første dagene kom det nærmere 5 6 dl slim fra lungene uten at jeg måtte hoste eller drenere.
*En tidligere CFTR modulerende behandling med virkestoffene Lumakaftor og Ivakaftor.
Var det uproblematisk å starte behandling, eller opplevde du noen plagsomme bivirkninger av medisinen etter oppstart?
– Jeg fikk magesmerter og kontaktet CF poliklinikken, som skrev ut Movicol (mot forstoppelse). Buktrykket varte i 2 3 dager etter oppstart av Movicol.
Effekt på lungefunksjon og svetteklorid
Lungefunksjon målt ved FEV1 økte fra 1,62 L til 1,98 L (22% forbedring) og FVC økte fra 3,35 til 3,93 L (17 % forbedring). Gassdiffusjon (DLCO) var normal før oppstart, en ikke-signifikant økning ble sett fra 9.25 til 10.04 mmol/(min*kPa). Ved ergospirometri økte det maksimale oksygenopptaket, V’O2 max/kg fra 33,7 til 42,0 mL/min/kg, (25% forbedring), figur 1. Svetteklorid falt fra 106 mmol/L til 47 mmol/L, tabell 1 og figur 2.
Diskusjon
Denne kasuistikken beskriver effekten av årsakskorrigerende behandling med Kaftrio og Kalydeco hos
forsert ekspirasjon ved 1 sekund. FVC, forsert vitalkapasitet. DLCO, diffusjonskapasitet for karbonmonoksid. TLC, total lungekapasitet. Prosent av forventningsverdi angitt i parentes.
medforfatter av artikkelen. Christian opplevde en 22% økning av FEV1 på beste spirometri tatt etter behandlingsstart sammenlignet med spirometrien før behandlingsstart. Dette er mer enn den gjennomsnittlige dokumenterte effekten. Enda større forskjell ble sett på maksimalt oksygenopptak, V’O2 maks som steg hele 25%. Maksimalt oksygenopptak angir det maksimale oksygenforbruket ved maksimal belastning og er avhengig av fysisk kondisjon. En endring i lungefunksjon med bedring i FEV1 vil dermed alene ikke kunne forklare en
Referanser
1. Årsrapport 2021 fra Nasjonalt medisinsk kvalitetsregister for cystisk fibrose. Norsk senter for cystisk fibrose, 2021.
2. Middleton, P.G., et al., Elexacaftor-TezacaftorIvacaftor for Cystic Fibrosis with a Single Phe508del Allele. N Engl J Med, 2019. 381(19): p. 1809-1819.
3. Sjøgren, K. Læger måber over ny behandling af
slik forskjell, men krever en betydelig treningsinnsats. Christian beskriver det på denne måten:
Uken før oppstart av Kaftrio/ Kalydeco klarte jeg jogge i 2 min i rolig joggetempo, tilsvarende 7,5 min/ km før jeg måtte hoste og få tilbake pusten. Etter 5 dager kunne jeg løpe 16 minutter uavbrutt i 6 min/km. Da deltok jeg på trappeløpet opp Ulriken og gjorde to «løp» opp Oppstemten. I tiden etter oppstart har jeg kunnet løpe intervaller raskere enn noen gang tidligere i livet mitt. Den 15.
september 2022 deltok jeg i Bergen City Milen og løp 10 km på 52,5 min, raskere enn noen gang tidligere.
Svetteklorid falt 56%, fra et høyt nivå til like under diagnostisk grense. Det er fortsatt et stykke ned til normalområdet for friske personer som regnes <30 mmol/L. Disse dramatiske forskjellene hos Christian ble sett på tross av at han allerede før oppstart sto på CFTR modulerende behandling med Lumakaftor og Ivakaftor i form av Orkambi. Ved overgang til Kaftrio/Kalydeco ble tidligere CFTR modulerende behandling seponert. Medikamentet har vært bra tolerert med unntak av forbigående magesmerter og forstoppelse som krevde behandling
Konklusjon
Effektstudier på gruppenivå har vist betydelig effekt av årsakskorrigerende behandling ved cystisk fibrose på lungefunksjon, livskvalitet og mortalitet. Denne kasuistikken beskriver frapperende effekt på lungefunksjon og en svær forbedring i maksimalt oksygenopptak med denne behandling. De store endringene ble sett på tross av at han allerede brukte en annen type CFTR modulerende behandling før oppstart. Kombinasjonsbehandling med eleksakaftor, tezakaftor og ivakaftor regnes som årsakskorrigerende, og svetteklorid fungerer som markør på funksjonen til CFTR klorkanalen. På gruppenivå håper vi å se det samme som ble observert i Danmark, at innføring av behandlingen fjerner denne pasientgruppen fra transplantasjonskøen Vi er spent på hva behandlingen kan gjøre med forventet levealder for denne pasientgruppen i årene som kommer.
cystisk fibrose. Dagens Medicin. 01.10.2021; Available from: https://dagensmedicin.dk/laeger-maaber-overny-behandling-af-cystisk-fibrose/.
4. Stanojevic, S., et al., Projecting the impact of delayed access to elexacaftor/tezacaftor/ivacaftor for people with Cystic Fibrosis. J Cyst Fibros, 2021. 20(2): p. 243-249.
5. Mack, A. and A.M. Ringerud. Notat: ID2020_029:
Eleksakaftor/tezkaftor/ivakaftor (Kaftrio) til kombinasjonsbehandling av cystisk fibrose hos pasienter ≥12 år som har minst én F508del-mutasjon i cystisk fibrose transmembran konduktansregulator (CFTR)-genet, uavhengig av mutasjonsstatus i det andre allelet. 21. April 2022; Available from: https://nyemetoder.no/
Documents/ID2020_029%20Kaftrio+Kalydeco_CF_ Prisnotat2_offentlig.pdf.
E1912 studien inkluderte 529 tidligere ubehandlede pasienter yngre enn 70 år randomisert 2:1 mellom behandlingsarmene Ibrutinib+R og FCR. Ibrutinib ble administrert «en gang daglig» i tillegg til 6 sykluser initialt med rituximab.
av pasientene med umutert IGHV har ikke progrediert på Ibrutinib + R etter 5,8 års median oppfølging vs 33 % for pasienter behandlet med FCR
Umutert IGHV
Totaloverlevelsen i studien var signifikant høyere i Ibrutinib gruppen vs FCR, en forskjell mellom gruppene på
53%
HR = 0,27, (95% Cl: 0,18–0,41) p<0,0001

5-year rates: 75%, 33%
FCR (42 events/71 cases) IR (56 events/210 cases)
UTVALGT PRODUKT-OG SIKKERHETSINFORMASJON
INDIKASJONER:
Som monoterapi til behandling av voksne med residiverende eller refraktær mantelcellelymfom (MCL). Som monoterapi eller i kombinasjon med rituksimab eller obinutuzumab eller venetoklaks til behandling av voksne med tidligere ubehandlet kronisk lymfatisk leukemi (KLL). Som monoterapi eller i kombinasjon med bendamustin og rituksimab (BR) til behandling av voksne med KLL som har fått minst én tidligere behandling. Som monoterapi til behandling av voksne med Waldenströms makroglobulinemi (WM) som har fått minst én tidligere behandling, eller som førstelinjebehandling hos pasienter som ikke er egnet for kjemoimmunterapi. I kombinasjon med rituksimab til behandling av voksne med WM.
DOSERING OG ADMINISTRASJONSMÅTE:
Behandlingen skal innledes av og gjennomføres under tilsyn av lege med erfaring i bruk av legemidler mot kreft. Behandlingen skal fortsette til sykdomsprogresjon eller til pasienten ikke lenger tolererer den. Mantelcellelymfom (MCL): Voksne: Anbefalt dose er 560 mg 1 gang daglig. Kronisk lymfatisk leukemi (KLL): Voksne: Anbefalt dose, enten som monoterapi eller i kombinasjon, er 420 mg 1 gang daglig. Waldenströms makroglobulinemi (WM): Voksne: Anbefalt dose er 420 mg 1 gang daglig. Ved kombinasjon med anti-CD20-behandling, anbefales det å gi ibrutinib før anti-CD20-behandling når de gis på samme dag.
FORSIKTIGHETSREGLER:
Blødningsrelaterte hendelser:
• Spesiell forsiktighet ved antikoagulasjonsbehandling.
• Warfarin/vitamin K-antagonister skal ikke gis samtidig med IMBRUVICA, og fiskeolje og vitamin E-preparater skal unngås. Atrieflimmer/-flutter, ventrikulær arytmi eller hjertesvikt:
• Ved eksisterende atrieflimmer som krever antikoagulasjonsbehandling bør oppstart med andre behandlingsalternativer vurderes.
• Ved eksisternede relevante risikofatorer for hjertehendelser, eller utvikling under behandling, bør nytte/risiko evalueres, og andre alternativer eller samtidig antikoagulasjonsbehandling vurderes.
• Ved tegn/symptomer på ventrikulær takyarytmi skal behandling midlertidig seponeres.
• Ved grad 2 hjertesvikt skal IMBRUVICA holdes tilbake inntil hjertehendelser når grad 1 eller baseline verdier.
Virusreaktivering:
• Hepatitt B-virus (HBV)-status bør fastslås før behandlingsoppstart. Ved positiv hepatitt B-serologi, bør pasienten overvåkes og behandles for å forebygge hepatitt B-reaktivering.
janssen.som/norway
Janssen-Cilag AS, Drammensveien 288, 0283 Oslo
telefon: + 47 24 12 65 00
mail: jacno@its.inj.com
Probability
HR = 0,47, (95% Cl: 0,25–0,89) p<0,018 5-year rates: 95%, 89%
FCR (18 events/175 cases) IR (21 events/354 cases)
BIVIRKNINGER:
• Vanligste bivirkninger (≥ 20 %): Artralgi, blødninger, blåmerker, diaré, kvalme, muskel-skjelettsmerter, nøytropeni, trombocytopeni, øvre luftveisinfeksjon og utslett
• Vanligste grad 3/4 bivirkninger (≥5%): Hypertensjon, lymfocytose, nøytropeni, pneumoni og trombocytopeni.
INTERAKSJONER OG DOSEJUSTERING:
Samtidig bruk av moderate til sterke CYP 3A4-hemmere/-induktorer kan gi hhv. økt eller redusert eksponering for IMBRUVICA, og dosejustering eller midlertidig seponering kan være nødvendig.
KONTRAINDIKASJONER:
Preparater som inneholder johannesurt.
PAKNINGER, PRISER OG REFUSJON:
Pakninger og priser: 140 mg: 28 stk.1 (endose) 19 576,60. 280 mg: 28 stk.1 (endose) 39 117,00. 420 mg: 28 stk.1 (endose) 58 657,30. 560 mg: 28 stk.1 (endose) 78 197,70.
Refusjon: 1H-resept: L01E L01_1 Ibrutinib.
Refusjonsberettiget bruk:
Der det er utarbeidet nasjonale handlingsprogrammer/nasjonal faglige retningslinjer og/eller anbefalinger fra RHF/LIS spesialistgruppe skal rekvirering gjøres i tråd med disse.
Vilkår: 216 Refusjon ytes kun etter resept fra sykehuslege eller avtalespesialist.
Basert på SPC godkjent av SLV/EMA: 11/2022
CP-362506
Referanser 1. 1. Ref 1. Shanafelt T et al. Long-term outcomes for ibrutinib-rituximab and chemoimmunotherapy in CLL: updated results of the E1912 trial Blood 2022 Jul 14;140(2):112-120.
En rekke studier tyder på at 10-80 % av alle pasienter med corona virus disease 2019 (covid-19) kan ha vedvarende symptomer måneder etter den opprinnelige infeksjonen («long covid») (1, 2). Flere definisjoner av post-covid-19 brukes. Post-akutt covid-19-syndrom som en enhet omfatter to undergrupper:
1. «Long covid»: vedvarende symptomer (tilstede eller ikke ved infeksjonsstart) etter 4 ukers infeksjon, med et permanent, tilbakefallene/remitterende eller progressivt bedringsforløp.
2. Følgetilstander: irreversibel vevsskade etter 12 uker som kan utløse ulike grader av permanent dysfunksjon og tilhørende symptomatologi.
I denne artikkel beskrives de langsiktige effektene på hjertet i hvile og på hjerte- og lungefunksjonen under belastning. I forbindelse med pandemien ble det startet en norsk multisenterstudie, PROLUN, som omfatter 6 sykehus hvor alle pasienter som vært innlagt med covid-19 fra februar til juni 2020, ble spurt om deltakelse 3 og 12 måneder etter utskrivelsen (3). Jeg var prosjektleder for hjerte-substudien hvor pasientene ble undersøkt med ekkokardiografi, 24-timers EKG og kardiopulmonal belastningstest (cardiopulonary exercise test (CPET))(4, 5). Tolv måneders data er ikke publisert ennå, og resultatene er derfor ikke inkludert her.
Mekanismer som bidrar til patofysiologien til postakutt covid 19 Covid-19-pandemien er forårsaket av det nye koronaviruset SARS-CoV-2 (6). Det finnes flere varianter av SARS-CoV-2, og viruset er i stadig endring. Delta-varianten og tidligere varianter rammer i hovedsak nedre luftveier, mens omikron-varianten rammer øvre luftveier.
SARS-CoV-2 binder seg til angiotensin-konverterende enzym 2 (ACE2) gjennom det reseptorbindende domenet til spikeproteinet. ACE2reseptorer finnes på celleoverflater og er utbredte i hjertet, nyrene og lungene. ACE2 er en nøkkelregulator av renin-angiotensin-aldosteronsystemet (RAAS). SARS-CoV-2 nedregulerer ACE2 og fører til en ubalanse i ACE/ACE2-forholdet og en dysregulering av RAAS som til slutt fører til covid-19-progresjon (7). Pasienter med komorbiditeter med kronisk endoteldysfunksjon, som hypertensjon, diabetes mellitus og kardiovaskulær sykdom, er spesielt
utsatte (7). SARS-CoV-2 kan forverre disse tilstandene på grunn av endotelitt, apoptose og infiltrasjon av lymfocytter og mononukleære celler (8).

I lungene er det både virusavhengige mekanismer (inkludert invasjon av alveolære epitel- og endotelceller av SARS-CoV-2) og virusuavhengige mekanismer (immunologisk skade, inkludert perivaskulær inflammasjon) som bidrar til nedbrytningen av endotel-epitelbarrieren (9). I alveolene skjer en invasjon av monocytter og nøytrofile granulocytter i tillegg til ekstravasering av et proteinrikt eksudat. Etter den akutte infeksjonen kan det utvikles lungefibrose. Cytokiner som interleukin-6 (IL-6) og transformerende vekstfaktor beta (TGF- β), er sentrale i febroseutviklingen (10).
De kardiovaskulære mekanismene som bidrar til post-akutt covid-19, inkluderer direkte viral invasjon, nedregulering av ACE2, inflammasjon og den immunologiske responsen
som påvirker myokard, perikard og ledningssystemet. Covid-19 kan også føre til arytmier på grunn av en økt katekolaminerg tilstand på grunn av cytokiner som IL-6, IL-1 og tumor nekrosefaktor (TNF), som kan forlenge ventrikulære aksjonspotesialer ved modulering av ionekanaler i kardiomyocyttene (11). Autonom dysfunksjon etter virussykdom med adrenerg stimulering kan resultere i posturalt ortostatisk takykardisyndrom (POTS) og uhensiktsmessig sinustakykardi (12).
Symptomer, komplikasjoner og diagnostiske funn etter covid 19infeksjon
Ett år etter mild til alvorlig covid-19 fant man i en tysk studie at bare 23 % av pasientene var helt symptomfrie, og de hyppigste symptomene var redusert fysisk kapasitet (56 %), tretthet/slapphet (53 %), dyspné (38 %), konsentrasjonsproblemer (40 %), problemer med å finne ord (32 %) og søvnproblemer (26 %) (13). Dette var imidlertid uvaksinerte pasienter som hadde en såpass kraftig
infeksjon at de var undersøkt på et universitetssykehus, enten innlagt eller poliklinisk, dvs. at disse tallene ikke er representativ for alle med covid-19. 28 % hadde alvorlig eller kritisk sykdom, og kun 15 % hadde mild sykdom. Studieresultatene var basert på svar fra spørreskjemaer om symptomer og er ikke bevis på at symptomene skyldes covid-19.
Det ble nylig publisert en studie med data fra et tilfeldig samfunnsbasert utvalg av 600 000 individer i England med selvrapporterte symptomer 3 måneder etter covid-19 (13b). Siden mange av symptomene er vanlige og ikke spesifikke for covid-19, ble estimatene sammenlignet med det som ble funnet i den generelle befolkningen fra personer som testet negativt i en annen studie. I clusteranalyser fant man at de vanligste symptomene var tretthet, dyspné og brystsmerter.
Lungesymptomer, komplikasjoner og diagnostiske funn
Lungen er det organet som primært er affisert ved alvorlig covid-19, og følgelig er luftveissymptomer og redusert fysisk kapasitet utbredt etter alvorlig covid-19. De hyppigste lungesymptomene etter en covid-19 er dyspné (33 %), hoste (22 %) og brystsmerter (30 %) (13). Redusert distanse ved 6 minutters gangtest (6 MWT) ble funnet hos én fjerdedel av pasientene etter 6 måneder (14).
Omtrent 50 % av 349 pasienter som gjennomgikk høyoppløselig CT thorax (HRCT) 6 måneder etter sykehusinnleggelse pga. covid-19, hadde mattglassfortetninger og redusert diffusjonskapasitet i en kinesisk studie (14). I PROLUN fant man 3 måneder etter utskrivelse for covid-19 at en fjerdedel av deltakerne hadde CT-endringer med mattglassfortetninger og redusert diffusjonskapasitet (15).
I en metaanalyse og oversiktsartikkel som inkluderte 48 000 pasienter med mild til alvorlig covid-19 fant man dyspné hos 24 %, redusert diffusjonskapasitet hos 10 % og lungefibrose hos 5 % av pasientene (1). Det er dog store variasjoner i litteraturen vedrørende lungefibrose. Alvorlighetsgraden av covid-19-pneumoni virker ha betydning for risiko for vedvarende diffusjonssvikt og lungefibrose.
Selv om risikoen for lungeemboli øker ved covid-19, er den langsiktige risikoen for kronisk lungeembolisme og påfølgende pulmonal hypertensjon ukjent på dette tidspunktet.

Kardiologiske symptomer og komplikasjoner (figur 1)
Palpitasjoner og arytmier Palpitasjoner er vanlig blant pasienter som kan ha senkomplikasjoner etter covid-19 (10-60 %). De kan skyldes
sinustakykardier eller supraventrikulære eller ventrikulære arytmier. Disse symptomene må vurderes nøye ettersom de er en hyppig årsak til forespørsler om medisinsk hjelp (16).
Brystsmerter
Brystsmerter er et annet symptom som er vanlig etter covid-19 (12-44 %) og kan gå sakte over (17). Etter et år hadde 7 % brystsmerter i en stor kinesisk studie (18). Brystsmerter etter covid-19 kan ha ikke-kardiale årsaker som myalgi, pleuritt og lungemboli. Kardiale årsaker kan være sekvele etter perikarditt, myokarditt, hjerteinfarkt (type 1 og 2) og takotsubo-syndrom. Imidlertid er det rapportert at det ikke var påvisbare vedvarende kardiovaskulære abnormiteter målt med magnetresonanstomografi (MR) 6 måneder etter mild infeksjon med SARS-CoV-2 sammenlignet med matchede kontrollpersoner (19).
Dyspné
Dyspné ved belastning er en av de vanligste symptomene etter covid-19. I PROLUN hadde 50 % av pasientene dyspné 3 måneder etter utskrivelse fra sykehus (4). En stor spansk multisenterstudie fant dyspné ved aktivitet hos 55% av tidligere innlagte pasienter sju måneder etter utskrivning fra sykehus (3). En norsk studie fant dyspné hos 16 % 1,5-6 måneder etter symptomdebut hos ikke-innlagte personer (20).
Det er en dårlig sammenheng mellom dyspné og lungefunksjon i hvile etter covid-19. Dyspné kan ha respiratorisk, sirkulatorisk og perifer årsak, i tillegg til at en rekke ikke-fysiologiske faktorer kan bidra, inkludert emosjonelle, miljømessige, kulturelle og sosiale faktorer (21). CPET er gullstandard for å finne årsak til dyspné. Flere CPET-studier, inklusive vår, har vist at den vanligste årsaken til dyspné etter covid-19 er dekondisjonering (5).
Autonom dysfunksjon
Når overdreven ortostatisk takykardi og symptomer på ortostatisk intoleranse har vart i minst tre måneder etter infeksjon med covid-19, har man post-covid-19 posturalt takykardisyndrom (POTS). En rekke kasusrapporter har nylig beskrevet pasienter som utviklet POTS etter SARS-CoV2-infeksjon. Foreløpig er lite kjent vedrørende patofysiologien og det naturlige forløpet til post-covid-19 POTS (22). Fordi den autonome dysfunksjonen er et så stort problem etter covid-19 har flere land opprettet dysautonomi-poliklinikker, en poliklinisk henvisningsklinikk for pasienter med vedvarende nevrologiske og kardiovaskulære plager etter covid-19.
Kardiale funn og diagnostikk
Hjertefunksjon i hvile (ekko og MRfunn)
Ekkokardiografi
I PROLUN sammenlignet vi ekkokardiografi av 204 pasienter 3 måneder etter sykehusinnleggelse pga. covid-19 med 204 matchede kontroller fra HUNT-4 (4). Vi fant lett høyre ventrikkeldysfunksjon og i tillegg lett diastolisk dysfunksjon hos halvparten av pasientene som hadde hatt covid-19 (4). Den lette høyre ventrikkeldysfunksjonen er sannsynligvis assosiert med lungepatologi. Venstre ventrikkeldysfunksjon er mindre vanlig etter covid-19.
Halvparten av pasientene hadde vedvarende dyspné, og nesten to tredjedeler hadde fatigue tre måneder etter sykehusinnleggelse pga. covid-19. Disse symptomene var dog ikke assosiert med ekkokardiografiske målinger av hjertefunksjonen. Det var svake
bevis i vår studie for at pasienter med intensivbehandling hadde redusert høyre ventrikkel- strain enn dem uten intensivbehandling.
En annen studie med pasienter med alvorlig covid-19 behandlet på intensivavdeling viste høyere forekomst av lungevaskulære defekter, noe som førte til pulmonal hypertensjon og påfølgende høyre ventrikkeldysfunksjon (23). I den akutte og subakutte settingen kan måling av NT-proBNP være mer følsom for økt høyre ventrikkelstrekk sekundært til lungepatologi enn troponinutslipp. Dette kan delvis forklare den nærmere assosiasjonen som er observert mellom NT-proBNP og høyre ventrikkel- strain enn mellom troponin og høyre ventrikkel- strain Økt afterload og forhøyet pulmonalt arterielt trykk kan påvirke vurderingen av høyre ventrikkelfunksjon. Høyre ventrikkeldysfunksjon hos pasienter med covid-19 kan derfor reflektere nedsatt lungefunksjon og ikke myokardfunksjon. Vi fant ikke noen sammenheng mellom redusert venstre ventrikkel global longitudinell strain (GLS) og sykdomsgrad (behandling ved intensivavdeling) eller forhøyet høysensitiv troponin etter 3 måneder.
En prospektiv multisenterstudie viste også en høy grad av diastolisk dysfunksjon (55 %) tre måneder etter covid-19 (24).
Tangen et al. fant redusert hjertefunksjon ved ekkokardiografi hos et mindretall av 92 covid-19-pasienter tre måneder etter sykehusinnleggelse (25). Venstre ventrikkel GLS var redusert hos 15 % av pasientene, men de hadde normal høyre ventrikkel- strain. Pasienter med komorbiditeter var inkludert.
Et år etter sykehusinnleggelse pga. covid-19 viste en annen studie av pasienter uten kjente hjerte- og karsykdommer eller lungesykdommer vedvarende dyspné hos en tredjedel som var assosiert med subklinisk myokarddysfunksjon (26). Av totalt 66 pasienter rapporterte 35 % dyspné. Venstre ventrikkels ejeksjonsfraksjon var ikke signifikant forskjellige hos pasienter med eller uten dyspné. Pasienter med dyspné hadde lavere venstre ventrikkel-GLS, global
contructive work (GCW) og global work index (GWI) sammenlignet med asymptomatiske pasienter. GCW og GWI var omvendt og uavhengig assosiert med dyspné. GCW og GWI var de eneste ekkokardiografiske parameterne som var uavhengig assosiert med symptomer, noe som artikkelforfatterne konkluderer med skyltes reduksjon i myokardytelse og subklinisk hjertedysfunksjon. Myocardial work (MW) er en ny klinisk metode som er mindre loadavhengig, for kvantifisering av regional og global venstre ventrikkelfunksjon basert på strain og arterielle blodtrykkskurver (27). Begrensingene med studien er at ekkokardiografi under sykehusinnleggelse kun ble utført i utvalgte tilfeller på grunn av logistiske begrensninger ved begynnelsen av pandemien. I tillegg er dette en singlesenter-studie.
I en annen singlesenter-studie fra Wuhan i Kina fant man at covid19-overlevende, inkludert dem med signifikant forhøyet troponin I ved innleggelse og dem med alvorlige og kritiske sykdom, ikke hadde tydelige ekkokardiografiske tegn på redusert hjertefunksjon ett år etter diagnosen (28).
MR av hjertet
I en norsk studie blant 58 uselekterte pasienter innlagt på sykehus pga. covid-19 fant Myhre et al. at hjertepatologi på MR var tilstede hos 12 (21 %) av pasientene etter 6 måneder (29). MR-funn korrelerte ikke med alvorlighetsgraden av sykdommen. Man fant ingen sammenheng mellom markører for sykdommens alvorlighetsgrad under indekssykehusinnleggelsen og patologi på MR etter 6 måneder. Blant pasienter med moderat til alvorlig covid-19 fant Myhre og kolleger en betydelig lavere forekomst av patologi på MR enn i en tysk studie av Puntmann et al. (30). De rapporterte patologiske funn 10 uker etter den akutte infeksjonen hos 78 av de 100 pasientene som hadde overveiende mild til moderat covid-19. Samme studie identifiserte fokal arrdannelse hos 32 % og perikardfortykkelse hos 22 %. De rapporterte også forhøyede T1- og T2-verdier, sensitive mål for myokardfibrose og ødem, sammenlignet med friske og risiko-matchede kontroller. Denne
studie har dog vært mye omdiskutert i forhold til deres MR-diagnostikk. En kinesisk studie vurderte retrospektivt 26 pasienter som ble henvist til MR for hjertesymptomer etter sykehusinnleggelse pga. covid-19, og fant patologiske MR-funn hos 58 % av pasientene, hvor myokardødem var det dominerende funnet (31). I en studie med uselekterte pasienter 2-3 måneder etter covid-19 ble det funnet hjertepatologi hos 26 % på MR, og disse funnene korrelerte med alvorlighetsgraden av akutt sykdom (32).
I en mindre studie fra Wuhan i Kina blant 27 restituerte pasienter etter covid-19 (13 med og 14 uten hjerteskade under sykehusinnleggelse) hadde 30 % hjertepatologi 6 måneder etter utskrivning (33). Pasienter med hjerteskade under sykehusinnleggelse var mer utsatt for å utvikle hjertefibrose under restitusjonen. Blant pasienter med hjerteskade hadde de med relativt høyere kardiale biomarkører og inflammatoriske faktorer ved innleggelse større sannsynlighet for å ha hjerteinvolvering i rekonvalesensfasen.
I en oversiktsartikkel vedrørende MR-funn relatert til alvorlighetsgrad av covid-19 fant man sjelden noen forandringer på MR ved asymptomatisk eller lavgradig covid-19 (34). Blant pasienter som hadde hatt asymptomatisk eller lavgradig covid-19, fant Joy et al. få med patologisk MR 6 måneder etter infeksjonen (19).
Hjerte og lungefunksjon ved belastning (CPET)
I PROLUN undersøkte vi prospektivt 189 pasienter med CPET tre måneder etter utskrivning fra fem norske sykehus (5). Totalt 26 pasienter med kroniske lunge- eller kardiovaskulær sykdommer og sju pasienter med inkonklusiv submaksimal CPET ble ekskludert. Halvparten av de resterende (n=156, gjennomsnittsalder 56 år og 39 % kvinner) hadde dyspné ved daglige aktiviteter. Spirometri var i normalområdet, mens diffusjonskapasitet (DLCO) var lett redusert. Maksimalt oksygenopptak (VO2-maks.) var på 29 ± 8 ml/kg, den anaerobe terskelen var på 52 % av VO2-maks. og
ventilasjonsekvivalenten for karbondioksid (VE/VCO2-slope, en markør for ventilasjonseffektivitet) på 28 ± 5 med en bevart ventilatorisk reserve (pustereserve) på 30 ± 17 % (figur 2). Oksygenpuls var på 15 ± 4 ml, og maksimal hjertefrekvens begrenset til 157 ± 20 slag/min. VO2-maks. var lavere hos pasienter med tidligere intensivopphold eller med vedvarende dyspné. Ventilasjon, pustereserve og VE/VCO2-slope var ikke forskjellig mellom intensiv- og ikke-intensivgruppene (figur 2). Disse CPETdataene antyder dekondisjonering som en dominerende årsak til dyspné/ tretthetssymptomatologi. Sirkulatoriske årsaker til VO2-maks. <≈80 % av predikert verdi var vanligere enn ventilatoriske årsaker.
Disse resultatene er i samsvar med resultatene fra 8 tidligere studier på totalt 203 pasienter (35). I en metaanalyse med 581 pasienter undersøkt med CPET etter covid-19 ble det funnet gjennomsnittsverdier av FEV1 på 97 % av predikert verdi, DLCO på 83 % av predikert verdi, VO2-maks. på 82 % av predikert verdi med en anaerob terskel på 50 % av VO2-maks., VE/VCO2-slope på 30,

bevart pustereserve og moderat redusert maksimalpuls som til sammen ga en CPET-profil som tydet på dekondisjonering (35). Det var en sterk korrelasjon (r 2 = 0,92, p < 0,01) mellom VO2-maks. av predikert verdi og lengden på sykehusoppholdet.
Totalt 58 pasienter og 30 matchede kontroller gjennomgikk CPET, spirometri og MR 3 og 6 måneder etter covid-19 (36). Etter 6 måneder var mer enn halvparten av pasientene fortsatt symptomatiske, og verken MR, spirometri eller CPET var assosiert med vedvarende symptombyrde. VO2-maks. var lavere hos pasientene etter 3 måneder sammenliknet med kontrollene, men ikke lenger etter 6 måneder.
VE/VCO2 slope var unormal hos pasientene etter 3 måneder og forbedret etter 6 måneder, men unormal i forhold til kontroller. Maksimal O2-puls var lavere hos pasienter sammenlignet med kontroller ved 3 måneder, men etter 6 måneder ble O2-pulsen bedre og sammenlignbar med kontrollene.
Arytmier
I PROLUN ble hjertearytmier påvist hos 27 % av pasientene med covid-19 (4). Ventrikulære ekstrasystoler (VES) var den hyppigste hjertearytmien. Mer enn 200 VES per dag ble observert hos
18 %, med et gjennomsnitt på 1300 VES/dag, og hos 95 % av disse pasientene var det polymorfe VES. Ikke-vedvarende ventrikulær takykardi (VT) ble funnet hos 5 % av pasientene, og 50 % hadde tidligere hjerte- og karsykdommer. Pasientene med atrieflimmer på 24-timers EKG hadde alle atrieflimmer før sykehusinnleggelse for covid-19. Sinoatrial blokkering > 3 sekunder ble kun observert hos én pasient. Den kliniske relevansen av disse funn vet vi ikke siden status før covid-19 mangler. I en metaanalyse som omfattet 9 studier, ble det funnet hjertearytmier under sykehusinnleggelse pga. covid-19 hos 19 % av pasientene (37), hvilket er litt lavere sammenlignet med vår studie. De kliniske implikasjonene av vedvarende ventrikkelarytmi etter covid-19 er ikke klare, men ventrikulær ektopi har vært knyttet til økt risiko for hjertesykdom, inkludert kardiomyopati og plutselig hjertedød (38). VES er vanligvis en godartet arytmi, men kan hos noen pasienter forårsake vedvarende hjertebank, brystsmerter og svimmelhet som fører til redusert livskvalitet (39). Potensielle alvorlige ventrikulære arytmier som ikke-vedvarende VT ble observert hos 5 %, som er dobbelt så mange sammenlignet med en norsk populasjonsbasert studie der det ble funnet ikke-vedvarende VT hos 2,6 % av 498 deltakere, og totalt hadde 9 % kompleks ventrikulær ektopi (bigemini, trigemini eller ikkevedvarende VT) (40). Hyppige VES (> 5 per time) ble observert hos 9 % og ble assosiert med signifikant høyere konsentrasjoner av NT-proBNP og
høysensitiv troponin I. Vi fant dobbelt så mange VES ved bruk av en strengere definisjon (> 200 VES per 24 timer). Hos friske frivillige ble > 200 VES per 24 timer observert hos 3 % og ikke-vedvarende VT hos 0,7 % (41). Uten en samsvarende kontrollgruppe er det imidlertid vanskelig å konkludere i forhold til covid-19. En beskjeden korrelasjon mellom VES og NT-proBNP- og høysensitiv tropinin-nivåer under sykehusinnleggelse og etter 3 måneder ble funnet i vår studie. Omfanget av mikroarr er ukjent etter covid-19, noe som kan være triggere for arytmier.
En nylig retrospektiv kohortstudie utført ved å gjennomgå elektroniske journaler fra et globalt helseforskningsnettverk viste at blant 718 365 pasienter med covid-19 utviklet 5 % nyoppstått myokarditt og 1,5 % perikarditt (41).
Myokarditt er et omdiskutert problem både under og i tiden etter covid-19, hovedsakelig på grunn av diagnostiske utfordringer, spesielt pga. manglende patologiske funn. I flere studier er diagnosen myokarditt enten basert på nivåene av isolert forhøyet troponin-verdi eller på kombinasjonen av forhøyet troponin-verdi og tegn på myokardødem på MR (42). Obduksjonsstudier har antydet at myokarditt ikke er så vanlig som først antatt (43).
Atleter og inflammatorisk hjertesykdom
Myokarditt forårsaket av covid-19 er en stor bekymring blant idrettskardiologer fordi insidensen av slik myokarditt er ukjent og fordi myokarditt er blant de hyppigste årsakene til plutselig hjertedød blant unge idrettsutøvere. En amerikansk multisenterstudie som omfattet 19 378 atleter (gjennomsnittsalder 25 år og 68 % menn), hadde 2820
atleter symptomer og gjennomgikk flere tester hvor man fant tegn på hjertepatologi på MR hos 0,7 % (44). En annen amerikansk studie inkluderte 789 profesjonelle idrettsutøvere (gjennomsnittsalder 25 år og 99 % menn) hvor totalt 58 % hadde hatt symptomatisk covid-19, mens de resterende var asymptomatiske (45). Diagnostikk ble utført 19 dager etter en positiv SARS-CoV-2-test. Kun 3 av utøverne hadde myokarditt og 2 perikarditt, dvs. 0,6 % totalt hadde peri- eller myokarditt.
Hjertesvikt
Selv om mange oversiktsartikler inkluderer hjertesvikt blant de mulige kliniske manifestasjonene av senkomplikasjoner etter covid-19, er studier som har dokumentert nyoppstått hjertesvikt hos pasienter som er blitt friske etter covid-19 sjelden. I de fleste studier rapporteres data om pasienter med allerede eksisterende hjertesvikt som muligens forverres etter covid-19, sammen med de få tilfellene av nyoppstått hjertesvikt. Maestre-Muniz et al. rapporterte debut av hjertesvikt hos 2 % av dem som ble friske etter covid-19 (46). Andre studier som sammenligner kardiovaskulære påvirkninger av covid-19, viser fravær av nyoppstått hjertesvikt etter covid-19 (16).
Arterielle og venøse trombotiske manifestasjoner
De tromboemboliske hendelsene registrert i løpet av det første året etter å ha blitt frisk etter akutt covid-19 inkluderer dyp venetrombose (2,4 %) og lungeemboli (1,7 %) (46).
Arteriell tromboemboli er mindre vanlig enn først antatt tidlig i pandemien. En amerikansk studie som inkluderte nesten 30 000 sykehusinnlagte pasienter, fant en insidens på kun 0,13 % (47).
Senkomplikasjonene etter covid-19 er fortsatt
ikke fullstendig forstått og omfatter en mengde av heterogene symptomer med usikker etiologi og usikker direkte årsakssammenheng med covid-19
Den totale prevalensen av kardiovaskulære senkomplikasjoner etter covid-19 er mindre enn antatt i begynnelsen av pandemien. Dyspné er vanlig i tillegg til tretthet etter covid-19. Den vanligste årsaken til dyspné er dekondisjonering og ikke redusert lunge- eller hjertefunksjon. Det er derfor viktig med rehabilitering etter gjennomgått moderat til alvorlig covid-19.
Brystsmerter er et vanlig symptom, men kardial årsak er sjelden påvist. Man bør dog være observant på peri- og myokarditttegn blant idrettsutøvere på tross av at prevalensen av inflammatorisk hjertesykdom er lav blant idrettsutøvere med covid-19. Palpitasjoner, uhensiktsmessig sinustakykardi, frekvente VES-er og
Referanser:
1. Lopez-Leon S, Wegman-Ostrosky T, Perelman C, et al. More than 50 long-term effects of COVID-19: a systematic review and meta-analysis. Sci Rep 2021; 11: 16144.
2. O’Dowd A. Covid-19: Third of people infected have long term symptoms. BMJ 2021; 373: n1626.
3. Fernandez-de-Las-Penas C, Palacios-Cena D, et al. Fatigue and dyspnoea as main persistent post-covid-19 symptoms in previously hospitalized patients: related functional limitations and disability. Respiration 2022; 101: 132-41.
4. Ingul CB, Grimsmo J, Mecinaj A, et al. Cardiac dysfunction and arrhythmias 3 months after hospitalization for COVID-19. J Am Heart Assoc 2022; 11: e023473.
5. Skjorten I, Ankerstjerne OAW, Trebinjac D, et al. Cardiopulmonary exercise capacity and limitations 3 months after COVID-19 hospitalisation. Eur Respir J 2021; 58 (2).
6. Zhou P, Yang XL, Wang XG, et al. A pneumonia outbreak associated with a new coronavirus of probable bat origin. Nature 2020; 579: 270-3.
7. Beyerstedt S, Casaro EB, Rangel EB. COVID-19: angiotensin-converting enzyme 2 (ACE2) expression and tissue susceptibility to SARS-CoV-2 infection. Eur J Clin Microbiol Infect Dis 2021; 40: 905-19.
8. Ackermann M, Verleden SE, Kuehnel M, et al. Pulmonary vascular endothelialitis, thrombosis, and angiogenesis in Covid-19. N Engl J Med 2020; 383: 120-8.
9. Stenmark KR, Frid MG, Gerasimovskaya E, et al. Mechanisms of SARS-CoV-2-induced lung vascular disease: potential role of complement. Pulm Circ 2021; 11: 20458940211015799.
10. Vaz de Paula CB, Nagashima S, Liberalesso V, et al. COVID-19: Immunohistochemical analysis of TGFbeta signaling pathways in pulmonary fibrosis. Int J Mol Sci 2021; 23.
11. Patil M, Singh S, Henderson J, et al. Mechanisms of COVID-19-induced cardiovascular disease: Is sepsis or exosome the missing link? J Cell Physiol 2021; 236: 3366-82.
12. Dani M, Dirksen A, Taraborrelli P, et al. Autonomic dysfunction in ‘long COVID’: rationale, physiology and management strategies. Clin Med (Lond) 2021; 21: e63-e7.
13. Seessle J, Waterboer T, Hippchen T, et al. Persistent symptoms in adult patients one year after COVID-19: a prospective cohort study. Clin Infect Dis 2021; ciab611.
13b. Whitaker M, Elliot J, Chadeau-Hyam M, et al. Persistent COVID-19 symptoms in a community study of 606,434 people in England. Nat Commun 2022; 13: 1957.
14. Huang C, Huang L, Wang Y, et al. 6-month consequences of COVID-19 in patients discharged from hospital: a cohort study. Lancet 2021; 397: 220-32.
15. Lerum TV, Aalokken TM, Bronstad E, et al. Dyspnoea, lung function and CT findings 3 months after hospital admission for COVID-19. Eur Respir J 2021; 57.
autonom dysfunksjon er vanlig og fører til økt belastning på helsevesenet. Disse symptom kan føre til mye ubehag, men har god prognose. Dysfunksjon av høyre ventrikkel er beskrevet i flere studier og er nok relatert til lungedysfunksjon og ikke hjertedysfunksjon. Noen studier har også rapportert økt diastolisk dysfunksjon, men det er få med redusert venstre ventrikkelfunksjon. At man suksessivt utvikler hjertesykdom i etterkant av covid-19 har ikke blitt beskrevet.
Studier er i stor grad publisert før vaksinen fikk effekt, og vi kan nå forvente færre sekveler etter covid-19. Det er en stor mengde med publikasjoner på senkomplikasjoner etter covid-19 («long covid») med stor variasjon i funn avhengig av
16. Lee CCE, Ali K, Connell D, Mordi IR, et al. COVID19-associated cardiovascular complications. Diseases 2021; 9.
17. Richter D, Guasti L, Koehler F, et al. Late phase of COVID-19 pandemic in General Cardiology. A position paper of the ESC Council for Cardiology Practice. ESC Heart Fail 2021; 8: 3483-94.
18. Huang L, Yao Q, Gu X, et al. 1-year outcomes in hospital survivors with COVID-19: a longitudinal cohort study. Lancet 2021; 398: 747-58.
19. Joy G, Artico J, Kurdi H, et al. Prospective case-control study of cardiovascular abnormalities 6 months following mild COVID-19 in healthcare workers. JACC Cardiovasc Imaging 2021; 14: 2155-66.
20. Stavem K, Ghanima W, Olsen MK,et al. Persistent symptoms 1.5-6 months after COVID-19 in nonhospitalised subjects: a population-based cohort study. Thorax 2021; 76: 405-7.
21. Bajwah S, Wilcock A, Towers R, et al. Managing the supportive care needs of those affected by COVID-19. Eur Respir J 2020; 55.
22. Dixit NM, Churchill A, Nsair A, et al. Post-acute COVID-19 syndrome and the cardiovascular system: What is known? Am Heart J Plus 2021; 5: 100025.
23. Li Y, Li H, Zhu S, et al. Prognostic value of right ventricular longitudinal strain in patients with COVID-19. JACC Cardiovasc Imaging 2020; 13) :2287-99.
24. Sonnweber T, Sahanic S, Pizzini A, et al. Cardiopulmonary recovery after COVID-19: an observational prospective multicentre trial. Eur Respir J 2021; 57.
25. Tangen J, Aukrust P, Barratt-Due A, et al. Reduced cardiac function by echocardiography in a minority of COVID-19 patients 3 months after hospitalization. J Am Soc Echocardiogr 2022; 35: 243-244.
26. Luchian ML, Motoc A, Lochy S, et al. Subclinical myocardial dysfunction in patients with persistent dyspnea one year after COVID-19. Diagnostics (Basel) 2021; 12.
27. Russell K, Eriksen M, Aaberge L, et al. A novel clinical method for quantification of regional left ventricular pressure-strain loop area: a non-invasive index of myocardial work. Eur Heart J 2012; 33: 724-33.
28. Gao YP, Zhou W, Huang PN, et al. Normalized cardiac structure and function in COVID-19 survivors late after recovery. Front Cardiovasc Med 2021; 8 :756790.
29. Myhre PL, Heck SL, Skranes JB, et al. Cardiac pathology 6 months after hospitalization for COVID-19 and association with the acute disease severity. Am Heart J 2021; 242 :61-70.
30. Puntmann VO, Carerj ML, Wieters I, et al. Outcomes of cardiovascular magnetic resonance imaging in patients recently recovered from Coronavirus Disease 2019 (COVID-19). JAMA Cardiol 2020; 5: 1265-73.
31. Huang L, Zhao P, Tang D, et al. Cardiac involvement in patients recovered from COVID-2019 identified using magnetic resonance imaging. JACC Cardiovasc Imaging 2020; 13: 2330-9.
32. Raman B, Cassar MP, Tunnicliffe EM, et al. Mediumterm effects of SARS-CoV-2 infection on multiple vital organs, exercise capacity, cognition, quality of life and mental health, post-hospital discharge. EClini-
alvorlighetsgraden av covid-19, komorbiditet, mangel på matchete kontroller, og i tillegg har de færreste informasjon om status for hjerte- og lungefunksjon før covid-19. Senkomplikasjonene etter covid-19 er fortsatt ikke fullstendig forstått og omfatter en mengde av heterogene symptomer med usikker etiologi og usikker direkte årsakssammenheng med covid-19.
Vi har nå publisert 12 måneders CPET data på covid-19 studien i ERJ ( https://erj.ersjournals.com/ content/61/2/2200745.long) med editorial ( https://erj.ersjournals. com/content/61/2/2201739) og
12 måneders ekko data ( https:// onlinelibrary.wiley.com/doi/10.1002/ clc.23891).
calMedicine 2021; 31: 100683.
33. Wu X, Deng KQ, Li C, et al. Cardiac involvement in recovered patients from COVID-19: A preliminary 6-month follow-up study. Front Cardiovasc Med 2021; 8: 654405.
34. Satterfield BA, Bhatt DL, Gersh BJ. Cardiac involvement in the long-term implications of COVID-19. Nat Rev Cardiol 2021¸ 1-10.
35. Naeije R, Caravita S. Phenotyping long COVID. Eur Respir J 2021; 58.
36. Cassar MP, Tunnicliffe EM, Petousi N, et al. Symptom persistence despite improvement in cardiopulmonary health - insights from longitudinal cMR, CPET and lung function testing post-COVID-19. EClinicalMedicine 2021; 41: 101159.
37. Pranata R, Huang I, Raharjo SB. Incidence and impact of cardiac arrhythmias in coronavirus disease 2019 (COVID-19): A systematic review and meta-analysis. Indian Pacing Electrophysiol J 2020; 20: 193-8.
38. Abdalla IS, Prineas RJ, Neaton JD, et al. Relation between ventricular premature complexes and sudden cardiac death in apparently healthy men. Am J Cardiol 1987; 60: 1036-42.
39. Sheldon SH, Gard JJ, Asirvatham SJ. Premature ventricular contractions and non-sustained ventricular tachycardia: association with sudden cardiac death, risk stratification, and management strategies. Indian Pacing Electrophysiol J 2010; 10: 357-71.
40. Skranes JB, Einvik G, Namtvedt SK, et al. Biomarkers of cardiovascular injury and stress are associated with increased frequency of ventricular ectopy: a population-based study. BMC Cardiovasc Disord 2016; 16: 233.
41. Buckley BJR, Harrison SL, Fazio-Eynullayeva E, et al. Prevalence and clinical outcomes of myocarditis and pericarditis in 718,365 COVID-19 patients. Eur J Clin Invest 2021; 51: e13679.
42. Ghugre NR, Orbach A, Biswas L, et al. Suspected subclinical myocarditis detected by cardiac magnetic resonance imaging late post COVID-19 recovery. J Cardiol Cases 2021; 24: 203-5.
43. Halushka MK, Vander Heide RS. Myocarditis is rare in COVID-19 autopsies: cardiovascular findings across 277 postmortem examinations. Cardiovasc Pathol 2021; 50: 107300.
44. Moulson N, Petek BJ, Drezner JA, et al. SARS-CoV-2 cardiac involvement in young competitive athletes. Circulation 2021; 144: 256-66.
45. Martinez MW, Tucker AM, Bloom OJ, et al. Prevalence of inflammatory heart disease among professional athletes with prior COVID-19 infection who received systematic return-to-play cardiac screening. JAMA Cardiol 2021; 6: 745-52.
46. Maestre-Muniz MM, Arias A, Mata-Vazquez E, et al. Long-term outcomes of patients with Coronavirus Disease 2019 at one year after hospital discharge. J Clin Med 2021; 10.
47. Glober N, Stewart L, Seo J, et al. Incidence and characteristics of arterial thromboemboli in patients with COVID-19. Thromb J 2021; 19: 104.
Publisert første gang i NGF nytt nr. 4 2021. Gjengitt med tillatelse. Redaksjonen takker NGF nytt og artikkelforfatterne for at Indremedisineren får anledning til å trykke artikkelen om Medisinsk behandling av Crohns sykdom som tidligere er publisert i NGF nytt.
Crohns sykdom er en kronisk immunmediert inflammatorisk tarmsykdom som i hovedsak debuterer i ung voksen alder. Alle avsnitt i fordøyelseskanalen fra munnhule til anus kan rammes, men hyppigst affiseres terminale ileum og tilstøtende del av kolon. Inflammasjonen er ofte transmural og granulomatøs og kan føre til alvorlige komplikasjoner som strikturer og fistler med abscessdannelse. I tillegg kan en vedvarende inflammasjon resultere i varig tarmskade med funksjonsnedsettelse. Hovedformålet med den medisinske behandlingen er derfor å få kontroll på den inflammatoriske prosessen i tarmen. I det følgende gis en oversikt over tilgjengelig medikamentell behandling av Crohns sykdom pr i dag. Videre diskuteres behandlingsstrategier, oppfølging og monitorering samt individuell behandling og optimalisering av ulike medikamenter.
Vendel Kristensen, Gastromedisinsk avdeling, Oslo universitetssykehus Ullevål
Hilde Løland von Volkmann, Seksjon for fordøyelsessjukdommar, Haukeland universitetssjukehus

Ann Elisabet Østvik, Gastromedisinsk avdeling, St. Olavs hospital


Jørgen Jahnsen, Gastromedisinsk avdeling, Akershus universitetssykehus

Aminosalisylater
Fortsatt er det mange Crohn pasienter som får behandling med ulike 5-aminosalisylsyre (5-ASA) preparater til tross for at det ikke foreligger dokumentert effekt hverken som induksjon- eller vedlikeholdsbehandling (1, 2). I nyere kliniske studier med utprøving av biologiske legemidler ved Crohns sykdom er det angitt at mer enn 30% av pasientene bruker 5-ASA (3). Dette kan tyde på at mange allikevel mener at disse preparatene er virksomme hos denne pasientgruppen. Oppdaterte AGA guidelines publisert tidligere i år anbefaler ikke bruk av 5-ASA for induksjon eller opprettholdelse av remisjon hos pasienter med moderat til alvorlig Crohns sykdom (4).
Kortikosteroider
Kortikosteroider har i mange år vært en hjørnestein i behandlingen av Crohns sykdom. Det ses en raskt innsettende effekt hos langt de fleste pasientene. Behandlingen skal bare benyttes ved påvist aktiv inflammasjon i tarmen og har ingen plass som vedlikeholdsbehandling for å forebygge tilbakefall. Ved oppstart gis ofte prednisolon 30–40 mg daglig i 1 til 2 uker. Dernest gradvis dosereduksjon med først 10 mg og senere 5 mg per uke. Behandlingsvarighet må individualiseres avhengig av sykdommens alvorlighetsgrad og behandlingsrespons.
Vanligvis vil en behandlingskur med kortikosteroider strekke seg over 2-3 måneder, men hos en del pasienter vil inflammasjonen i tarmen blusse opp igjen under nedtrappingen. Dette betegnes som streoidavhengighet, og det vil da som regel være nødvendig å sette inn annen behandling for å kunne stoppe med kortikosteroidene. Bruk over lengere tid må unngås på grunn av plagsomme og til dels alvorlige bivirkninger. Etter oppstart av TREAT registeret så man allerede etter 1 år at bruk av kortikosteroider førte til en økt forekomst av alvorlige infeksjoner hos pasienter med Crohns sykdom, og senere at slik behandling var en uavhengig risikofaktor for økt mortalitet (5). Kortikosteroider har også vist seg å være en betydningsfull risikofaktor for anastomoselekkasje etter tarmkirurgi og postoperativ sepsis. Det er derfor viktig at behandlingen avsluttes eller trappes ned til så lav dose som mulig før en eventuell operasjon. Langt bedre bivirkningsprofil ses med nyere perorale kortikosteroid preparater med hovedsakelig lokal virkning i tarmslimhinnen som følge av at det meste av aktivt medikament metaboliseres ved første passasje gjennom leveren. Budesonid (Entocort ®) er tilgjengelig som depotkapsler for kontrollert frisetting av aktivt kortikosteroid i terminale ileum og kolon ascendens. Dette er en hyppig lokalisasjon for inflammasjonen ved
Crohns sykdom, og budesonid kan derfor være et alternativ i behandlingen av disse pasientene.
Immunhemmende medikamenter Tiopurinene azatioprin (AZA, Imurel®) og 6-merkaptopurin (6-MP, Puri-Nethol®) samt metotreksat (MTX) omtales som immunhemmende medikamenter.
Tiopuriner
AZA er blitt brukt i utstrakt grad i behandlingen av Crohns sykdom. Full effekt inntrer først etter noe tid og virkningen kan derfor ofte ikke avgjøres før etter 3-4 måneder. AZA (2–2,5 mg/kg) har vist seg å forebygge tilbakefall av Crohns sykdom samtidig som det reduserer bruken av kortikosteroider og derfor hatt en plass som vedlikeholdsbehandling som vanligvis har strukket seg over år. Nyere undersøkelser har imidlertid reist spørsmål om hvor effektiv AZA egentlig er som monoterapi ved Crohns sykdom (6, 7). Før oppstart er det anbefalt å bestemme tiopurin metyltransferase (TPMT) enzymaktivitet for å redusere risikoen for alvorlige bivirkninger som blant annet beinmargsdepresjon. Hyppig blodprøvekontroll, som inkluderer cellerekkene i blodet, er derfor viktig i oppstartsfasen av behandlingen. I tillegg bør det monitoreres med regelmessig serummåling av den aktive metabolitten 6-tioguanin-
nukleotid (6-TGN) som har et angitt terapeutisk område (3.5- 5 mmol/L). AZA har mye bivirkninger og det er angitt at > 30% av Crohn pasienter må stoppe behandlingen på grunn av intoleranse til medikamentet. Ved lettere bivirkninger som kvalme og gastrointestinalt ubehag kan det skiftes til 6-MP eller alternativt redusere dosen. Hvis det oppstår mer alvorlige bivirkninger som pankreatitt, hepatitt eller et sykdomsbilde med allmennsymptomer, febrilia og CRP stigning må behandlingen avsluttes. AZA kan også føre til utvikling av ikkemelanom hudkreft og gir økt risiko for lymfom spesielt hos eldre pasienter (> 65 år). Hos denne pasientgruppen bør man derfor utvise tilbakeholdenhet med bruk av AZA. Det anbefales heller ikke å gi AZA til pasienter som har en serologisk test som viser at de ikke tidligere har hatt en Epstein-Barr virus (EBV) infeksjon. Noen få pasienter har en uheldig metabolisering av AZA som fører til lave verdier av 6-TGN, men høye verdier av 6-metylmerkaptopurin (6-MMP) som er assosiert med bivirkninger. Dette kan løses med en redusert dose av AZA kombinert med allopurinol.

Immunogenisitet med dannelse av antistoffer mot legemiddelet er et
stort problem ved behandling med TNF alfa-hemmere. Dette kan imidlertid forhindres eller utsettes ved samtidig bruk av et immunhemmende medikament. I dagens behandling av Crohns sykdom blir AZA først og fremst brukt i kombinasjon med en TNF alfa-hemmer og da i hovedsak infliximab. For å redusere risikoen for bivirkninger er det foreslått en lavere dosering av AZA (1-1,5 mg/ kg) som synes å være tilstrekkelig til å forebygge immunogenisitet (8). Imidlertid er det mulig at dette vil være uheldig hos enkelte pasienter fordi det samtidig kan redusere den farmakologiske effekten som AZA har på Crohn inflammasjonen. Det er ikke dokumentasjon for at en kombinasjonsbehandling med TNF alfa-hemmere og AZA bør fortsette utover et år.
Kvinner som behandles med AZA kan fortsette med uendret dosering ved et evt. svangerskap og i ammeperioden. Oppstart av behandling med AZA under graviditeten bør man imidlertid være noe tilbakeholden med på grunn av hyppig forekomst av bivirkninger.
Metotreksat
MTX er virksomt ved Crohns sykdom både som induksjon- og vedlike -
holdsbehandling vurdert ut ifra Crohns Disease Activity Index (CDAI) (9, 10), som i hovedsak er basert på kliniske symptomer og er et veldig subjektivt mål for sykdomsaktivitet. Det foreligger ingen studier som dokumenterer at det kan oppnås tilheling av slimhinnen med MTX. Den kliniske effekten er kun vist for parenteral administrasjon (subkutant/ intramuskulært). Vanlig dosering er 25 mg i uken, som etter 6 måneder kan reduseres til 15 mg i uken. En lavere startdose kan være aktuelt hos enkelte pasienter for å unngå bivirkninger. Det bør samtidig gis folsyre 5–7 mg i uken. MTX kan også forhindre eller utsette dannelsen av antistoffer mot TNF alfa-hemmere hos pasienter som får slik behandling, og benyttes til dette formålet hos pasienter som er intolerante eller av andre grunner ikke kan behandles med AZA.
Biologiske legemidler
Biologiske legemidler skiller seg fra andre legemidler ved at de er framstilt av, eller er renset fra, levende celler eller vev. De biologiske legemidlene som i dag benyttes i behandling av Crohns sykdom er alle monoklonale antistoffer med ulike angrepspunkter og virkemekanismer (Figur 1). I forbindelse med at
patentbeskyttelsen har utgått for enkelte biologiske legemidler, har vi i Norge de siste årene tatt i bruk biotilsvarende legemidler som har samme effekt og kvalitet som de originale.
TNF alfa hemmere
TNFα er et proinflammatorisk cytokin med en sentral rolle i den inflammatoriske prosessen som finner sted ved Crohns sykdom, og en hemming av aktiviteten til dette cytokinet har vist seg å være virksomt i behandlingen av sykdommen. I kliniske studier er det angitt at minst 60% av pasienter med moderat til alvorlig sykdomsaktivitet opplever en god respons. Tilheling av slimhinnen ses hos et stort antall pasienter, og det er også dokumentert effekt på fistler (11).
Av TNF α-hemmere har vi infliximab (Remicade ®, Remsima®, Inflectra®, Zessly ®, Flixabi®) som administreres som en intravenøs infusjon og adalimumab (Humira®, Hyrimoz®) som gis subkutant. I dag er biotilsvarende adalimumab førstevalget ved oppstart med biologisk behandling hos pasienter med Crohns sykdom på grunn av prisen.
Kombinasjonsbehandling med tiopuriner har vist seg å gi bedre effekt. I tillegg kan som tidligere anført immunogenisitet med antistoffdannelse mot det biologiske legemiddelet forhindres eller forsinkes. Dette er av stor betydning for å unngå tap av effekt. Imidlertid kan samtidig behandling med flere immunhemmende og immunmodulerende medikamenter medføre økt risiko for infeksjoner og mulig malignitetsutvikling (12).
Det er derfor viktig at man utfører nøye vurderinger før oppstart samt monitorer tett mhp. effekt og bivirkninger hos alle pasienter som får slik behandling. Behandlingslengden må individualiseres ut ifra alder, kjønn, immunogenisitet og forhold knyttet til sykdommen og sykdomsforløpet. I noen tilfeller må behandlingen pauses eller avsluttes pga . annen sykdom som eksempelvis kreft, alvorlig infeksjon og demyeliniserende sykdom.
Terapeutisk medikamentovervåking (TDM), måling av medikamentnivåer og antistoffer mot legemiddelet i serum, er av de fleste anerkjent som et nyttig verktøy for å forbedre effekt, sikkerhet og kostnadseffektivitet til biologiske legemidler. Det skilles mellom proaktiv og reaktiv TDM. Ved proaktiv TDM er medikamentkonsentrasjonen et selvstendig mål og hensikten er å forhindre eventuelle framtidige sykdomsoppbluss og tap av effekt. Bestemmelse av medikament konsentrasjonen ved aktiv inflammasjon som en tilleggsinformasjon for å avgjøre videre behandling omtales som reaktiv TDM. I klinisk praksis benyttes nok ofte en kombinasjon av pro- og reaktiv TDM.
I en nylig gjennomført norsk studie hos pasienter med immunmedierte sykdommer inklusive Crohns sykdom behandlet med infliximab ble det vist at bruk av proaktiv TDM kunne bidra til å forhindre sykdomsforverrelse ved 1 års oppfølging (13). Hva som er den optimale konsentrasjonen for de ulike legemidlene og hos undergrupper av pasienter er ikke klart fastsatt. Eksempelvis ser det ut til å være nødvendig med langt høyere serumkonsentrasjoner av infliximab for å oppnå fullgod effekt på fistelsykdom sammenlignet med
luminal inflammasjon hos Crohn pasienter (14).
Interleukin 12/23 hemming Ustekinumab (Stelara®), et monoklonalt antistoff mot p40-underenheten av interleukin-12 og interleukin-23, er godkjent for bruk ved behandling av psoriasis og psoriasis artritt. Effekt av ustekinumab er vist på Crohns sykdom gitt som vektbasert intravenøs infusjon etterfulgt av subkutane injeksjoner (15). I en nylig studie var 1/3 av pasientene i steroidfri klinisk remisjon etter 1 år, og av disse var 60 % fortsatt i remisjon etter 2 år (16). Ifølge det siste LIS-anbudet bør ustekinumab brukes dersom det blir nødvendig å skifte klasse fra TNF α-hemmere. Ustekinumab har vist seg å være svært lite immunogent, og kombinasjonsbehandling med en immunhemmer er derfor unødvendig i forhold til immunogenisitet med antistoffdannelse mot legemiddelet. Medikamentkonsentrasjoner av ustekinumab kan også måles og det synes å være en sammenheng mellom økende konsentrasjon og effekt på tarmsykdommen.
Blokkering av celleadhesjon Vedolizumab (Entyvio ®) er et biologisk legemiddel som kan være et behandlingsalternativ hos pasienter med Crohns sykdom som har utilstrekkelig effekt, tap av effekt eller vist intoleranse overfor TNF α-hemmere eller ustekinumab. Dette legemiddelet er en integrin reseptor antagonist, et humanisert monoklonalt antistoff som binder seg til integrin α4β7 som finnes på overflaten av aktiverte tarmsøkende leukocytter. Som følge blokkeres bindingen mellom integrin α4β7 og mukosal celleadhesjonsmolekyl-1 (MAdCAM-1) og man får en tarm-selektiv blokkering av leukocytter og dermed
“Treat to Target” har blitt vårt behandlingsmantra innen Crohns sykdom de senere år
en tarm-selektiv anti-inflammatorisk effekt. På grunn av virkningsmekanismen kan det ta noe tid (>10 uker) før man ser effekt av behandling med vedolizumab. Behandlingen kan startes med 2-3 påfølgende intravenøse infusjoner før man går over til subkutane injeksjoner annenhver uke (17). Vedolizumab er også svært lite immunogent og benyttes hovedsakelig som monoterapi. Den best mulige medikamentkonsentrasjonen er ikke fastsatt.

Når man velger å starte biologiske behandling er det viktig å ha oversikt over pasientens eventuelle andre sykdommer, både aktuelle og tidligere. Dersom pasienten har hatt kreft, anbefales det å drøfte med
en onkolog som har erfaring med akkurat den krefttypen pasienten har hatt (18). Dette fordi det fortsatt er noe usikkerhet om de biologiske legemidlene kan påvirke utviklingen av noen typer kreft eventuelt et tilbakefall av gjennomgått kreftsykdom.
Behandlingstrategier
“Treat to Target” har blitt vårt behandlingsmantra innen Crohns sykdom de senere år, der målet er endoskopisk tilheling i tillegg til tilbakegang av symptomer. CALMstudien viste at hvis fekal kalprotektin og CRP ble monitorert sammen med kliniske symptomer og brukt som grunnlag for oppstart og intensivering av anti-TNF, økte sannsynligheten for å nå endoskopisk tilheling (19). I 2020
ble langtidsresultater fra CALMstudien publisert (20). Denne viste at hos pasienter som ved ettårskontroll hadde oppnådd steroidfri klinisk remisjon med endoskopisk tilheling, var sannsynligheten for sykdomsprogresjon (definert som nye fistler, abscesser, kirurgi eller sykehusinnleggelser) de neste årene lavere (median oppfølgningstid tre år). STRIDE-II-anbefalingene (The Selecting Therapeutic Targets in Inflammatory Bowel Disease group) er nylig oppdatert med nye anbefalinger for behandlingsmål ved Crohns sykdom (21). Her skilles det nå mellom kortsiktige og mer langsiktige behandlingsmål (Figur 2).
Tabell
Klinisk bedring anses som et umiddelbart behandlingsmål, mens klinisk remisjon, normalisering av CRP og fall i fekal kalprotektin anses som gode behandlingsmål på kort og intermediær sikt. Det langsiktige behandlingsmålet er fremdeles endoskopisk remisjon, sammen med normalisert livskvalitet og normalt funksjonsnivå, i tillegg til klinisk remisjon. Histologisk tilheling og transmural tilheling er ikke ansett som formelle behandlingsmål. I behandling av pasienter med Crohns sykdom må vi, som ellers, huske på at vi behandler hele pasienten og ikke bare tarmen. Vi må derfor velge behandlingsstrategi og gjøre behandlingsvalg sammen med pasienten. Bivirkninger ved behandling, sikkerhetsprofil og eventuelle ekstraintestinale manifestasjoner må også inngå i vurderingen av behandlingsstrategi, og i noen tilfeller er kirurgi et godt alternativ til medikamentell behandling.
Oppfølging, kontroll og monitorering
Crohns sykdom er kompleks, og Crohn pasientene utgjør en svært heterogen gruppe. 15-20% av pasientene har avansert sykdom i form av strikturer eller fistler allerede ved diagnosetidspunktet, og mange utvikler avansert sykdom etter diagnose. Alle Crohn pasienter bør derfor følges opp i spesialisthelsetjenesten. Det vil være store forskjeller i behov for oppfølging slik at pasientutredning og oppfølging må individualiseres, men vi vil likevel skissere forslag til «basis-oppfølging».
Ved diagnose anbefales MR tynntarm for å kartlegge utbredelse av sykdommen. Undersøkelse med DEXA måling av beinmineraltetthet (BMD) bør også vurderes hos enkelte pasienter. Ultralyd er i ferd med å etablere seg som et nyttig verktøy til å kartlegge Crohns sykdom og gir informasjon om tilstedeværelsen av både aktiv inflammasjon og komplikasjoner. Pasientene bør tilbys minimum halvårlige kontroller ved en IBD-poliklinikk.
Forslag til standardisert blodprøver (Tabell 1).
Tidlig deteksjon av inflammatorisk aktivitet og dertil intervensjon er avgjørende og gir mulighet for bedret prognose og reduserer risiko for komplikasjoner (Figur 3).
Pasientinvolvering i klinisk vurdering og beslutning er viktig, og man bør tilby et minimum av informasjon i form av undervisning og informasjonsmateriell ved diagnosetidspunkt. Vi foreslår at alle med nydiagnostisert Crohns sykdom får tilbud om pasientinformasjonskurs eller skole i løpet av første år etter diagnose. Standardisert evaluering ved bruk av skåringsverktøy som for eksempel Harvey-Bradshaw Activity Index (HBI) for registrering av symptomer og funn anbefales brukt både av helsepersonell og også av pasientene selv (22). Slike selvhjelpsløsninger øker pasientens sykdomsinnsikt og -mestring og vil bidra til raskere deteksjon av sykdomsaktivitet. Standardisert og dokumentert pasientstatus vil sikre
en minimumsoppfølging av kronisk syke, redusere symptombyrde og gi helsepersonell raskere oversikt over hver enkelt pasients situasjon. Pasientflyt mellom leger og annet helsepersonell, avdelinger og sykehus vil bedres, med mindre behov for supplerende undersøkelser. Vi foreslår bruk av standardiserte journalnotater som inkluderer kliniske aktivitetsindekser som HBI og pasientene bør klassifiseres etter Montreal klassifikasjon for Crohns sykdom (23).
Ved ileokoloskopi anbefales bruk av skåringsverktøy som Simplified Endoscopic Score Crohn`s Disease (SES-CD) og post ileocøkalreseksjon Rutgeerts skår første gang ca . 6 mnd. etter operasjon (24, 25).
Oppstart biologisk behandling Før oppstart av biologisk behandling bør status for sykdomsaktivitet og utbredelse kartlegges med aktivitetsindeks, endoskopi med aktuell skår og eventuelt også billedundersøkelser for senere best mulig evaluering av behandlingsrespons. Som standardpakke før oppstart biologisk behandling anbefales EBV, hepatitt B og C, CMV og VZV serologi, HIV-test og IGRA-test ( I nterferron G amma Release A ssay) samt røntgen thorax. Opplysninger om vaksinestatus må innhentes og behov for kompletterende vaksinering før oppstart med biologiske medikamenter må vurderes. For detaljer om anbefalt vaksinasjon ved IBD henvises til Bjørn Moum sin artikkel i NGF-nytt, nr. 3, 2020.
Pasienter med demyeliniserende sykdom kan få forverring av sin sykdom ved bruk av TNF-hemmere, som derfor er kontraindisert for denne pasientgruppen. Vedolizumab og ustekinumab kan imidlertid benyttes.
Referanser:
1 Lim WC, Wang Y, MacDonald JK, Hanauer S. Aminosalicylates for induction of remission or response in Crohn’s disease. Cochrane Database Syst Rev. 2016;7:CD008870.(doi):10.1002/14651858.CD008870. pub2.
2 Akobeng AK, Zhang D, Gordon M, MacDonald JK. Oral 5-aminosalicylic acid for maintenance of medically-induced remission in Crohn’s disease. Cochrane Database Syst Rev. 2016;9(9):Cd003715.
3 Feagan BG, Sandborn WJ, Gasink C, Jacobstein D, Lang Y, Friedman JR, et al. Ustekinumab as Induction and Maintenance Therapy for Crohn’s Disease. N Engl J Med. 2016;375(20):1946-60.
4 Feuerstein JD, Ho EY, Shmidt E, Singh H, Falck-Ytter Y, Sultan S, et al. AGA Clinical Practice Guidelines on the Medical Management of Moderate to Severe Luminal and Perianal Fistulizing Crohn’s Disease. Gastroenterology. 2021;160(7):2496-508.
5 Lichtenstein GR, Feagan BG, Cohen RD, Salzberg BA, Diamond RH, Price S, et al. Serious infection and mortality in patients with Crohn’s disease: more than 5 years of follow-up in the TREAT™ registry. Am J Gastroenterol. 2012;107(9):1409-22.
6 Cosnes J, Bourrier A, Laharie D, Nahon S, Bouhnik Y, Carbonnel F, et al. Early administration of azathioprine vs conventional management of Crohn’s Disease: a randomized controlled trial. Gastroenterology. 2013;145(4):758-65.e2; quiz e14-5.
7 Panés J, López-Sanromán A, Bermejo F, GarcíaSánchez V, Esteve M, Torres Y, et al. Early azathioprine therapy is no more effective than placebo for newly diagnosed Crohn’s disease. Gastroenterology. 2013;145(4):766-74.e1.
8 Van Schaik T, Maljaars JP, Roopram RK, et al. Influence of combination therapy with immune modulators on anti-TNF trough levels and antibodies in patients with IBD. Inflamm Bowel Dis 2014;20:2292–8.
9 Feagan BG, Rochon J, Fedorak RN, Irvine EJ, Wild G,
Behandlingsrespons bør vurderes 3-6 mnd. etter oppstart av biologisk behandling. Det anbefales at man sikrer seg at hvert medikament er adekvat utprøvd før et eventuelt bytte, ved blant annet å innhente opplysninger om compliance samt
Sutherland L, et al. Methotrexate for the treatment of Crohn’s disease. The North American Crohn’s Study Group Investigators. N Engl J Med. 1995;332(5):292-7
10 Feagan BG, Fedorak RN, Irvine EJ, Wild G, Sutherland L, Steinhart AH, et al. A comparison of methotrexate with placebo for the maintenance of remission in Crohn’s disease. North American Crohn’s Study Group Investigators. N Engl J Med. 2000;342(22):1627-32
11 Vasudevan A, Bruining D, Loftus E, Faubion W, Ehman EC, Raffals L, Approach to medical therapy in perianal Crohn’s disease,World J Gastroenterol 2021 July 7; 27(25): 3693-3704
12 Muller M, D’Amico F, Bonovas S, Danese S, PeyrinBiroulet L. TNF Inhibitors and Risk of Malignancy in Patients with Inflammatory Bowel Diseases: A Systematic Review. J Crohns Colitis. 2021 May 4;15(5):840-859
13 Jørgensen KK, Syversen SW, Goll GL, Bjørlykke KH, Brun KH, Sandanger Ø, et al. Proactive therapeutic drug monitoring is superior to standard treatment during maintenance therapy with infliximab; the randomized NOR-DRUM part B clinical trial. IBD: Clinical trials posters II, UEG 2021
14 Yarur AJ, Kanagala V, Stein DJ et al. Higher infliximab trough levels are associated with perianal fistula healing in patients with Crohn’s disease Aliment Pharmacol Ther 2017 April 2017, 933-940
15 Feagan BG, Sandborn WJ, Gasink C, et al.; UNITI–IM-UNITI Study Group. Ustekinumab as induction and maintenance therapy for Crohn’s disease. N Engl J Med 2016; 375:1946–60.
16 Straatmijer T, Biemans VBC, Hoentjen F, de Boer NKH, Bodelier AGL, Dijkstra G, et al. Ustekinumab for Crohn’s Disease: Two-Year Results of the Initiative on Crohn and Colitis (ICC) Registry, a Nationwide Prospective Observational Cohort Study. J Crohns Colitis. 2021 Nov 8;15(11):1920-1930
17 Sandborn WJ, Feagan BG, Rutgeerts P, Hanauer S, Colombel JF, Sands BE, Lukas M, Fedorak RN,
måle medikamentkonsentrasjoner og eventuelt dannelse av antistoffer mot legemiddelet.
Lee S, Bressler B, Fox I, Rosario M, Sankoh S, Xu J, Stephens K, Milch C, Parikh A; GEMINI 2 Study Group. Vedolizumab as induction and maintenance therapy for Crohn’s disease. N Engl J Med. 2013 Aug 22;369(8):711-21.
18 Sebastian S, Neilaj S. Practical guidance for the management of inflammatory bowel disease in patients with cancer. Which treatment? Therap Adv Gastroenterol. 2019 Jan 4;12:1756284818817293.
19 Colombel JF, Panaccione R, Bossuyt P, Lukas M, Baert F, Vanasek T, et al. Effect of tight control management on Crohn’s disease (CALM): a multicentre, randomised, controlled phase 3 trial. Lancet. 2017:32641-7.
20 Ungaro RC, Yzet C, Bossuyt P, Baert FJ, Vanasek T, D’Haens GR, et al. Deep Remission at 1 Year Prevents Progression of Early Crohn’s Disease. Gastroenterology. 2020;159(1):139-47.
21 Turner D, Ricciuto A, Lewis A, D’Amico F, Dhaliwal J, Griffiths AM, et al. STRIDE-II: An Update on the Selecting Therapeutic Targets in Inflammatory Bowel Disease (STRIDE) Initiative of the International Organization for the Study of IBD (IOIBD): Determining Therapeutic Goals for Treat-to-Target strategies in IBD. Gastroenterology. 2021;160(5):1570-83.

22 Harvey RF, Bradshaw JM. A simple index of Crohn’sdisease activity. Lancet 1980; 315 (8167): 514.
23 Satsangi J, Silverberg MS, Vermeire S, Colombel JF. The Montreal classification of inflammatory bowel disease: controversies, consensus, and implications. Gut 55(6), 749–753 (2006).
24 Moskovitz DN, Daperno M, Van Assche G. Defining and validating cut-offs for the Simple Endocopic Score for Crohn’s Disease. Gastroenterology 2007; 132: S1097.
25 Rutgeerts P, Geboes K, Vantrappen G, Beyls J, Kerremans R, Hiele M. Predictability of the postoperative course of Crohn’s disease. Gastroenterology 1990;99:956-963.
Hypertensjon hos gravide skiller seg fra høyt blodtrykk ellers i befolkningen på flere vis. Det må tas hensyn til både mor og barn og dette påvirker behandlingsvalg. Det er viktig at alle leger som behandler gravide har kjennskap til de forskjellige typene hypertensjon i graviditet og hvordan disse best skal behandles.
Elisabeth Joy Rivertz Lister , medisinerstudent, Universitetet i Oslo
Nanna von Der Lippe, overlege PhD Nyremedisinsk avdeling OUS Ullevål Aud Høieggen overlege Dr. med og førsteamanuensis, Nyremedisinsk avdeling OUS Ullevål og Universitetet i Oslo.



De fleste gravide kvinner har normalt blodtrykk, men hypertensjon sees hos ca. 8-10 % av gravide i Norge (1). Hypertensjon i graviditet skiller seg fra hypertensjon hos ikke-gravide når det gjelder patofysiologi, symptomatologi og prognose.
Nye studier indikerer at blodtrykksgrenser ved kronisk hypertensjon hos gravide bør ligge noe lavere enn man tidligere har antatt, og retningslinjer fra forskjellige land har vært ulike. Blodtrykksbehandling hos gravide er en aktuell problemstilling for indremedisinere både på poliklinikk og vakt.
Blodtrykket under normal graviditet
Til tross for økning i plasmavolum faller både systolisk og diastolisk blodtrykk ca. 5-10 mmHg tidlig i graviditeten. Dette skyldes lav perifer motstand pga. hormonelle endringer av angiotensin II, noradrenalin og relaxin (2, 3). Andre foreslåtte mekanismer er økt endotelial prostasyklinproduksjon, økt nitrogen monoksid (NO) produksjon og redusert aortastivhet (2). Blodtrykket når sitt bunnivå rundt uke 18/19, for så å øke i tredje trimester. Ved termin er blodtrykket normalisert til utgangstrykket fra før graviditet (2, 4). Dette mønstret kan man også se hos gravide med erkjent hypertensjon før graviditet.
Hypertensjon i svangerskap Hypertensjon er en viktig årsak til både maternell, føtal og neonatal sykdom og død. Risiko for mor under graviditeten omfatter placentaløsning, hjerneslag, multiorgansvikt og disseminert intravaskulær koagulasjon (DIC) (5). For fosteret er
det økt risiko for intrauterin veksthemning, prematuritet og intrauterin fosterdød (5). Noen kvinner får kun moderat økning i blodtrykket uten komplikasjoner, mens andre vil kunne progrediere til alvorlig hypertensjon, som kan føre til innleggelser og multiorganskade (6).
I følge de europeiske hypertensjonsretningslinjene (5) defineres hypertensjon hos gravide som systolisk blodtrykk ≥ 140 mmHg og/eller diastolisk blodtrykk ≥ 90 mmHg. Videre klassifiseres hypertensjon som mild (140–159/90–109 mmHg) og alvorlig (≥ 160/110 mmHg) (5).
Kronisk hypertensjon
1-2% av gravide kvinner har hypertensjon før graviditet (1). Kronisk hypertensjon i svangerskap defineres som kjent hypertensjon (> 140 mmHg systolisk og/eller > 90 mmHg diastolisk, eller bruk av antihypertensiva) før svangerskap eller vedvarende høyt blodtrykk før 20. svangerskapsuke (7).
Blodtrykket følger samme kurve som hos normotensive, med fall i første og andre trimester, etterfulgt av økning til utgangstrykket i siste trimester. Kvinner med udiagnostisert kronisk hypertensjon vil derfor ofte ikke diagnostiseres som hypertonikere før blodtrykket stiger over normale verdier i siste trimester, og sikker diagnose stilles ikke før hypertensjonen persisterer > 12 uker postpartum (4).
Undersøkelse for hypertensiv endeorganskade som venstre ventrikkel hypertrofi (VVH) og albuminuri som tegn på nyreskade bør gjøres, da endeorganskade kan påvirke svangerskapsrisiko og utfall
(4). Hypertensive svangerskapskomplikasjoner hos kvinner med kronisk hypertensjon er blant annet kronisk hypertensjon komplisert av preeklampsi («superimposed» preeklampsi), føtal tilveksthemming, placentaløsning, for tidlig fødsel og keisersnitt (4).
For medikamentelt behandlede kvinner må det før konsepsjon/tidlig etter verifisert graviditet vurderes å endre det antihypertensive regimet til medikamenter som kan brukes under graviditet.
At kvinner med kronisk hypertensjon kan ha proteinuri før graviditet, kan gjøre det utfordrende å stille diagnosen preeklampsi. Preeklampsi bør mistenkes ved forverring av eller nyoppstått proteinuri (4). Funn forenlig med maternell organaffeksjon, for eksempel trombocytopeni, forhøyede transaminaser (ASAT, ALAT) og økt serum kreatinin, kan også være til hjelp for å skille preeklampsi fra en forverring av underliggende hypertensjon (4).
Svangerskapshypertensjon
Svangerskapshypertensjon påvises hos ca. 4-5% av gravide (1). Det defineres som nyoppstått hyper tensjon (uten proteinuri eller maternell organaffeksjon/fravær av pre eklampsi) etter 20. svangerskapsuke (7). Svangerskapshypertensjon er gjerne normalisert innen seks uker postpartum (7, 8). Vedvarer hypertensjonen > 12 uker postpartum har pasienten en ikke-erkjent kronisk hypertensjon. Svangerskapshypertensjon har lignende patofysiologi og risikofaktorer som preeklampsi, og noen av disse kvinnene vil utvikle preeklampsi. Jo tidligere hyper-
tensjonen oppstår, desto høyere er risiko for utvikling av preeklampsi (8).
Preeklampsi
Preeklampsi oppstår i ca 3-4% av alle svangerskap i Norge (1). Definisjonen på preeklampsi har endret seg de siste årene. Norsk veileder i fødselshjelp anbefaler at preeklampsi defineres som nyoppstått hypertensjon (> 140 mmHg systolisk og/ eller > 90 mmHg diastolisk) etter 20. svangerskapsuke kombinert med nyoppstått proteinuri eller andre tegn på organdysfunksjon (7).
Patofysiologien er ennå ikke helt forstått. En enkel forklaring er en forstyrrelse i dannelsen av placenta som fører til placentadysfunksjon (9). En dysfunksjonell placenta vil skille ut antiangiogene faktorer som bidrar til vaskulær inflammasjon, endotelial dysfunksjon og skade på det maternelle karsystem. Dette manifesterer seg i hypertensjon og multippel organskade (9, 10).
Ubehandlet er tilstanden assosiert med alvorlige maternelle komplikasjoner som eklampsi og død. For barnet kan dysfunksjon i placenta medføre komplikasjoner som veksthemning og for tidlig fødsel, med påfølgende neonatale komplikasjoner knyttet til prematuritet (9, 10).
Hypertensiv krise regnes som blodtrykk ≥ 170-180/110-120 mmHg (5) med eller uten akutt endeorganskade. Eklampsi, generaliserte, tonisk-kloniske kramper er et eksempel på hypertensiv endeorganskade som kan oppstå hos kvinner med preeklampsi eller svangerskapshypertensjon, uten at det foreligger andre nevrologiske årsaker til krampene (11, 12). Eklampsi er den mest alvorlige manifestasjonen og komplikasjonen til preeklampsi, med en insidens på 5/10 000 svangerskap i Norge (7, 11). Det rammer normalt sett kvinner med alvorlig preeklampsi, sent i graviditeten (7).
Komplikasjoner knyttet til hypertensjon i svangerskap På kort sikt er de viktigste komplikasjonene til hypertensjon i svangerskap utvikling av preeklampsi, føtal tilveksthemming, for tidlig fødsel, keisersnitt og placentaløsning. Først og fremst er det skade på foster
man frykter, men ved svært høye blodtrykk vil det selvfølgelig være risiko for alvorlig hypertensiv endeorganskade hos mor.
På lang sikt er hypertensjon i svangerskapet assosiert med hypertensive tilstander også senere i livet. Studier har vist at kvinner med preeklampsi har økt risiko for nyresykdom og hjertekarsykdom (13, 14). I en oppsummeringsartikkel fra Universitetet i Bergen presenteres svangerskapet som en «stress-test», der preeklampsi vil avdekke forhøyet kardiovaskulær og renal risiko på et tidlig tidspunkt i livet (14). Klinisk konsekvens av denne viten er å identifisere disse kvinnene, slik at evt. sykdomsutvikling oppdages tidlig og kan forebygges og behandles deretter. Det er en anbefaling at disse kvinnene skal følges opp etter fødsel for primærforebygging av hjerte- og karsykdom frem til 50 års alder (7).

Risikofaktorer for hypertensive svangerskapskomplikasjoner Risikofaktorer for utvikling av hypertensive svangerskapskomplikasjoner er alvorlig preeklampsi i tidligere svangerskap (tidlig forløsning før uke 34 og/eller tilveksthemming hos foster), førstegangsgravid, alder > 40 eller < 18 år, familiehistorikk med preeklampsi hos mor eller søster, overvekt (KMI>28 kg/ m2) og kvinner med genetisk afrikansk bakgrunn (2). Videre er kronisk hypertensjon, kronisk nyresykdom, pregestasjonell diabetes mellitus og autoimmune sykdommer som antifosfolipidsyndrom og systemisk lupus erythematosus risikofaktorer. Studier har også pekt på kort tid fra første samleie med barnefar til svangerskap og lang tid fra forrige svangerskap (>10 år) som risikofaktorer (3, 4) Andre risikofaktorer er føtal tilveksthemming, svangerskapsdiabetes, graviditet etter assistert befruktning med eggdonasjon, IVF, flerlinger eller svangerskap med stor placenta (Figur 1).
Under svangerskapet skal blodtrykket måles ved alle kontakter med helsepersonell. Livsstilsendring bør ligge til grunn for all blodtrykksbehandling - også hos gravide (5). Det er viktig å presisere at
disse endringene også gjelder etter graviditeten.
Fordi placentaperfusjonen er direkte avhengig av blodtrykket, har man vært generelt forsiktig med å senke blodtrykket for mye. Nedre blodtrykksgrense hos gravide er ikke klart definert, bortsett fra i International Society for the Study of Hypertension in Pregnancy guidelines (ISSHP) (8). I en fersk randomisert studie (15) konkluderte forfatterne med at det gikk bedre når gravide kvinner med kronisk hypertensjon fikk antihypertensiv behandling ved blodtrykk >140/90 mmHg (behandlingsgruppe) enn der man så det an til blodtrykket var > 160/105 mmHg (kontrollgruppe). Studien viste 20% lavere risiko for utvikling av alvorlig preeklampsi, 27% færre premature induksjoner av fødsel og 18% reduksjon i utvikling av alvorlig hypertensjon i behandlingsgruppen sammenliknet med kontrollgruppen. Forfatterne diskuterer begrensninger knyttet til utvalget (mild kronisk hypertensjon før uke 23 med ett blodtrykksmedikament) og reserverer seg mot å generalisere til alle gravide med hypertensjon. En klar nedre behandlingsgrense defineres ikke.
Medikamentell behandling Mange gravide med kjent hypertensjon kan på grunn av den fysiologiske blodtrykksreduksjonen klare seg uten legemidler frem til slutten av graviditeten (16).
Alle blodtrykksmedikamenter krysser placenta, men i varierende grad (3). Medikamentenes virkningsprofil bør være effektiv for mor og trygt for foster. Det er ingen store randomiserte studier som kan konkludere med at enkelte medikamenter er bedre enn andre hos gravide. Generelt er det vanskelig med studier hos gravide og anbefalinger baserer seg på teori og empiri. Et eksempel på dette er forsiktighet ved bruk av diuretika, som reduserer plasmavolumet, og dermed teoretisk også placentasirkulasjonen.
Både labetalol og nifedipin depot er anbefalte førstevalg hos gravide på bakgrunn av erfaring og mangel på påvist risiko for fosteret (5, 7). Betareseptorblokkere kan forårsake føtal bradykardi og bruk av andre typer enn labetalol skal derfor brukes med forsiktighet. Alternativt kan amlodipin brukes hvis nifedipin depot ikke er tilgjengelig.
Det har vært rapportert uheldige interaksjoner ved samtidig bruk av nifedipin og magnesiumsulfat (MgSO4). Tidligere har det derfor vært bekymring rundt bruk av nifedepin depot hos kvinner med preeklampsi som behandles med krampeprofylakse med magnesium. På tross av rapporterte uheldige interaksjoner er medikamentene likevel ofte kombinert og med god erfaring (3).
Methyldopa er det best studerte blodtrykksmedikamentet for gravide, og baserer seg på en eldre studie (17) og lang erfaring (5). Preparatet er per i dag avregistrert i Norge, men tilgjengelig på godkjenningsfritak for kvinner som ikke oppnår blodtrykkskontroll, eller av andre grunner ikke kan bruke nifedipin depot eller labetalol (18).
Medikamentell behandling ved
hypertensiv krise hos gravide
Gravide med hypertensiv krise eller alvorlig preeklampsi skal alltid innlegges på sykehus. Også her er det lite forskning som konkluderer med bedre effekt av et medikament fremfor
et annet (19). Det er enighet om at krampeprofylakse skal gis i form av magnesiumsulfat intravenøst. Det gis som engangs bolusdose etterfulgt av en vedlikeholdsdose i 24 timer (7).
Hvis man innsetter blodtrykksbehandling utenfor sykehus kan man starte med labetalol og nifedipin depot tabletter, evt. i kombinasjon med metyldopa. Diazepam i.v. kan gis mot kramper (7). I sykehus gir man intravenøst labetalol. Kommer man ikke i mål med labetalol, kan intravenøs dihydrolazin og nitroprussid gis. Nitroprussid > 48 t bør dog unngås pga risiko for cyanidakkumulering. Ved akutt høyt blodtrykk må man alltid vurdere hastigheten av trykksenkningen, da for rask reduksjon av blodtrykket kan true uteroplacentær sirkulasjon (7). Her er det viktig med et tett samarbeid med fødselslege.
Det er kontraindisert med ACEhemmer, angiotensin II reseptorblokker (ARB) og direkte reninhemmer i 2. og 3. trimester, og de er ikke anbefalt i 1. trimester av svangerskapet. Kvinner som bruker disse medisinene før graviditet rådes til å bytte når de planlegger svangerskap. Eksponering for disse medikamentene i siste halvdel av svangerskapet er assosiert med skade på fosterets nyrer, samt oligohydramnion, forsinket bendannelse i hodeskallen og neonatal toksisitet (20, 21). Bruk av mineralkortikoid reseptorantagonist (MRA) er generelt ikke anbefalt. Det er begrensede data vedrørende bruk av diuretika under graviditet, og de skal derfor brukes med forsiktighet. Noen diuretika kan likevel brukes på spesiell indikasjon, men ved lave doser. I disse tilfellene skal fostervekst overvåkes nøye. Andre betareseptorblokkere enn labetalol skal som nevnt brukes med forsiktighet i graviditet.
Lavdose acetylsalicylsyre (ASA)
Preeklampsi er assosiert med redusert produksjon av prostasyklin og økt produksjon av platederivert tromboksan, som både er en vasokonstriktor og stimulerer til plateaggregering. Behandling med platehemmer har derfor fått plass i svangerskapsbehandling som preeklampsiforebygging (22, 23).
Hos kvinner med moderat til høy risiko for å utvikle preeklampsi, vil lavdose ASA redusere forekomsten med 1020% (23). Dette gjelder også uheldige utfall av svangerskap som prematur fødsel og veksthemning.
I Norge anbefales alle gravide med kjent hypertensjon ASA profylakse (75-150 mg) fra uke 12 og frem til fødsel (dersom 75 mg/dag) eller til uke 36 (dersom 150 mg/dag) (7). I Norge vektlegges potensiell risiko knyttet til ASA og man anbefaler derfor ikke oppstart etter uke 16, da dette ikke har vist å ha forebyggende effekt (7).
Behandlingsmål for hypertensjon i svangerskap Blodtrykksbehandling hos gravide har som hovedhensikt å redusere risiko for utvikling av alvorlig hypertensjon, og dermed redusere risiko for maternelle og føtale hypertensive komplikasjoner.
En Cochrane rapport fra 2018 (6) konkluderte med at antihypertensiv medikamentell behandling for mild til moderat svangerskapshyper tensjon reduserte risiko for utvikling av alvorlig hypertensjon. Effekten på andre utfall var derimot uklar. Antihypertensiva hadde lite til ingen effekt på antall kvinner som utviklet preeklampsi. Det viste heller ikke effekt på antall barn født «small for gestational age» og for tidlig fødsel (6).
Mye forskning på blodtrykksbehandling av mild hypertensjon kombinerer kronisk hypertensjon og svangerskapshypertensjon. Dette er en utfordring da de muligens representerer ulik patofysiologi. Behandlingsmål for kronisk hyper tensjon hos ikke-gravide kan heller ikke sikkert overføres til gravide, da de ikke tar hensyn til føtale effekter og fysiologiske endringer i svangerskapet.
Norske og internasjonale retningslinjer for behandling av gravide med hypertensjon spriker både når det gjelder grense for oppstart av behandling og mål for behandlingen (Tabell 1). På bakgrunn av den randomiserte studien nevnt over (15), kan man forvente noen endringer i anbefalinger.
Ulike veiledere anbefaler forskjellige grenser for nedre behandlingsmål. Heller ikke i den nylig publiserte
ESH: European society of hypertension, ISSHP: International Society for the study of hypertension in pregnancy, HT: Hypertensiv
studien på 2408 kvinner med mild hypertensjon konkluderte man med noe nedre behandlingsgrense (15). For hypertensjon hos ikke-gravide er det angitte behandlingsmålet <130/80mmHg, men ikke lavere enn 120/70 mmHg (8). I svangerskapet har man vært forsiktig med å senke blodtrykket for lavt fordi placentaperfusjonen er direkte avhengig av mors blodtrykk. Sannsynligvis er det viktigste å komme under 140/90 mmHg, men heller ikke så mye lavere, for dermed å forhindre maternelle komplikasjoner uten å påvirke uteroplacentær blodsirkulasjon, men her mangler konklusive data. ISSHP definerer en nedre grense på SBP så lavt som 110 mmHg.
Amming
På grunn av fordeler knyttet til amming anbefales kvinner med pågående blodtrykksbehandling å amme. Generelt er de fleste antihypertensive legemidler målbare i morsmelk, men i
Litteraturliste
1. Nasjonal faglig retningslinje: Behandling av hypertensjon ved svangerskap og kjent diabetes.
mye lavere konsentrasjon enn i mors plasma (4).
Medikamenter som påvirker reninangiotensin systemet skal ikke brukes under amming. Betareseptorblokkere går over i morsmelk, men ved terapeutiske doser er risiko for effekt hos barnet liten (24). Atenolol og metoprolol er kontraindisert, mens ved bruk av labetalol og propanolol rapporteres det lite bivirkninger (3, 4, 24). Symptomer på betablokkade som bør observeres er bradykardi, hypotensjon og slapphet (24).
Overgangen av diuretika til morsmelk er liten, og det regnes som trygt å bruke under amming. Likevel bør det unngås da en reduksjon av plasmavolum kan redusere melkeproduksjonen (3, 4).
Selv om kalsiumkanalblokkere (nifedipin, verapamil og diltilazem) er rapportert å komme over i mors-
melken, regnes dosene som så små at de trygt kan brukes under amming (3). Det tryggeste, og det som ofte gjøres i praksis, er å fortsette med de samme blodtrykksmedikamentene som kvinnen brukte under graviditeten også mens hun ammer.
Konklusjon
Hypertensjon i graviditet forekommer hos ca. 1 av 10 av alle gravide i Norge. Med flere eldre førstegangsfødende, økende kroppsmasseindeks og stillesittende livsstil kan man regne med at hypertensive svangerskapstilstander vil øke. Det er en generell oppfatning, nå styrket av en randomisert studie, at kronisk hypertensjon i graviditet trygt kan behandles til < 140/90 mmHg, men nedre grense for blodtrykket er ikke definert. Førstevalget av blodtrykksmedikamenter er labetalol og nifedepin depot. Acetylsalisylsyre hører med som en del av behandlingen
de
9. Chappell LC, Cluver CA, Kingdom J, Tong S. Pre-eclampsia. Lancet. 2021;398(10297):341-54.
17. Redman CWG, Beilin LJ, Bonnar J, Ounsted MK. Fetal outcome in trial of antihypertensive treatment in pregnancy. The Lancet (British edition). 1976;308(7989):753-6.
2. Michael R Foley M. Maternal adaptations to pregnancy: Cardiovascular and hemodynamic changes. 2021.
3. Mustafa R, Ahmed S, Gupta A, Venuto RC. A comprehensive review of hypertension in pregnancy. Journal of Pregnancy. 2012;2012:105918.
4. Seely EW, Ecker J. Chronic hypertension in pregnancy. Circulation. 2014;129(11):1254-61.
5. Williams B, Mancia G, Spiering W, Agabiti Rosei E, Azizi M, Burnier M, et al. 2018 ESC/ESH Guidelines for the management of arterial hypertension. European Heart Journal 2018 Sep 1. Report No.: 0195-668x Contract No.: 33.
6. Abalos E, Duley L, Steyn DW, Gialdini C. Antihypertensive drug therapy for mild to moderate hypertension during pregnancy. Cochrane Database Systematic Reviews. 2018;10(10):Cd002252.
7. Staff A, et a. Hypertensive svangerskapskomplikasjoner og eklampsi [ePub]. Norsk gyenkologisk forening: Veileder i fødelshjelp; 2020 [Available from: https://www.legeforeningen.no/ foreningsledd/fagmed/norsk-gynekologisk-forening/veiledere/ veileder-i-fodselshjelp/hypertensive-svangerskapskomplikasjoner-og-eklampsi/.
8. Brown MA, Magee LA, Kenny LC, Karumanchi SA, McCarthy FP, Saito S, et al. Hypertensive Disorders of Pregnancy: ISSHP Classification, Diagnosis, and Management Recommendations for International Practice. Hypertension. 2018;72(1):24-43.
10. Zeisler H, Llurba E, Chantraine F, Vatish M, Staff AC, Sennström M, et al. Predictive Value of the sFlt-1:PlGF Ratio in Women with Suspected Preeclampsia. N Engl J Med. 2016;374(1):13-22.
11. Barlindhaug SF. Preeklampsi og hypertensive svangerskapskomplikasjoner NEL2021 [updated 29.09.21. Available from: https://legehandboka.no/handboken/kliniske-kapitler/obstetrikk/ tilstander-og-sykdommer/komplikasjoner-i-svangerskapet/ preeklampsi-og-eklampsi#fagmedarbeidere.
12. Eclampsia [Internet]. UpToDate. 2021. Available from: https://www.uptodate.com/contents/eclampsia?search=e clampsi&source=search_result&selectedTitle=1~150&usag e_type=default&display_rank=1.
13. Vikse BE, Irgens LM, Leivestad T, Skjærven R, Iversen BM. Preeclampsia and the Risk of End-Stage Renal Disease. New England Journal of Medicine. 2008;359(8):800-9.
14. Vikse BE. Hypertensjon og nyresykdom hos gravide. Indremedisineren. 2014.
15. Tita AT, Szychowski JM, Boggess K, Dugoff L, Sibai B, Lawrence K, et al. Treatment for Mild Chronic Hypertension during Pregnancy. N Engl J Med. 2022;386(19):1781-92.
16. legemiddelhåndbok N. T15.1.2.1 Kronisk hypertensjon og svangerskap Norsk legemiddelhåndbok2016 [Available from: https://www.legemiddelhandboka.no/T15.1.2.1/Kronisk_hypertensjon_og_svangerskap?fbclid=IwAR2qsXnQb7CI1yznkjc2Za4X 9UNGbnTkUu59X-ChpMJvYSF5FKXxviBcpuA.
18. Legemidler på godkjenningsfritak [Internet]. Felleskatalogen.
19. Easterling T, Mundle S, Bracken H, Parvekar S, Mool S, Magee LA, et al. Oral antihypertensive regimens (nifedipine retard, labetalol, and methyldopa) for management of severe hypertension in pregnancy: an open-label, randomised controlled trial. . Lancet.394(10203):1011-21.
20. Treatment of hypertension in pregnant and postpartum patients [Internet]. 2021 [cited hentet 12.01.22]. Available from: https:// www.uptodate.com/contents/treatment-of-hypertension-inpregnant-and-postpartum-patients.
21. Steffensen FH, Nielsen GL, Sørensen HT, Olesen C, Olsen J. Pregnancy outcome with ACE-inhibitor use in early pregnancy. Lancet. 1998;351(9102):596-.
22. Roberts JM, Redman CW. Pre-eclampsia: more than pregnancyinduced hypertension. Lancet. 1993;341(8858):1447-51.
23. Preeclampsia: Prevention [Internet]. 2021. Available from: https://www.uptodate.com/contents/ preeclampsia-prevention?search=preeclampsia%20 prevention&source=search_result&selectedTitle=1~150&usa ge_type=default&display_rank=1#H2.
24. Pranolol [nettdokument]. Felleskatalogen.no; 2020 [updated 25.11.2021. Available from: https://www.felleskatalogen.no/ medisin/pranolol-actavis-562924.


















Olympus is the only gastroenterology solution provider that combines the entire clinical process with state-of-theart medical technology and precision manufacturing capabilities. From diagnosis and therapy to documentation, processing and training, this support allows medical professionals to strengthen their skills and optimize workflows, and thus aiming to achieve best possible outcomes for their patients.

Whether it is a diagnostic or therapeutic endoscopic procedure — ranging from basic to advanced — our unique and comprehensive endoscopic product portfolio ensures the right solution for all clinical needs.



Using the right ERCP tools during interventions with pancreatobiliary disorders allows you to effectively exchange devices during the procedure. The Olympus ERCP portfolio contains, among others, our VisiGlide guidewires, the CleverLock guidewire locking device and the CleverCut 3 V preloaded sphincterotomes to help ensure smooth procedures.
ESD is an effective technique for removing cancerous or other abnormal tissues from the digestive tract. Olympus has pioneered the development of the ESD technique and developed devices like the DualKnife J, HookKnife J, and the TriangleTipKnife J to ease the operations. The Coagrasper hemostatic forceps allow for reliable hemostasis during ESD procedures.

POEM is an endoscopic procedure to cure achalasia, an esophageal motility disorder with symptoms like dysphasia. Olympus offers excellent products for POEM procedures such as the dedicated TriangleTipKnife J and the NeedleMaster injection needles.
EUS combines the advantages of endoscopy and ultrasonography. Olympus EZShot 3 and EZShot 3 Plus EUS needles provide superior flexibility that helps smooth access and targeting for EUS-FNB and EUS-FNA. Consequently, tissue can be obtained from difficult scope positions.


In the respiratory field, Olympus provides a wide range of innovative solutions and advanced equipment to support respiratory diagnosis and treatment. These include a versatile lineup of instruments for endobronchial ultrasound, transbronchial needle aspiration, peripheral bronchoscopy and valves for emphysema and air leak treatment.
Read More ... www.olympus.eu/endotherapy

I 2019 ble hovedspesialiteten Indremedisin sidestilt med de 8 tidligere grenspesialitetene, samtidig som den nye spesialiteten Akutt- og mottaksmedisin ble etablert. Indremedisinere burde være spesielt egnet til vaktarbeid som skal dekke pasienter med sykdommer som sorterer under de 10 hovedspesialitetene, samt på intensivavdelinger, sengeposter, poliklinikker og i tilsynsarbeid. I Danmark ser man at multimorbide pasienter krever tilsyn av opp mot 6 ulike spesialister før diagnose er stilt og adekvat behandling igangsatt. Fortsatt er interessen stor for å utdanne seg i en breddespesialitet, men rekrutteringen er vanskelig når det ikke finnes stillinger.
1.11.2021 var det 1.975 leger i Norge 1, 2 som hadde spesialiteten indremedisin. Den største av alle sykehusspesialitetene - og kun overgått av allmennmedisin med sine 4.181 spesialister. Man kunne forvente at indremedisin som fag gikk en trygg fremtid i møte, men slik er det ikke. En kartlegging i Helse Sør-Øst viser at det er få eller ingen overlegestillinger i indremedisin og antall utdanningsstillinger er tilsvarende lave. Det er liten grunn til å tro at det står bedre til i de øvrige helseregionene.
Årsakene til dette er sammensatte. Allerede i 2009 (ref) så man en trend hvor man var usikker på rollen til fremtidens indremedisinereutfordringer som ble skissert var blant annet;
• oppgaveglidning opp mot primærhelsetjenesten og sykepleiere med spisskompetanse
• endringer i sykehusstruktur med funksjonsfordelinger og mer spesialiserte sykehus
• flere krav fra pasienter om å få snakke med spesialister i «sitt» fagfelt
• raske faglige og teknologiske utviklinger innenfor de forskjellige grenspesialitetene som vanskeliggjør muligheten for å beholde en bredde i fagfeltet
Den tidligere ordningen med hovedspesialitet for indremedisin og grenspesialiteter på toppen ble etter tur skrinlagt i Danmark, Sverige og til sist Norge. Vi endret løpet for spesialistutdanningen i 2019. Hovedspesialiteten indremedisin ble sidestilt med de tidligere 8 medisinske grenspesialitetene, og i tillegg ble det opprettet en ny hovedspesialitet i Akutt- og mottaksmedisin. Imidlertid sikret man verken stillinger, klare arbeidsoppgaver eller læringsmål og kurs som gir kompetanse utover en avansert generell del i LIS 2.
Hva kan man så bruke en indremedisiner til? Vel, hva kan vi ikke bruke en indremedisiner til er svaret. Generalistene vil kunne ha en relevant rolle ved intensiv-
avdelinger, sengeposter, poliklinikker, tilsynsfunksjoner og som ledd i et tverrfaglig arbeid sammen med primær helsetjenesten. Og selvsagt ved vaktarbeid som skal dekke pasienter med sykdommer som sorterer under alle de nå 10 hovedspesialitetene. Hvor mange parallelle vaktlag kan man tillate seg i norske sykehus?

Indremedisinere bør også være med og sikre kompetanse på tilstander som ikke alltid passer inn under noen av de andre hovedspesialitetene (eksempelvis tilstander knyttet til ernæring, forgiftninger mm.). Dessuten bistå i vurdering av sammensatte pasienter med problemstillinger som strekker seg over flere fagområder, og ha hovedansvar for opplæring av LIS 2 for å sikre en generell kompetanse til de som skal videre i de andre hovedspesialitetene.
Hvordan blir så en sykehushverdag uten indremedisinere? Det holder å se til Danmark, som avskaffet spesialiteten indremedisin for ca 20 år

siden. Der ser man jevnlig situasjoner hvor multimorbide pasienter krever tilsyn av opp mot 6 ulike spesialister før diagnose er stilt og adekvat behandling igangsatt. Det er usikkert om noen tar ansvar for en helhetlig vurdering. En slik fragmentering fremstår verken spesielt pasientsikker eller økonomisk bærekraftig.

Som skissert i rapporten fra 2009 er det fremdeles liten interesse i sykehusene for å ha nødvendig kompetanse til å håndtere kompliserte, ofte sammensatte problemstillinger. Det er få (om noen) andre spesialiteter enn indremedisin som kan fylle denne rollen. Rapporten vektla også at spesialister i indremedisinen bidrar til fokus på tidlig adekvat behandling på lavest mulig omsorgsnivå. Samtidig vil de kunne
gjenkjenne når pasientene har behov for spesialkompetanse. Vi går inn i en tid i helsevesenet med økende mangel på hoder og hender. Krav til effektiv forvaltning av både menneskelige og økonomiske ressurser vil gjøre breddekompetanse enda mer relevant.
Rekruttering er vanskelig i en spesialitet hvor det verken finnes overlegestillinger eller utdanningsløp. Heldigvis er interessen for å utdanne seg i en spesialitet hvor man klarer å beholde bredden fortsatt stor blant yngre kollegaer. Vi er derfor optimistiske med tanke på rekruttering. Imidlertid må grunnleggende premisser som treffende læringsmål, gode mentorer og faglige forbilder samt tilgjengelige stillinger være på plass.
Hvis forutsetningene er til stede har vi tro på at indremedisin kan oppleve en renessanse og på ny få en sentral rolle på små og store avdelinger ved sykehusene i vårt langstrakte land.
Referanser
1. Spesialistutdanningen av leger (legeforeningen.no)
2. Legestatistikk (legeforeningen.no)
Nordøst på Hinnøya i Sør-Tromsø ligger den lille storbyen Harstad. Området har huset historiske hendelser helt siden vikingtiden, men den moderne grunnlegger av byen het Richard Kaarbø. Han skapte rammene for byutviklingen rundt skipsverftsindustrien på slutten av 1800-tallet. Området refereres ofte til som «Tore Hunds rike», som viser til vikinghøvdingen Tore Hund som fra sin gård på Bjarkøy ledet opprøret mot Olav Haraldsson ved Stiklestad.

I dag huser Harstad ca. 24 000 innbyggere, og ligger flott til innerst i Vågsfjorden, med små og store øyer og fjell på alle kanter. Mange regner historiske Trondenes kirke som den viktigste severdigheten, men også verdens eldste skonnert Anna Rogde tiltrekker seg mange besøkende hvert år.
Tidligere besøkt:
4-2022 Sykehuset Østfold
3-2022 Lillehammer
2-2022 Kongsberg
1-2022 Sandnessjøen
4-2021 Mo i Rana
3-2021 Arendal sykehus
2-2021 Haraldsplass
1-2021 Drammen sykehus
4-2020 Førde sentralsjukehus
3-2020 Ringerike sykehus
2-2020 Ålesund sykehus
1-2020 Lovisenberg diakonale sykehus
4-2019 Nordlandssykehuset Bodø

3-2019 Akershus universitetssykehus
2-2019 Bærum sykehus
1-2019 Finnmarkssykehuset Kirkenes
Harstad er den nest største byen i Troms og Finnmark, og kan tilby sine innbyggere det meste man måtte ønske seg. I juni arrangeres de årlige Festspillene i Nord-Norge, en ukeslang festival med bredt kulturmangfold som tiltrekker seg internasjonale artister og kunstnere. Resten av året har sitt eget festivalhjul, med alt fra litteraturfestival, filmfestival, klassisk musikkfestival og Bakgårdsfestivalen. Sommerhalvåret byr på midnattssol, mens nordlyset trollbinder både lokale og «søringer» vinterstid. Om man ikke får nok av naturen lokalt, ligger områdene Lofoten og Vesterålen kun 2-3 timers kjøring unna. Nord-Norges

Paris, også kalt Tromsø, er enkelt tilgjengelig med daglige hurtigbåtavganger. Nærmeste flyplass, Evenes lufthavn, deles med Narvik og er lokalisert 45 km fra sentrum.
Dagens sykehus i Harstad ble åpnet i 1977, og ligger sentrumsnært rett ovenfor bykjernen. Siden 2007 har sykehuset vært en del av Universitets sykehuset Nord-Norge. Det er i dag lokalsykehus for omtrent 45 000 innbyggere i Sør-Troms og nordlige del av Nordland, som fordeler seg på kommunene Harstad, Kvæfjord, Evenes, Skånland, Ibestad og Lødingen. Reiseveien kan for enkelte være lang, og det er også flere øyer uten fastlandsforbindelse i opptaksområdet.
Medisinsk avdeling har i dag 32 sengeplasser fordelt på to sengeposter, samt 3 senger i en egen palliasjonsenhet. Vi disponerer sengeplasser og har ansvar for pasienter i en felles medisinsk og
kirurgisk intensiv/overvåkningsavdeling. I tillegg rommer avdelingen en dialyseenhet med 14 plasser og en medisinsk dagenhet for kreftbehandling og øvrig spesialisert behandling for bl.a. hematologiske pasienter. Medisinsk poliklinikk har en bred aktivitet. Det er egen lungepoliklinikk, samt endoskopienhet med både gastro- og koloskopivirksomhet. Sykehuset har for øvrig generell kirurgisk og ortopedisk sengepost, gyn-/fødeavdeling og rehabiliteringsavdeling. Ved spesialistpoliklinikken er det fast ansatte leger innenfor revmatologi, øye, nevrologi og ØNH, samt ambulerende barnelege fra Tromsø. I et tilknyttet bygg finnes DPS med poliklinikk og døgnpost, samt BUP poliklinikk.


Avdelingen har 14 overlege- og 9 LIS2/3-stillinger, men per i dag går overlegene i 8-delt tertiærvakt og LIS2/3 i 12-delt sekundærvakt. Overlegene i avdelingen dekker spesialitetene gastroenterologi, lungemedisin, kardiologi, nefrologi og hematologi. Både overleger og LIS2/3 har døgnvakter med passiv tid på natt. Vi har 12 LIS1 i avdelingen som har to-delt vaktdøgn og tilstedevakt på natten. Avdelingen har i mange år hatt godt rykte på seg blant LIS1, og tiltrekker seg hvert halvår dyktige LIS1-kandidater som søkere. Det er mulig å gjøre hele LIS3 indremedisin i Harstad, samt store deler av LIS3-
løpet i gastroenterologi, kardiologi, geriatri, lungemedisin, hematologi samt akutt- og mottaksmedisin.
Medisinsk avdeling har i tillegg til de generell indremedisinske pasientene også ansvar for mottak av barn og pasienter med nevrologiske tilstander. Dette krever bred fagkunnskap, og lavterskel-kultur for samarbeid med andre spesialister ”på huset” og i Tromsø. Det er stort fokus på systematiserte team-mottak av de dårligste pasientene (medisinsk mottaksteam, slagalarm og barneBEST) samt ukentlig simuleringstrening både i akuttmottaket og på sengepost. Vi starter alltid dagen med et felles morgenmøte hvor både pasienter fra vakt og sengepost diskuteres. To dager i uken er det artikkelfremlegg på morgenen, i tillegg til felles undervisning hver torsdag ettermiddag.
Vi har også en egen forskningsenhet knyttet til avdelingen, med flere stipendiater og pågående studier knyttet til behandling med fecestransplantasjon for diagnoser som IBS, ME og sykelig overvekt. Faktisk driftes landets eneste avføringsbank her i Harstad! For de som ønsker å kombinere klinisk praksis og forskning, er det gode muligheter for dette.
Vegg i vegg med sykehuset bygges det nå et nytt kommunalt helsehus som skal stå ferdig i 2024. I samarbeid med UiT planlegges det også for at medisinstudenter fra Tromsø etter hvert skal kunne ta 5. og 6. studieår i Harstad. Vi har allerede i flere år hatt dyktige 5.års medisinstudenter i praksis hos oss flere uker i året, og en utvidelse av UiT sin virksomhet her vil være en stor styrke for fagmiljøet.

Utenom arbeidstid trekker mange ut og opp i fjellene, både med og uten ski på beina. Det er stor interesse for randonee-turer på vinteren, og fjellene rundt byen ligger så nært tilgjengelig at man nærmest kan ta på seg skiene hjemme! Nylig åpnet det også en splitter ny sykkelpark med pumptrack og preparerte terrengløyper, og interessen for sykling både i løyper og på fjellet er stadig økende. Hver høst og vår arrangeres Harstadkarusellen, en ukentlig løpekarusell med en viss intern prestisje i avdelingen hvor det varmt oppfordres til deltakelse. For de som trives mer bynært, har Harstad både kino og kulturhus med et rikholdig program.
Vi ønsker oss alltid nye og engasjerte kollegaer med interesse for indremedisin, og kan tilby et raust og inkluderende arbeidsmiljø lokalisert 68° nord!

Ved symptomatisk kronisk hjertesvikt hos voksne, nå uavhengig av ejeksjonsfraksjon (EF)1,2
Ved kronisk nyresykdom hos voksne1,2
Refusjonsberettiget bruk:
Behandling av pasienter med kronisk nyresykdom med bekreftet albuminuri (eGFR 25-75 mL/min/1.73m² og albumin/kreatinin-ratio i urin over 20 mg/mmol). U99: Nyresvikt kronisk N18: Kronisk nyresykdom. Vilkår 260: Refusjon ytes kun i kombinasjon med optimalisert behandling med RAAS-hemmer, enten ved bruk av ACEhemmer eller angiotensin II-reseptorblokker (ARB).

Utvalgt sikkerhetsinformasjon:
• Behandlingen skal avbrytes midlertidig hos pasienter innlagt på sykehus for større kirurgiske inngrep eller ved akutte, alvorlige medisinske sykdommer.
• Pasienter med albuminuri kan ha mer nytte av behandling med Forxiga. Ingen erfaring med behandling av kronisk nyresykdom hos pasienter uten diabetes som ikke har albuminuri.
• Begrenset erfaring med Forxiga i NYHA-klasse IV.
• Forsiktighet utvises der Forxiga-indusert blodtrykksfall kan utgjøre risiko.
European Society of Cardiology (ESC) 2021: eGFR (estimert glomerulær filtrasjonsrate) og uAKR (urin albumin-kreatinin ratio) er nødvendig for korrekt pasientkategorisering for kardiovaskulær risiko og utforming av forebyggende tiltak3,4

1 TABLETT DAGLIG 10 MG


EN TABLETT DAGLIG, TRE INDIKASJONER, INGEN TITRERING2 10 mg
FORXIGA® 10 MG (dapagliflozin) - VIKTIG INFORMASJON
Indikasjoner:
Behandling av utilstrekkelig kontrollert diabetes mellitus type 2 (T2D) hos voksne og barn ≥10 år, som tillegg til diett og fysisk aktivitet: Som monoterapi når metformin er uhensiktsmessig pga. intoleranse eller som tillegg til andre legemidler til behandling av T2D. Behandling av kronisk nyresykdom hos voksne.
Behandling av symptomatisk kronisk hjertesvikt hos voksne.
Anbefalt dosering: 10 mg 1 gang daglig. Det er ikke anbefalt å starte behandling ved GFR < 25 ml/min. Ved GFR < 45 ml/min skal ekstra glukosesenkende behandling vurderes hos T2D pasienter med behov for ytterligere glykemisk kontroll. Ved alvorlig nedsatt leverfunksjon er anbefalt startdose 5 mg.
Utvalgt sikkerhetsinformasjon:
• Forxiga 10 mg skal ikke brukes ved T1D, hos gravide eller ammende. Brukes med forsiktighet hos pasienter med økt risiko for diabetisk ketoacidose.
• Kan gi økt nyreutskillelse av litium. Pasienten skal henvises til forskrivende lege for overvåking av serumkonsentrasjon.
Bivirkninger: Svært vanlige: Hypoglykemi (når brukt med sulfonylurea (SU) eller insulin)). Vurder en lavere dose av insulin/ SU for å redusere denne risikoen ved T2D. Vanlige: Genitale infeksjoner, urinveisinfeksjoner. Mindre vanlige: Volumdeplesjon inkl. hypotensjon.Sjeldne bivirkninger: Diabetisk ketoacidose (ved T2D). Svært sjeldne: Fourniers gangren. Refusjonsberettiget bruk: Behandling av pasienter med kronisk nyresykdom med bekreftet albuminuri (eGFR 25-75 mL/ min/1.73m² og albumin/kreatinin-ratio i urin over 20 mg/mmol) Refusjonskoder: ICPC U99: Nyresvikt kronisk. ICD: N18 Kronisk nyresykdom. Vilkår 260: Refusjon ytes kun i kombinasjon med optimalisert behandling med RAAS-hemmer, enten ved bruk av ACEhemmer eller angiotensin II-reseptorblokker (ARB). Behandling av T2D i kombinasjon med andre perorale blodsukkersenkende legemidler og/eller insulin i tråd med godkjent preparatomtale. Refusjonskoder: ICPC: T90 Diabetes type 2. ICD: E11 Diabetes mellitus type 2. Vilkår 232: Refusjon ytes i kombinasjon med metformin til pasienter som ikke oppnår tilstrekkelig sykdomskontroll på høyeste tolererte dose metformin. Behandling av symptomatisk kronisk hjertesvikt med ejeksjonsfraksjon (EF) ≤ enn 40 % bestemt ved ekkokardiografi , angiografi , myokardscintigrafi , computertomografi (CT) eller magnettomografi (MR). Reseptgruppe C.
Pakninger og priser: 10 mg: 28 stk. kr 450. 98 stk. kr 1432,30.

For mer info. om Forxiga, les FK tekst på www.felleskatalogen.no eller godkjent SPC 03.02.2023
Ref. 1. www.felleskatalogen.no (22.02.23)
2. Forxiga, godkjent SPC 03.02.23 pkt. 4.1, 4,2
3.Visseren FLJ, Mach F, Smulders YM, et al. 2021 ESC Guidelines on cardiovascular disease prevention in clinical practice [published correction appears in Eur Heart J. 2022 Nov 7;43(42):4468]. Eur Heart J. 2021;42(34):3227-3337. doi:10.1093/ eurheartj/ehab484
4. Ortiz A, Wanner C, Gansevoort R, the ERA Council, Chronic kidney disease as cardiovascular risk factor in routine clinical practice: a position statement by the Council of the European Renal Association, Nephrology Dialysis Transplantation, 2022
Nasjonalt Diabetesforum arrangeres annethvert år i Oslo og samler vanligvis 5-700 leger og annet helsepersonell engasjert i diabetesbehandling til kunnskapsoppdatering og erfaringsutveksling over 3 dager i Oslo. Årets møte arrangeres fra 25. – 27. april og har både kjente norske og internasjonale foredragsholdere. Indremedisneren har tatt en prat med tidligere leder av Norsk indremedisinsk forening som er leder av Medisinsk Fagråd i Diabetesforbundet og sitter i programkomiteen for årets Diabetesforum.
- Indremedisineren: Hva skjer?
- Kåre Birkeland: De første halvannen dagene er satt av til forskning og vi presenterer et bredt utvalg av den forskning som foregår innen diabetesområde i Norge og internasjonalt. Konferansen åpner med et innlegg fra en av våre aller mest kjente internasjonale diabetesepidemiologer professor Ed Gregg fra Imperial College London som gir en oversikt over hva som er nytt i diabetesepidemiologien. Et annet høydepunkt på forskningsdelen av konferansen er et seminar om ny klassifikasjon/inndeling av diabetessykdommen med Professor Pål Njølstad fra Universitetet i Bergen og Professor Michal Roden fra German Diabetes Center i Düsseldorf. Videre subklassifisering av type 2 diabetes i 5 eller flere kategorier basert på genotyping eller dyp fenotyping er et hett tema for tiden og professor Roden er en av de som har mest innsikt i dette.
- Indremedisineren: er konferansen bare for forskere?
- Kåre Birkeland: Nei, absolutt ikke. Selv om starten er konsentrert om ny forskning, er også denne delen åpen for alle interesserte. Og hoveddelen av Diabetesforum fokuserer på behandling av pasienter med diabetes, både barn og voksne, type 1 og type 2. Det er selvsagt mye om den nye teknologien med glukosesensorer, insulinpumper og kombinasjonen av disse i «smarte pumper» som likner kunstig bukspyttkjertel. Jeg leder en plenumssesjon med tittelen «Å leve med og uten diabetes type 2» hvor vi fokuserer på de siste års forskning som viser at mange kan faktisk bli kvitt sin type 2 diabetes. Her stiller vi spørsmålene Hvem kan bli kvitt diabetes type 2? Hvordan oppnå normalt blodsukker med kostholdsendringer, medisiner eller bariatrisk kirurgi?

- Indremedisineren: Er det kun plenumssesjoner eller kan man også velge etter interesse?
- Kåre Birkeland: Det er en rekke parallellsesjoner man kan velge
mellom, etter bakgrunn, hvor man arbeider og hva man finner interessant. Noen eksempler er «Diabeteskomplikasjoner» med professor Tore Julsrud Berg, «Diabetes og psykisk helse» med Psykologspesialist PhD Ane Wilhelmsen-Langeland og «Godt hjerte for god behandling av diabetes» med professor Trond G. Jenssen.



- Indremedisineren: Lange dager med bare foredrag?
- Kåre Birkeland: Det viktigste på slike møter er jo å treffe andre som er interessert i diabetes og utveksle ideer og erfaringer til å ta med hjem. Vi er så glade for at vi denne gangen igjen kan arrangere fysisk møte. Jeg ser jo at folk elsker å møtes igjen etter at pandemien resulterte i at alle slike møter ble virtuelle. Så jeg vil oppfordre landets indremedisinere til å komme til Gardermoen på årets Diabetesforum. Husk at 20% av innlagte pasienter i sykehusene har diabetes og at sykdommen kan affisere nesten alle organsystemer!
Forskningsforum 25.-26. april presenterer det nyeste innen forskning på diabetes og relaterte tilstander. Over 30 forelesere fra Norge og utlandet står på programmet, her er noen høydepunkter:

• «News in diabetes epidemiology» ved Ed Gregg, Imperial College London, UK
• «A novel diabetes typology» ved Michal Roden, German Diabetes Center, Düsseldorf, Germany
• «The kidney in obesity and diabetes – a clinical challenge» ved Esteban Porrini, University of La Laguna, Spain
• «Stem cells for treatment of type 1 diabetes» ved Per-Ola Carlsson, Uppsala University
• «Can treatment with decidual stem cells modulate autoimmune processes?» ved Hanne Scholz, University of Oslo
• «Open-Source Automated Insulin Delivery in Type 1 Diabetes» ved Martin de Bock, University of Otago, New Zealand
• «Understanding the complexity of insulin resistance» ved Michael Ryden, Karolinska Instituted, Stockholm, Sweden
• «Diabetes and depression» ved Khalida Ismail, King’s College London, UK
Fagforum 26.-27. april fokuserer på praktisk kunnskap som deltakerne får nytte av i sin kliniske hverdag. Vel 50 fagpersoner fra flere yrkesgrupper foreleser, her er noen høydepunkter:
• «Fagseminar om fysisk aktivitet i regi av Norsk forening for allmennmedisin» ved Stian Lobben, allmennlege
• «Diabetes i Norge 2023», paneldebatt med endokrinologene Kåre I. Birkeland, Marianne Höglund, Torild Skrivarhaug og Grethe Ueland
• «Praktisk behandling av diabetes type 2» ved endokrinolog Sondre Vatne Meling og allmennlege Kjersti Nøkleby
• «Hybrid closed loop» ved Marianne Höglund, endokrinolog
• «Diabetes og kroppsbilde» ved Christine SundgotBorgen, postdoc, forsker Line Wisting og bruker
Emilie Kleven
• «Organisering av årskontrollen ved tre legekontor» ved fastleger fra Hillevåg, Fromeide og Brumunddal legesentre
• «Nyrene en hjertesak. Den kardiorenale problemstillingen» ved Trond G. Jenssen, nefrolog
• «Hvordan oppnå normalt blodsukker med medisiner?»
ved Kari Anne Sveen, endokrinolog
• «Diabetes type 1 og selvmord»
ved Ane Wilhelmsen-Langeland, psykologspesialist
• «Diabetes hos eldre − en oversikt»
ved Tore Julsrud Berg, endokrinolog
Lenke til nettsiden for nærmere informasjon og påmelding til Diabetesforum 2023: diabetes.no/for helsepersonell/konferanser/diabetesforum2023
Da er vi godt i gang med 2023, med sine utfordringer og muligheter. Det blir et nytt krevende år med krigen i Ukraina, energimangel med høye priser på strøm og bensin, økte matpriser, og økte renter. Dette har endret vår hverdag, flere sliter økonomisk, og dette rammer ikke minst mange av våre eldre. Det kan sekundært forverre en allerede skrantende helse. Eldre med dårlig råd kan velge å spare på mat og oppvarming, og utgifter til ulike sosiale aktiviteter og blir i større grad mer isolert hjemme. En del vil også takke nei til ulike hjemmetjenester, opphold på sykehjem og andre helseinstitusjoner.
Dette samtidig som vi har en stadig økende populasjon med eldre som lever stadig lengre, mange av disse med ulik funksjonssvikt og helseutfordringer, som medfører mye behov for ulike helsetjenester.
Det norske samfunnet er dårlig forberedt på dette. I mange år har man prioritert hjemmetjenestene og bruk av velferdsteknologi, på bekostning av oppbygging av sykehjemskapasiteten.
Noe kompenseres med at man har etablert omsorg pluss boliger og omsorgssentre, men stadig flere trenger allikevel en sykehjemsplass i siste del av livet.
Ikke minst er det en stor utfordring at antall med demenssykdom har økt og vil øke betydelig, og de fleste må på sykehjem i siste fase av sykdommen (som kan vare i mange år!). Aldring og helse har estimert at vi fra drøyt 100.000 med demens i dag, vil ha ca 190.000 i 2040, og ca 240.000 i 2050. Pr i dag har 80% av beboerne på sykehjem en demensdiagnose, primært eller i tillegg til annen sykdom og funksjonssvikt.
Utfordringene er tydeliggjort i vinterens presseoppslag om overfylte sykehus. Mange er pasienter med
høy alder, som er spesielt sårbare for akutt sykdom, som Covid og influensa. Av disse er en god andel ferdigbehandlet og venter på et videre opphold på sykehjem, til kommuner som ikke har ledige sykehjemsplasser.
I dette bildet vil geriatrien på sykehus, og kompetanse på eldremedisin og sykehjemsmedisin i kommunene være stadig viktigere. Vi mener at minst 25% av alle pasienter på en medisinsk avdeling er geriatriske, mens antall senger utgjør maks 10% selv på de sykehus som har etablert gode geriatriske avdelinger.
Dette er et fokus for oss i foreningen, og for hele det geriatriske fagmiljøet, som jobber for å få flere stillinger og senger på de ulike sykehusene.
Samtidig som det er en betydelig økning av eldre med stor funksjonssvikt og skrøpelighet, så er vår kompetanse økende etterspurt av andre fagområder. Ortogeriatri er etablert på en del sykehus, hvor vi har laget en nasjonal veileder sammen med ortopeder og anestesileger. Det arbeides nå med en nasjonal veileder for onkogeriatri, hvor det er tatt kontakt med de mest aktuelle fagområdene: onkologi, lunge/ hematologi, gastrokirurgi og anestesi.
Det er også økende etterspørsel etter perioperative vurderinger av eldre som skal gjennomgå ulike inavsive inngrep, og operasjoner. Her er allerede TAVI vurderinger av geriater og tverrfaglig team etablert på flere sykehus.
For øvrig hadde vi flere andre saker på sist styremøte, i januar.
Vi inviterte inn leder for vår Spesialitetskomite for gjennomgang av status for godkjenning av Helsedirektoratet av læringssteder for geriatri. I utgangspunktet hadde
kun OUS fått godkjenning, og de øvrige sykehusene måtte komplettere sine søknader. Dette er vel heller ikke helt ukjent innen andre fagområder. Prosessen er godt i gang, og det forventes at mange vil få godkjenning i denne omgang. Noen utvalgte sykehus må vurderes nærmere, sannsynligvis med besøk fra Spesialitetskomiteen.
Det var også en sak om prioriteringsveilederne. 16. januar innkalte Helsedirektoratet til et møte med spørsmål om prioriteringsveilederne i spesialisthelsetjenesten skulle avpubliseres. Fra geriatrien sendte vi et eget svar på dette, og professor Saltvedt ved St.Olav deltok på møtet. Vi var tydelige på at Prioriteringsveilederen fortsatt var nyttig for vårt fag, og alle andre fagområder som deltok på møtet, ønsket også å beholde sine veiledere. Imidlertid var det også bred enighet om av veilederne må evalueres og tilpasses dagens situasjon.
I geriatri har vi laget en overordnet veileder for hovedtilstander som henvises til poliklinisk vurdering, med tre hovedområder: demens med krevende diagnostikk eller symptombilder, rask utvikling av funksjonssvikt, og fallutredning.
Som ovenfor nevnt er vi stadig mer «etterspurt», og det vil være naturlig å tillegge preoperativ vurdering, inkludert vurdering av onkologisk behandling, vurdering av multifarmasi, og vurdering av funksjonsnivå/skrøpelighet og behandlingsnivå.
Som dere ser er mer enn nok å ta fatt på innen geriatrien, og vi ser fram til dette!
Med hilsen
Paal Naalsund Leder NFG, 03.02.23.

alirokumab
Muliggjør LDL-C måloppnåelse1
LDL-C >2,6 mmol/l FH - sekundærprevensjon
LDL-C >3,6 mmol/l FH - primærprevensjon
Krav til tidligere behandling:
Spesialistkrav:
* Gentest må være utført
Hyperkolesterolemi ved etablert aterosklerotisk sykdom** (sekundærprevensjon)
Med en av følgende risikofaktorer:
• tidligere hjerteinfarkt
• med tilbakevendende CV-hendelser
• diabetes mellitus
Uten tilleggsrisiko
Refusjon ytes når alirokumab brukes som tillegg til statin og/eller ezetimib hos pasienter som ikke oppnår LDL-nivåer under grenseverdiene nevnt ovenfor. Se følgende krav ***
Forskrivning skal være instituert av spesialist i indremedisin, kardiologi, endokrinologi, geriatri, nevrologi eller av lege ved tilsvarende sykehusavdeling.
** Sekundærprofylakse etter akutt koronarsykdom (hjerteinfarkt, ustabil angina med sykehusinnleggelse), koronar- eller annen arteriell revaskularisering, angina pectoris, ischemisk hjerneslag eller symptomatisk perifer arteriell sykdom
*** For brukere som tåler statiner: Høyeste tolererbare dose statin i kombinasjon med ezetimib. For brukere som ikke tåler statiner (statinintoleranse): Minst to forskjellige statiner i laveste dose i kombinasjon med ezetimib. Intoleranse må dokumenteres i journal av forskrivende lege. Ved absolutt kontraindikasjon mot statiner: ezetimib i monoterapi.
Refusjonskoder ICD: -26 etablert aterosklerotisk sykdom ( sekundærprevensjon) og E78 ren hyperkolesterolemi. ICPC: -26 etablerte atersklerotisk sykdom og T93 hyperkolesterolemi
Ref 1: https://www.felleskatalogen.no/medisin/blaarev-register/c10ax14-1 ( 20.01.2023)
Lipidmodifiserende middel, humant monoklonalt antistoff (IgG1).
ATC-nr.: C10A X14
INJEKSJONSVÆSKE, oppløsning 75 mg/ml, 150 mg/ml og 300 mg/2 ml: Hver ferdigfylt penn (1 ml) inneh.: Alirokumab 75 mg, resp. 150 mg og 300 mg, histidin, sukrose, polysorbat 20, vann til injeksjonsvæsker.1
PRALUENT er indisert ved:
Primær hyperkolesterolemi eller blandet dyslipidemi: Til voksne med primær hyperkolesterolemi (heterozygot familiær og ikke-familiær) eller blandet dyslipidemi, som tilleggsbehandling til diett: I kombinasjon med et statin eller statin med annen lipidsenkende behandling hos pasienter som ikke oppnår LDL-kolesterol (LDL-C)-mål med høyeste tolererte dose av et statin, eller alene eller i kombinasjon med annen lipidsenkende behandling hos pasienter som er statinintolerante, eller der et statin er kontraindisert. Påvist aterosklerotisk kardiovaskulær sykdom: Til voksne med påvist aterosklerotisk kardiovaskulær sykdom for å redusere kardiovaskulær risiko ved å senke LDL-C-nivåene, som tillegg til korreksjon av andre risikofaktorer: I kombinasjon med den maks. tolererte dosen av et statin med eller uten andre lipidsenkende behandlinger, eller, alene eller i kombinasjon med andre lipidsenkende behandlinger hos pasienter som er statinintolerante, eller der et statin er kontraindisert. For informasjon om studieresultater i forhold til effekt på LDL-C, kardiovaskulære hendelser og studerte pasientgrupper, se SPC. Dosering: Vanlig oppstartsdose er 75 mg 1 gang hver 2. uke. Hvis ønsket LDL-C-reduksjon er >60%, gis 150 mg 1 gang hver 2. uke, eller 300 mg 1 gang hver 4. uke (månedlig).
Utvalgt sikkerhetsinformasjon:
Bivirkninger: Vanlige (≥1/100 til <1/10): Generelle: Reaksjon på injeksjonsstedet inkl. erytem/rødhet, kløe, hevelse, smerter/ømhet. Hud: Kløe. Luftveier: Tegn og symptomer fra de øvre luftveiene inkl. smerter i orofarynks, rhinoré, nysing. Sjeldne (≥1/10 000 til <1/1000): Hud: Nummulært eksem, urtikaria. Immunsystemet: Overfølsomhet, overfølsomhetsvaskulitt. Ukjent frekvens: Generelle: Influensalignende sykdom. Hud: Angioødem. Kontraindikasjoner: Overfølsomhet for innholdsstoffene. Forsiktighetsregler: Brukes med forsiktighet ved alvorlig nedsatt lever- eller nyrefunksjon. Interaksjoner: Klinisk relevante interaksjoner forventes ikke.
Pakninger og listepriser:

75 mg/ml: 2 stk. kr 4638,90. 6 stk. kr 13855,50. 150 mg/ml: 2 stk. kr 4638,90. 6 stk kr 13855,50. 300 mg/2 ml: 3 stk. kr 13855,50.
Refusjonsprisen er rabattert: Anbudskode: 2380
Basert på SPC godkjent av SLV: 10.06.2022
For fullstendig informasjon les godkjent FK-tekst eller SPC for Praluent
LOKELMA (NATRIUMZIRKONIUMSYKLOSILIKAT)
Kaliumnivået reduseres 1 time etter inntak^3 (Hvis normokalemi ikke oppnås etter 72 timer, bør andre behandlingsstrategier vurderes)

Lokelma har ingen smak4
Kan inntas med eller uten mat, og administreres sammen med andre medisiner (som ikke har ph-avhengig biotilgjengelighet#5)
Utvalgt sikkerhetsinformasjon: De vanligste bivirkningene er hypokalemi (4,1%) og ødemrelaterte hendelser (5,7%). Serumkaliumnivå bør monitoreres ved klinisk indikasjon også etter endring av legemidler som påvirker serumkaliumkonsentrasjonen (eks. ved RAASi eller diuretika) og etter at Lokelma-dosen er titrert. Monitoreringshyppighet vil avhenge av bl.a. andre legemidler, progresjon av kronisk nyresykdom og kaliuminntak i kosten. Ved alvorlig hypokalemi skal Lokelma seponeres og pasienten revurderes. Hvis normokalemi ikke oppnås etter 72 timer, bør andre behandlingsstrategier vurderes. Perforert tarm er sett. Bruk under graviditet bør unngås.
LOKELMA (NATRIUMZIRKONIUMSYKLOSILIKAT) – VIKTIG INFORMASJON
VIL DU VITE MER? REGISTRER DEG VIA QR-KODEN OG FÅ TILGANG TIL

NYHETER OG INFORMASJON FRA ASTRAZENECA
Indikasjon: Behandling av hyperkalemi hos voksne. Dosering: Korrigeringsfase: Anbefalt startdose er 10 g 3 ganger daglig. Når normokalemi er oppnådd bør vedlikeholdsdosering følges. Hvis normokalemi ikke oppnås etter 72 timer med behandling, bør andre behandlingsstrategier vurderes. Vedlikeholdsfase: Når normokalemi er oppnådd, skal den laveste effektive dose fastsettes. Anbefalt startdose 5 g 1 gang daglig. Ved behov kan dosen titreres opp til 10 g en gang daglig, eller ned til 5 g annenhver dag. Vedlikeholdsdosen bør ikke overskride 10g en gang daglig. Kronisk hemodialyse: Lokelma skal kun gis på dager uten dialyse. Anbefalt startdose er 5 g en gang daglig. For å etablere normokalemi kan dosen titreres ukentlig opp eller ned, basert på predialytisk serum-kaliumnivå etter et langt interdialytisk intervall/LIDI. Dosen kan justeres med en ukes intervall, i trinn på 5 g, opp til en dose på 15 g en gang daglig på dager uten dialyse. Det anbefales å overvåke serum-kaliumnivå ukentlig under dosejustering. Administrering: Doseposens innhold blandes med ca. 45 ml vann, og væsken drikkes mens den ennå er uklar. Refusjon: H-resept Refusjonsberettiget bruk: Der det er utarbeidet nasjonale handlingsprogrammer/nasjonal faglig retningslinje og/eller anbefalinger fra RHF/LIS spesialistgruppe skal rekvirering gjøres i tråd med disse. Vilkår: 216 Refusjon ytes kun etter resept fra sykehuslege eller avtalespesialist. - Hyperkalemi hos pasienter med hjertesvikt: Natriumzirkoniumsyklosilikat (Lokelma) innføres til behandling av hyperkalemi ved serumkalium nivå ≥ 6 mmol/l hos voksne med hjertesvikt. Vedtak fattet i Beslutningsforum 26.10.2020 - Lokelma inngår i RHF anbefalinger til vedlikeholdsbehandling hos pasienter med kronisk nyresykdom som får hyperkalemi på grunn av behandling med hemmere av renin-angiotensinsystemet. For legemidlene under skal denne rangeringen legges til grunn for de ulike doseringene: Rangering – Legemiddel - Årskostnad – Avtalepris – Dosering. 1. valg Patiromersorbitekskalsium (Veltassa, Vifor) 8,4 g daglig / 16,8 g daglig. 2. valg Natriumzirkoniumsyklosilikat (Lokelma, AZ) 5 g daglig / 2 x 5 g daglig / 10 g daglig. Der det foreligger en rangering, skal førstevalg benyttes i oppstart og medisinsk begrunnet endring av behandling. Dersom førstevalg ikke kan brukes av medisinske årsaker, skal det begrunnes i pasientens journal. Vedtaket gjelder i perioden 01.06.2022 - 31.05.2024. Pakninger og priser: 5 g 30 stk. (dosepose) 3264,20; 10 g 30 stk. (dosepose) 6492,10. Reseptgruppe C. For fullstendig informasjon, les FK-tekst eller SPC godkjent 10.01.23 for Lokelma.
^ Placebokontrollert vedlikeholdsstudie som studerte 258 pasienter med hyperkalemi. Reduksjon i S-kalium ble sett 1 time etter første dose på 10 g Lokelma. Median-tid til normokalemi var 2,2 timer.3
# Natriumzirkoniumsyklosilikat bør administreres minst 2 timer før eller 2 timer etter orale legemidler med klinisk betydningsfull gastrisk pH-avhengig biotilgjengelighet som takrolimus, azolantimykotika, HIV-legemidler og tyrosinkinasehemmere.4

* Hjertesvikt: innført av Beslutningsforum for behandling av hyperkalemi ved hjertesvikt ved serumkalium nivå lik eller høyere enn 6 mmol/l hos voksne med hjertesvikt 6
Ref 1. McDonagh TA, Metra M, Adamo M. 2021 ESC Guidelines for the diagnosis and treatment of acute and chronic heart failure. European Heart Journal 2021, ehab368, https://doi.org/10.1093/eurheartj/ehab368
Norsk endokrinologisk forening har som strategi å bedre samarbeidet med pasientforeningene. På vårt styremøte i januar hadde vi invitert Morbus Addison Foreningen (MAF) som representerer pasienter med hypofyse- og binyresykdommer og Interessegruppen for hypofyse og binyre.


MAF ble etablert i 1989 som en pasientforening for personer med binyrebarksvikt, men har etterhvert utvidet arbeidet til å også omfatte pasienter med hypofysesykdommer. De 5 hoveddiagnosene som MAF representerer er binyrebarksvikt, hypofysesvikt, kongenitt adrenal hyperplasi (CAH), Cushings syndrom, og akromegali. På bakgrunn av dette arbeider foreningen med å bytte til et navn som reflekterer denne endringer.
MAF, representert ved leder Ida Knudzon og sekretær Laila Ertnes kunne fortelle om en aktiv foreningen med mange aktiviteter. Ved utgangen av 2022 hadde MAF 961 medlemmer med foreninger i de fleste fylker. De har oppdaterte hjemmesider (www. addison.no) og utgir medlemsbladet
«Barken» 3 ganger i året, både på papir og digitalt. MAF driver et aktivt likemannsarbeid og har for tiden 38 likepersoner fordelt over hele landet.
MAF arrangerer en rekke kurs og møter, fylkesmøter, regionkonferanser og annet hvert år, en nasjonal konferanse. De har også egne samlinger for familier og ungdommer. MAF samarbeider med Funksjonshemmedes fellesorganisasjon (FFO) og Funkis (studieforbundet for funksjonshemmede). De er også engasjert internasjonalt i Eurodis (Europeisk organisasjon for sjeldne diagnoser) og WAPO (Verdensorganisasjon for hypofysesykdommer).

Et av temaene som ble diskutert var udekkede behov – hva ønsker MAF at det skal forskes mer på? Et behov som ble fremmet var mer forskning på trøtthet («fatigue »), noe mange av medlemmene sliter med og som begrenser livskvaliteten. MAF opplyste også om sitt forsknings- og utviklingsfond på 500 000 kr som kan søkes om forskningsstøtte. Fristen i år er 17.03.2023.
Et annet tema var brukerrepresentasjon, der MAF gjerne vil bidra aktivt i søknader og forskningsprosjekter. Forespørsler om brukerrepresentasjon ønsker de skal gå gjennom MAF sitt styre. Henvendelser kan rettes til lederen i foreningen. Et annet konkret tiltak som kom ut av møtet var at MAF vil sende en representant på burkermedvirkningskurs ved OUS.
MAF ønsker også artikler fra vårt miljø for publisering i «Barken» og vi sender oppfordringen videre til våre interessegrupper. Det ble videre diskutert å arrangere «Møt pasienten»-innlegg til vårt årlige vintermøte. Vi tar det med videre i planleggingen av vintermøtet i 2024.
Avslutningsvis ble det bestemt at vi bør ha et årlig møte mellom Norsk endokrinologisk forening / Interessegruppen for hypofyse og binyre, og MAF for å føre videre det gode samarbeidet.
For foreningen, Eystein
Husebye NestlederLangtidsvirkende insulinanalog og GLP-1-analog i én penn til behandling av diabetes type 2
Reduserer HbA1c1* Reduserer kroppsvekt1**
Reduserer risiko for hypoglykemi1***
Sammenlignet med Lantus® (insulin glargin 100 enheter/ml)1
Avslutt nåværende behandling med Insulatard®
start opp med Xultophy® 16 dosetrinn2
Maksimal daglig dose av Xultophy® er 50 dosetrinn2
* -1,8% vs -1,1% reduksjon i HbA1c. Estimert forskjell: -0,59 (95% KI: -0,74; -0,45), p<0,0001. ** -1,4 kg vs. 1,8 kg endring i kroppsvekt. Estimert differanse: -3,2 kg (95% KI: -3,77; -2,64), p<0,0001. *** 57% lavere forekomst. 2,23 vs 5,05 per pasientår. Estimert ratio: 0,43 (95% KI: 0,30; 0,61), p<0,0001.

Xultophy ® er indisert til behandling av voksne med utilstrekkelig kontrollert diabetes mellitus type 2 for å forbedre glykemisk kontroll som tillegg til diett, fysisk aktivitet og andre orale legemidler til behandling av diabetes. For resultater fra studier vedrørende kombinasjoner, effekt på glykemisk kontroll og populasjoner som ble undersøkt, se SPC pkt. 4.4, 4.5 og 5.1
• Gastrointestinale bivirkninger, inkludert kvalme, oppkast og diare er vanlige (≥1/100 til <1/10 brukere). Forekommer oftest i begynnelsen av behandlingen og reduseres vanligvis i løpet av få dager eller uker med fortsatt behandling. Ta forhåndsregler for å unngå væskemangel
• Hypoglykemi er en hyppig rapportert bivirkning (≥1/10 brukere). For høy dose i forhold til behovet, utelatelse av et måltid eller ikke planlagt anstrengende fysisk aktivitet kan gi hypoglykemi. Vurdér dosereduksjon av sulfonylurea ved samtidig bruk
• Øyesykdom: Intensivering av behandling med insulin, en komponent av Xultophy®, med umiddelbar forbedret glykemisk kontroll kan være forbundet med en forbigående forverring av diabetisk retinopati, mens langvarig forbedret glykemisk kontroll reduserer risikoen for progresjon av diabetisk retinopati.
• Hud- og underhudssykdommer: Pasienter må instrueres i å utføre kontinuerlig rotering av injeksjonssted for å redusere risikoen for å utvikle lipodystrofi og kutan amyloidose. Det har blitt rapportert hypoglykemi etter plutselig endring i injeksjonssted til et område uten reaksjoner. Overvåking av blodglukose anbefales etter endring av injeksjonssted fra et område med reaksjoner til et område uten reaksjoner, og dosejustering av antidiabetika kan vurderes.
Dosering2
Xultophy® gis én gang daglig ved subkutan administrasjon.
Xultophy® kan benyttes Xultophy® anbefales ikke
Alder Voksne, inkludert eldre Hos eldre (≥65 år): Måling av glukose må intensiveres, og dosen justeres individuelt
Nyrefunksjon Lett, moderat eller alvorlig nedsatt. Måling av glukose må intensiveres, og dosen justeres individuelt
Hjertesvikt
Barn/ungdom under 18 år
Terminal nyresykdom (eGFR < 15)
NYHA klasse I-III NYHA klasse IV
Leverfunksjon Mild og moderat nedsatt Måling av glukose må intensiveres, og dosen justeres individuelt.
Alvorlig nedsatt
Skal ikke brukes hos pasienter med diabetes mellitus type 1 eller til behandling av diabetisk ketoacidose.
Xultophy® skal doseres i overensstemmelse med pasientens individuelle behov. Dosejustering gjøres basert på fastende plasmaglukose. Ved overgang fra behandling med basalinsulin eller GLP-1-analog er anbefalt startdose av Xultophy® 16 dosetrinn. Maksimal daglig dose av Xultophy® er 50 dosetrinn.
1 enhet insulin degludec + 0,036 mg liraglutid 50 DOSETRINN = =
1 DOSETRINN 50 enheter insulin degludec + 1,8 mg liraglutid
Reseptgruppe, refusjonsvilkår og pris5,6
Langtidsvirkende insulinanalog + GLP-1-analog. ATC-nr.: A10A E56
Refusjonsberettiget bruk
Behandling av voksne med diabetes mellitus type 2 i kombinasjon med metformin når metformin kombinert med en GLP-1-reseptoragonist eller basalinsulin ikke gir adekvat glykemisk kontroll.
Refusjonskode:
ICPC Vilkår nr ICD Vilkår nr
T90 Diabetes type 2 225 E11 Diabetes mellitus type 2 225
Pakninger og priser:
3 × 3 ml (ferdigfylt penn) kr 1399,30 (pris per september 2021)
Vilkår: 225 Refusjon ytes kun til pasienter som ikke oppnår tilstrekkelig sykdomskontroll på høyeste tolererte dose metformin.
For ytterligere informasjon se fullstendig preparatomtale eller www.felleskatalogen.no

Giftinformasjonens mandat er å samle og systematisere kunnskap slik at privatpersoner og helsepersonell raskt kan få riktig informasjon om symptomer og behandling tilpasset den akutte eksponeringen. I tillegg er vi en del av den nasjonale beredskapen ved kjemiske ulykker.
Forgiftningspasienter møter helsepersonell i både primær- og spesialisthelsetjenesten. De kan være eksponert for legemidler, kjemikalier i produkter til bruk i hjemmet og i arbeidslivet, rusmidler, planter og sopp. Noen har ved uhell fått etsende stoffer på øyet, andre har pustet inn branngasser, forsynt seg med legemidler fra bestemors håndveske eller har tatt en stor tablettmengde fordi livet kjentes for tøft.
Giftinformasjonen mottar årlig nær 50 000 henvendelser fra privatpersoner, arbeidsplasser og helsetjenesten. Hvert enkelt helsepersonell har ofte begrenset erfaring med disse eksponeringene. Tilbakemeldingene er tydelige på at det er behov for at Giftinformasjonen samler kunnskap og erfaring så helsepersonellet raskt får beslutningsstøtte. De som besvarer henvendelsene på Giftinformasjonen er farmasøyter, veterinærer, leger og toksikologer som i tillegg har spisskompetanse og er opplært til rådgivning innen klinisk toksikologi.
Foreldre søker råd etter uhell der småbarn har utforsket verden og fått i seg - eller på seg – «noe». Da er det viktig med raske svar på hva de skal gjøre og om det er behov for å kontakte helsetjenesten. I 2022 ble vi kontaktet nesten 11 400 ganger etter slike eksponeringer hos barn under 5 år. Vårt arbeid med å samle og oppdatere kunnskap slik at vi kan gi gode faglige råd avlaster den øvrige helsetjenesten. Av alle våre akutte henvendelser får om lag 60 %
råd som gjør at de ikke har behov for oppfølging av lege/sykehus.
Kunnskapskilder som raskt gir en samlet god oversikt til helsepersonell som håndterer akutte forgiftninger, er ikke alltid tilgjengelige. Oppslagsverk, åpne og lukkede databaser, artikler, lærebøker, epikriser og datablader inneholder relevant informasjon, men informasjonen ligger fragmentert og ofte mangler de gode studiene på denne pasientgruppen. Giftinformasjonen samler dette og gjør vurderinger som brukes i rådgivningen til norske leger i en travel klinisk hverdag – det være seg på legevakt, i akuttmottaket eller på intensivavdelingen. Fordi det er begrenset erfaring med mange forgiftninger, er vi avhengige av – og takknemlige for – innspill fra våre kliniske brukere slik at våre anbefalinger kontinuerlig forbedres. Takk til alle dere som gir oss slike tilbakemeldinger!
Nettinformasjon er et viktig supplement til telefontjenesten. Derfor har vi utarbeidet over 400 artikler om håndtering av vanlige hendelser tilpasset særlig småbarnsforeldre på www. giftinfo.no. Med over 600 000 besøk hvert år, avlaster dette telefontjenesten og reduserer ventetiden for dem som ringer når det haster. I tillegg publiseres behandlings anbefalinger vi har utarbeidet for utvalgte vanlige eller spesielt toksiske agens på Helsebiblioteket. I de identiske forgiftningskapitlene i Felleskatalogen og Norsk legemiddelhåndbok samler vi svært kortfattet informasjon om legemidler og enkelte andre

agens, beregnet for helsepersonell. Nettinformasjonen vil aldri dekke alt, og oppdatering er en utfordring, men med over 300 000 sidevisninger på forgiftningssidene i Helsebiblioteket og positive tilbakemeldinger, må dette prioriteres videre. På helsebiblioteket har vi også Antidotdatabasen med informasjon om bruk av antidoter og oversikt over hvor de skal være lagret - til bruk ved akutte mangelsituasjoner.
Giftinformasjonen (den gang «Giftkartoteket») ble opprettet som en selvstendig enhet i 1961, i 2001 ble den innlemmet i Helsedirektoratet og fra 2015 overført til Folkehelseinstituttet (FHI) (1). Organiseringen i FHI er naturlig, gitt at tjenesten er nasjonal og skal bistå både befolkningen, primærhelsetjenesten og spesialisthelsetjenesten. Alle brukerne har behov for råd basert på den samme kunnskapen, så det er effektivt at spisskompetansen er samlet i en enhet som alle kan kontakte.
I FHI er vi nå organisert sammen med fagmiljøer med spisskompetanse på kronisk toksikologi. Vi ser at dette gir muligheter til helhetlig rådgivning, særlig ved kombinerte akutte/ kroniske problemstillinger. I tillegg gir nærheten til smittevernmiljøet synergier: Det er mange likheter ved håndtering av hendelser, uavhengig av agens og internasjonalt arbeides det i stor grad med slik «all hazards approach».
Giftinformasjonen AME CBRNE Universitetetsfunksjon
Internasjonalt nettverk for informasjon/bistand 24/7
Undervisning, kurs, forskning, samfunnskontakt
Bistå spesialisthelsetjeneste og nødetater i akuttfasen
Beredskap C -hendelser Professorat
Bistå allmennhet og primærhelsetjeneste
Klinisk kompetanse Annen beredskap
• B iologiske agens
• RN -hendelser (atomhendelser)
• E ksplosiver med stort farepotensial
Medisinstudenter
Stipendiater
Innovasjon
Forenklet fremstilling av de 4 «søylene» i vårt nasjonale miljø for klinisk toksikologi (C-hendelser innen CBRNE-terminologien). CBRNE og Universitetsfunksjonen (UiO) er organisert i AME - som igjen samarbeider nært med Giftinformasjonen. Dette gir god samhandling, synergier og samfunnsøkonomi – men også sårbarhet hvis en av «søylene» svekkes.
Kliniske bakvakter
Av de nesten 50 000 henvendelsene årlig som kommer til Giftinformasjonens primærvakter, er det nær 5600 henvendelser fra sykehus, og 1500 av disse håndteres videre av - eller i samråd med - våre kliniske bak vakter. Vaktgående leger kan da rådføre seg direkte med våre bakvakter over mobil (i snitt to kontakter per pasient). Ofte følger en nøytral SMS senere om hvordan det gikk. I enkelte tilfeller kan dette utløse publikasjoner i form av abstracts, case reports (2) eller deltagelse i studier (3). De er også behjelpelige med slides/fagstøtte ved bruk av slike caser i egen internundervisning – noe som blir godt mottatt.
På dagtid dekkes behovet for klinisk bakvakt og annen relevant klinisk kompetanse av en 50% overlegestilling på Akuttmedisinsk avdeling (AME), Medisinsk klinikk på OUS. På vaktdøgnet dekker 6 overleger i deltidsstillinger denne kliniske bakvaktfunksjonen. AME er det akutt-/ intensivmiljøet som behandler de mest kompliserte forgiftninger i Helse Sør-Øst, i tillegg til sitt lokale opptaksområde. Bakvaktenes bakgrunn som intensivleger er også nyttig i grensesnittet forgiftning/annen diagnose hos «dårlig pasient» - ofte med sepsis, alkoholisk ketoacidose eller en sjelden gang encefalitt ved koma av ukjent årsak som differensialdiagnoser.
Giftinformasjonen og AME har helt siden oppstarten i 1961 vært tett integrert, og den kliniske kompetansen fra dette miljøet er en forutsetning for at anbefalingene fra Giftinformasjonen er klinisk relevante og godt tilpasset norske forhold.
De kliniske bakvaktene bringer inn klinisk kompetanse på behandling av forgiftningspasienter. Som en del av bakvaktsteamet ved Giftinformasjonen får man mer – og bredere - erfaring gjennom dialogen med behandlende leger over hele landet. De kliniske bakvaktene deler sin erfaring og kunnskap med hverandre, og de er engasjert i kliniske toksikologimiljøer også internasjonalt (4,5).
Beredskapsfunksjonen
Flere land er interessert i den norske modellen innen klinisk toksikologi («C-hendelser» innen CBRNE) som består av 4 «søyler» med tette forbindelse til hverandre (se figur). Dette skaper positive faglige synergier for alle miljøene – og gir i tillegg en god samfunnsøkonomi.
Søyle 1. Kunnskapsinnhenting og rådgivning til befolkning og helsetjenesten 24/7 (Giftinformasjonen). Søyle 2. Et klinisk akutt-/intensivmiljø som behandler de dårligste forgiftningspasientene ( AME ).
Søyle 3. Nasjonal behandlingstjeneste for CBRNE-medisin
(CBRNE senteret ). Etter våre nasjonale prinsipper innen beredskap der nærhet, likhet, ansvar og samvirke styrer, ble dette senteret lagt til AME, OUS, fordi den sivile driften her er (nært) knyttet opp til behandlingen av forgiftninger (kjemiske hendelser innen CBRNE). Dermed er likhetsog ansvarsprinsippet også oppfylt – og samvirket mellom de fire søylene sikrer en god beredskapsfunksjon.
Giftinformasjonen får mange henvendelser etter små og mellomstore kjemikaliehendelser, og det er tett dialog med CBRNE senteret slik at vi får en koordinert respons.
Søyle 4. Et ønske om akademisk systematikk og forbedring av forgiftningsbehandlingen i Norge førte til opprettelsen av et professorat i klinisk toksikologi ved AME i 1996 (det eneste i Norge innen fagområdet). Dette har resultert i en rekke internasjonale publikasjoner av høy kvalitet, solid internasjonalt samarbeid, bidrag inn i en rekke doktorgrader, medvirkning i utvikling av en viktig antidot (fomepizol mot bla. toksiske alkoholer) og innovasjonsforskning med pasientnær diagnostikk av metanolforgiftninger via «strips» (6,7). Dette har medført et sterkt forskningsmiljø hvor alle «søylene» i vårt fagmiljø er ivaretatt og nyter godt av synergieffektene (8).
Fremtidsutsikter
Gode funksjoner bygges over tid –men kan rives ned på forbausende kort tid.
De fleste i «verdens beste helsevesen» forstår utfordringene som nylig ble presentert av Helsepersonellkommisjonen. FHI har også fått et stort budsjettkutt, og nattestenging av Giftinformasjonen ble vurdert. Vi mottok da mange tilbakemeldinger fra engasjert helsepersonell som advarte mot konsekvensen av nattestenging. Mange av tilbakemeldingene var fra leger innen Akutt- og Mottaksmedisin (AMM) og indremedisinske fag som jo behandler de fleste innlagte forgiftningspasientene

Referanser:
1 Jacobsen D, Rygnestad T, Muan B, Andrew E. Giftinformasjonen 50 år – forgiftningsbehandling før og nå. Tidsskr Nor Legeforen 2011;131:1915-7.
2 Bygdnes L, Kildahl-Andersen O, Berg J, Skjerdal J, Jacobsen D. Blyhagl til besvær. Tidsskr Nor Legeforen 2005;24:3421-3.
3 Lao YE, Vartdal T, Froyshov S, Latimer B, Kvaerner C, Mataric M, Holm P, Foreid S, Jacobsen D, McMartin KE, Hovda KE. Fomepizole dosing during continuous renal replacement therapy, an observational study.
her i landet (9). Toppledelsen i FHI besluttet (ultimo januar) at risikoen ved nattestenging ble for høy, slik at Giftinformasjonen fortsetter som døgnåpen tjeneste.
Neste utfordring mot vår velfungerende «søylesynergi» kom nylig fra Universitetet i Oslo som vil endre professoratet i klinisk toksikologi til «Akuttmedisin». Hvorvidt dette er starten på en oppsmuldring av et møysommelig opparbeidet og velfungerende nasjonalt beredskaps- og fagområde, gjenstår å se.
Oppsummering
Giftinformasjonen er med på å hindre unødvendige henvendelser/
Clin Toxicol (Phila) 2022;60(4):451-7.
4 Lao YE, Diep PB, Huong LT, Hien NV, Hovda KE. Methanol content in homemade alcohol from a province in North Vietnam. Drug Alcohol Rev 2019;38(5):537-542.
5 Pronczuk J, Haines JA, Jacobsen D, Meredith TJ. Evaluation of antidotes: Activities of the International Programme on Chemical Safety. J Toxicol Clin Toxicol 1997;35:333-43.
6 McMartin KE, Sebastian CS, Dies D, Jacobsen D. Kinetics and metabolism of fomepizole in healthy
innleggelser til legevakt/sykehus – og å formidle informasjon og råd til de som trenger helsehjelp. Som samarbeidspartner jobber vi først og fremst for å gi beslutningsstøtte til helsepersonell i primær- og spesialisthelsetjenesten inkludert landets vaktgående leger 24/7. I tillegg utgjør vi en av 4 «søyler» i vårt nasjonale miljø innen klinisk toksikologi. Vår erfaring – basert på tilbakemeldingene fra de kliniske fagmiljøene - er at dette samarbeidet fungerer godt til beste for pasientene. Små fagmiljøer er imidlertid sårbare – men vi håper at fortsatt støtte fra landets kliniske miljøer vil bidra til at vi «står han av» også i fremtiden.
humans. Clin Toxicol 2012;50(5):375-83.
7 Hovda KE, Lao YE, Gadeholt G, Jacobsen D. Formate test for bedside diagnosis of methanol poisoning. Basic Clin Pharmacol Toxicol 2021; 129(1):86-88.
8 Haga C, Stokke MO, Tuv SS, Zahl PH, StenbergNilsen H. Legemiddelsikkerhet ved bytte av digitalispreparat Norge. Tidsskr Nor Legeforen 2016;136: 1714-8. doi: 10.4045/tidsskr.15.0161
9 Tosterud M, Hovda KE. Giftinformasjonen gir trygghet og redder liv. Tidsskr Nor Legeforen 2023; 2:113.
▼Vyndaqel (tafamidis) er nå på H-resept, finansiert av det regionale helseforetaket (RHF)


Refusjonsberettiget bruk:
1. Oppstart av behandling kan kun gjøres av kardiolog med erfaring i behandling av transtyretin amyloidose (ATTR), ansatt ved universitetssykehus eller annet helseforetak med kardiologisk enhet med kompetanse på behandling for denne pasientgruppen.
2. Pasienten må ha en sikkert diagnostisert ATTR kardiomyopati, vanligvis med nukleærmedisinsk påvist amyloid i myokard. Pasienten skal ved oppstart være i NYHA-klasse I eller II.
3. Pasienten skal ha en forventet gjenstående levetid betydelig over 18 måneder.
4. Ved progresjon til vedvarende (minst 6 måneder) NYHA-klasse III, skal beslutning om å fortsette behandlingen tas i samråd med kardiolog med erfaring i behandling av ATTR, ansatt ved universitetssykehus eller annet helseforetak med kardiologisk enhet med kompetanse på behandling for denne pasientgruppen.
5. Ved rask progresjon til vedvarende NYHA-klasse III i løpet av 6 måneder etter initiert behandling, bør behandlingen avsluttes.
▼Vyndaqel® (tafamidis) 61 mg er indisert til behandling av villtype eller arvelig transtyretin amyloid kardiomyopati (ATTR-CM). Anbefalt dosering er 1 kapsel 1 gang daglig. Forsiktighet anbefales ved alvorlig nedsatt leverfunksjon. Kan gi interaksjoner ved klinisk relevante konsentrasjoner med BCRP-substrater. Bivirkninger: Flatulens og økte leverfunksjonsverdier ble sett, men årsakssammenheng er ikke fastslått. Pris: Det er fremforhandlet en konfidensiell, kostnadseffektiv pris til norske helseforetak og enkelte private sykehus som er betydelig lavere enn maksimal utsalgspris i apotek kr 195058,40.

Pakning: Myke kapsler, 30 stk., Reseptgruppe: C
Refusjon: H-resept. ICD10: E85
Før forskrivning, konsulter preparatomtalen på www.legemiddelsok.no
www.estimattr.no

wtATTR-CM estimATTR
bruker en algoritme skapt med kunstig intelligens-/ maskinlæring for å estimere sannsynligheten for wtATTR-CM hos hypotetiske hjertesviktpasienter.
Med tre enkle trinn:
Besøk www.estimattr.no for å lære om kombinasjoner av kliniske tilstander som er assosiert med wtATTR-CM.
▼Vyndaqel® (tafamidis) 61 mg er indisert til behandling av villtype eller arvelig transtyretin amyloid kardiomyopati (ATTR-CM). Anbefalt dosering er 1 kapsel 1 gang daglig. Forsiktighet anbefales ved alvorlig nedsatt leverfunksjon. Kan gi interaksjoner ved klinisk relevante konsentrasjoner med BCRP-substrater. Bivirkninger: Flatulens og økte leverfunksjonsverdier ble sett, men årsakssammenheng er ikke fastslått. Pris: Det er fremforhandlet en konfidensiell, kostnadseffektiv pris til norske helseforetak og enkelte private sykehus som er betydelig lavere enn maksimal utsalgspris i apotek kr 195058,40.
Pakning: Myke kapsler, 30 stk., Reseptgruppe: C.
Refusjon: H-resept. ICD10: E85
Januar 2023 PP-VYN-NOR-0285
